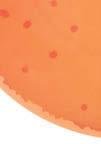

the Ultimate Guide to... GETTING ON THE LADDER, THE PROPERTY MARKET AND HELP TO BUY rsttimebuyermag.com June/July 2023 £3.95 771758 973014 9 06> “Don’t get pressurised and ensure you understand the process” THE LOWDOWN ON AFFORDABLE WAYS TO GET ON THE LADDER OUTDOOR LIVING AT ITS BEST WIN! A PROOFVISION IN-WALL SINGLE TOOTHBRUSH CHARGER WORTH £56.90 IMPORTANT QUESTIONS TO ASK A CONVEYANCER SPOTLIGHT ON YOUR CREDIT SCORE
Bowen TV Personality & In uencer
Olivia

EDITORIAL – 020 3488 7754
Editor-in-Chief SARAH GARRETT sarahg@spmgroup.co.uk
Editor LYNDA CLARK lynda@ rsttimebuyermag.co.uk
Editorial Assistant and Head of Special Events


KATIE WRIGHT
Editorial and Special Events Assistant
SOPHIE MUNNERY
Creative Director RYAN BEAL
Sub Editor KAY HILL

Social Media KATIE WRIGHT, SOPHIE MUNNERY
Contributors
CHRIS CLARK, DEBBIE CLARK, BILL DHARIWAL, JULIANA GOODE, KAY HILL, DUNCAN HORTON, JONNIE IRWIN, JAMES JONES, CECILIA MOURAIN, SOPHIE MUNNERY, LAURA DEANOSGOOD, CORALIE PHELAN, LESLEY PRICE, GINETTA VEDRICKAS, KATIE WRIGHT
ADVERTISING – 020 3488 7754
Director of Advertising/Exhibition Sales

LYNDA CLARK lynda@ rsttimebuyermag.co.uk
Special Events KATIE WRIGHT
– First Time Buyer Home Show
– First Time Buyer Readers’ Awards katie@ rsttimebuyermag.co.uk

Accounts accounts@ultimateguidecompany.com




Managing Director SARAH GARRETT sarahg@spmgroup.co.uk
Public Relations
RACHEL COLGAN rachel@buildingrelations.co.uk
SUBSCRIPTIONS
020 3488 7754
SWITCHBOARD
020 3488 7754
All advertising copy for August/September 2023 must be received before 30 June 2023. Send all copy to: lynda @ firsttimebuyermag.co.uk
The content of this publication, either in whole or in part, may not be reproduced, stored
Welcome
We are very excited that after much deliberation our expert panel of judges has decided on the shortlist for our FTB Readers’ Awards 2023. You will find the shortlist entries on pages 77-99 but it is now up to you, our readers, to vote – please take a moment to go to ftbawards.com and cast your allimportant votes – thank you.


The weather has been a little unstable but I am hopeful it will settle down and we can spend some time to enjoy the great outdoors! We have some inspirational accessories on pages 12-13 to help you relish the sunny days ahead.
Many first time buyers do not realise that having a good credit score is vital when the time comes to get a mortgage. On pages 112-113 we explain what the credit score is all about and how important it is on your homebuying journey.
Now that the Government scheme Help to Buy has closed, shared ownership is a very affordable way of getting on the ladder. On pages 24-31 we explain how shared ownership works and also highlight some other schemes available to help you buy your first home.
I hope you enjoy this issue which is packed with information and if you are struggling to understand how it all works then I am sure you will find the answers to your questions inside.
Until next time, happy house hunting
Esaiyas Mollallegn, 20 Questions, page 134
Flo Headlam, At home with, page14
If you’re planning to apply for a mortgage, it’s important to check your credit report.
James Jones, Don’t let a poor credit score turn your mortgage dreams into a nightmare, page 112
EDITOR’S LETTER First Time Buyer June/July 2023 3
This is what we really wanted to nd: a perfect balance between city and country. Kate Rowe, House Hunter, page 16
in a data retrieval system or transmitted in any form or by any means, electronic, mechanical, photocopying or otherwise, without prior permission from the publishers. Opinions expressed in First Time Buyer magazine are not necessarily those of the publishers. © The Ultimate Guide Company Ltd 2008-2023. The Ultimate Guide Company Ltd t/a First Time Buyer magazine will take no responsibility for any loss/ claim resulting from a transaction with one of our advertisers/media partners.
firsttimebuyeronline @firsttimebuyer
EDITOR’S PICKS…
When you’re a rst time buyer it can feel like a mine eld, so take some time and really do the research.
If you don’t get good vibes about an area there’s no point thinking of living there.
It hasn’t really hit me that it’s ours yet. This is actually our home, and we own it.
Raymond Wardle and Mark Wardle, Real Life, page 70
What’s in…
71
For sale
– the best FTB properties

70
Raymond and Mark Wardle had been living abroad for years, travelling around the Middle East. When they came back for a short holiday in England, they ended up stuck in the country as the Covid lockdown hit the UK. Unable to travel and trapped living in a friend’s spare room, Raymond and Mark decided they needed to find a permanent place of their own and bought a three bedroom house in East Sussex, which they are thoroughly enjoying.

HOMEPAGE
9 Words from Jonnie TV presenter and property expert, Jonnie Irwin gives his views on the housing market.
10 FTB loves…
Storage is so important! Our round up of some of the best practical products to help maximise your space and clear away the clutter.
12 Living Summer-inspired accessories to help you make the most of the warm days ahead.

14 At home with…
Flo Headlam
Having changed careers after working in the charity sector for 25 years, Flo studied horticulture and joined the presenting team on BBC Gardeners World and is also on her third series of Garden Rescue for BBC1. She talks to Lynda Clark about her first home, her interesting career and has some very good advice for first time buyers.
16 House Hunter
We try to find a home for Kate and Richard Rowe who are searching for a two bedroom house in the North West.
18 Developer’s doctor Louise Mills, Sales and Marketing Director at St Arthur Homes, answers your property questions.
FEATURED
20 The View: Olivia Bowen
Olivia Bowen, then Buckland, came second on Love Island with Alex Bowen and they were the first couple to get married after the show. She has over three million followers on Instagram and keeps them updated @thebowenhome. Olivia is passionate about property and interiors. She has recently renovated her own home using
Frenchic paint throughout, and was so impressed that she has become an ambassador for the Frenchic paint brand.
24 Buy and Save
Debbie Clark examines the figures and considers some of the best schemes available to help first time buyers get a foot on the ladder. We also highlight some affordable homes using the schemes to enable you to buy your dream home.


CONTENTS 4 First Time Buyer June/July 2023 JUNE/JULY 2023 / ISSUE 101 / FIRSTTIMEBUYERMAG.CO.UK
Cover Photo © james@jamesrudland.com
24 12
OLIVIA BOWEN, PAGE 20 20
Olivia Bowen

101 Competition
Seven lucky winners will win a ProofVision In-Wall single toothbrush charger (with a choice of faceplate finish) worth £56.90
REGULARS
36 Hotspot
We look at Greenwich as a place to live.
102 First home, first meal
Transform classic French ratatouille into a simple savoury tart for only 91p per serving! From Tesco Real Food, this vegan and dairy-free recipe is ideal for a stress-free midweek dinner.

additional costs
Cecilia Mourain, Managing Director at Moneybox looks at the statistics.
114 Finance
Many first time buyers receive financial help from family – but there are many different forms that this can take. Kay Hill looks at the various possibilities.
116 Market
With reports of worldwide recession making an impact, are British property prices set to fall this year or will more local issues affect the market? Ginetta Vedrickas assesses the situation.
118 Agony Agent
All your property questions answered by our panel of experts.
121 Buyer’s Guide
103 Know How
Simple but very necessary cleaning hacks to add a real sparkle to your new home.

106 Making sense of conveyancing quotes –what first time buyers need to look out for!
Bill Dhariwal, Director and Solicitor, and Duncan Horton, Shared Ownership Manager, at Lawcomm Solicitors look at the questions first time buyers need to ask a conveyancer before they start on the conveyancing process.
110 Third of first time buyers hope to buy within a year but most have yet to seek broker advice, fearing

Check out FTB’s Buyer’s Guide, which walks you through the property buying process.
126 Common questions from a first time buyer about conveyancing?
Coralie Phelan, Partner and Head of New Build Homes at Prince Evans Solicitors LLP, looks at what common questions first time buyers should ask their conveyancer.
128 Directory
A round-up of which schemes are available to first time buyers.
134 20 Questions
We ask 20 quick-fire questions to Esaiyas Mollallegn, Head of Marketing at SO Resi, who is in the spotlight this month.
CONTENTS First Time Buyer June/July 2023 5
TAKE YOUR TIME AND SEE AT LEAST FOUR OR FIVE OTHER PROPERTIES SO YOU CAN DO A COMPARISON AS YOU NEVER KNOW WHAT YOU MIGHT FIND IF YOU RUSH INTO THE FIRST PROPERTY YOU SEE
77 First Time Buyer Readers’ Awards –time to vote!

Mailbox
NO CREDIT SCORE
I have never had a credit card and don’t currently have a credit score. Is it possible to get my first mortgage without one?
 Ella Stewart
Ella Stewart
FTB says: Getting a mortgage with no credit history or score can be challenging, but it is not impossible. A credit score is a crucial factor in determining your creditworthiness, and most lenders use it to assess the risk of lending you money, so you may have a harder time convincing lenders that you are a reliable borrower. There is likely to be limited lenders and it is possible that mortgage rates will generally be higher than those with a good credit history so it’s worthwhile as a minimum to register yourself on the voters roll at your current address. It’s essential to do your research, and to save you time and possibly money to work with a specialist mortgage broker that can access all lenders, some not available on the high street, which only offer mortgages through brokers to increase your chances of gaining approval.
Add a splash of colour to your baking days or picnics this summer with this issue’s star letter prize. These oral tins from Lakeland’s beautiful Summer Meadow range, worth £29.99, are designed to t different cake sizes and because they nest you can easily store them away when you’re not using them!



lakeland.com
COMMUNAL AREAS
I see that all the flats that I have been looking at as potential first properties for myself and my partner all have communal areas. Whose job is it to look after these areas and ensure their upkeep?
Caroline Coutts
FTB says: The responsibility for looking after communal areas in flats typically lies with the property management company or the residents’ association, depending on the type of ownership and management structure in place. If the flats are owned on a leasehold basis,
the management of the communal areas is usually the responsibility of the freeholder, who may appoint a property management company to carry out this function. The costs of maintaining the communal areas are typically split between the leaseholders, who are usually required to pay a service charge. In some cases, residents may set up a residents’ association to manage the communal areas themselves, although this is less common. It is important to check the terms of your lease or ownership documents to determine who is responsible in your specific case.
WRITE TO US!
Please send us your questions, comments and suggestions concerning property, or the articles in First Time Buyer magazine.
lynda@ rsttimebuyermag.co.uk
ENERGY SAVING TIPS
I am just about to buy my first home. With energy prices being very expensive at the moment, are there any tips on keeping energy bills down to a minimum in my new home?
Fleur Ramsey
FTB says: As a first time homebuyer, there are many ways to save energy and reduce your utility bills. Here are some tips: Insulation can help keep your home warm in the winter and cool in the summer. Consider insulating walls, roof, and floors to reduce heat loss if they aren’t already.
LED light bulbs use up to 80% less energy than traditional incandescent bulbs and last up to 25 times longer.

A programmable thermostat can save energy by automatically adjusting the temperature in your home based on your schedule. Set it to lower the temperature at night and when you’re away.
The Energy Star label marks appliances that are more energyefficient and can save you money on your energy bills.
Natural light is free, so open blinds and curtains in the day!
NEW BUILD SNAGS
I am about to move into my first property, which is a new build, and have had a look around to do some measurements and noticed a few issues that need rectifying. How should I go about this and does the builder have to repair them?
Andrew Rathburn
FTB says: Snags are issues that arise in a new build, and it is important to address them as soon as possible. The first step is to compile a list of snags and report them to the developer or builder responsible for the property. They should rectify any issues that fall under
the terms of the warranty or guarantee. It’s important to document everything, take pictures, and keep a record of all communication. Always conduct a thorough inspection of the property before completing the purchase to ensure all snags have been addressed. If the builder or developer does not rectify them or is unresponsive, seek advice from a professional such as a surveyor, architect or solicitor.
VISIT OUR WEBSITE
For everything you need to know about buying for the rst time, go to rsttimebuyermag.com
LETTERS First Time Buyer June/July 2023 7

WORLD
I was travelling on location with a director who had a father who was pretty well known in the 80s – he played Simon Templar in The Saint and his character was a super slick crime/ problem-solver – a bit like a private James Bond (who his predecessor in that role, Roger Moore, went on to play). I remember being invited to join the video call and asked him what he was doing these days.
He told me that since that series, work had thinned in the UK, so he went over to the US where he got lots of roles – mainly as a bad guy. It occurred to me that many film characters I had seen in the 80s and 90s were quite cliched – well-spoken, handsome and had a very correct English accent. Back then you knew where you were with bad guys and you were supposed to dislike them immediately and looked forward to their downfall.

Then came the modern crime series. The good guys are often flawed heroes and the bad guys are sometimes unlucky and chose the wrong path or they were born into a life of crime. Series like The Wire (best series of all time in my honest opinion) have you really sympathising with the bad guys or Sopranos where the hero is a murderous gang Godfather. Your moral compass is spinning!
Finally, our series and film makers are telling us that good and bad isn’t an arbitrary subject. Now don’t scoff, but the world of property has its own good and bad guys in the form of landlords and tenants. You might scoff, but I’m so tired of the narrative the popular press rolls out about rogue landlords and property developers, without which countless people would simply be homeless.
Of course there are dodgy landlords but there are tenants who also abuse the properties and rules. Many landlords are private individuals hoping to build something for a pension. I have been one of those people and had the policy that if I provided accommodation to a standard I’d be happy to live in, that it would attract a better tenant. I didn’t want to

overcharge, I’d rather have continuity and long term tenants.
Just the other day I was asked for my opinion on a buy-to-let that had come on the market. It was cheap and had an HMO (house of multiple occupation) licence. When I looked around I could see why the asking price was so reasonable and the rent achieved was so low. The property needed a new roof and was already causing damp in some of the rooms, one of which was empty as the damp was so bad – not a great example of responsible property ownership.
I told my client she had two options – patch and repair and collect the same rent or wait until the end of the lease and spend proper money and replace the roof and at the same time refurb the entire flat bringing the forth bedroom back on line. I recommended option two. Initially it effects the yield due to the extra financial outlay but over time the increase in rent from the fourth bedroom would pay for itself.
From a landlord’s perspective they had the peace of mind that their investment had a new roof, and with the guarantees that come with the work should have fewer issues with associated problems. To refurb the place at the same time will mean that by the time the property comes back to the market it will be at an ideal time and the rent can reflect the higher spec property at proper market value. A property in better shape should attract tenants who respect their home and therefore the landlord’s investment. Of course there’s always the risk of getting a bad tenant, but that’s reflected in the return.
You’ll be pleased to hear she chose option two – so hopefully they’ll be happy tenants moving into a refurbed home in the summer. Good guys on both sides!
OPINION First Time Buyer June/July 2023 9
TV presenter and property expert Jonnie Irwin gives his thoughts and views on first time buyers and the housing market
Say goodbye to the circus!

There are lots of things to consider when buying your first home; location, transport, are you going to be close to family and friends? Often an afterthought when you settle into your first home is lack of storage. What do you do with all this stuff? Make sure lack of storage is only relevant to your inbox and not your home with these practical products that will help maximise space while not looking like an eyesore!






































I’m a sucker for you






























If you have a little animal lover on your hands, they’ll go wild for this woven storage with in-built shelves. It can be used to store all kinds of treasures. Use the larger shelves to stack books and the cubby holes for favourite toys.

Elephant shelf, £28, primark.com
Obonas wall shelf with suction cup, £5, Obonas triple hook with suction cup, £2.50, Obonas container with suction cup, £3, ikea.com









ÖBONÄS wall organisers offer drill-free storage with the magic of concealed suction cups. The simple design will tidy up your shower tray in no time.






Are you ready? LEGO!













LEGO toy storage box, £12.99, tkmaxx.com
Just like the original LEGO bricks. Perfect to decorate, play, build and have fun or keep toys sorted using them as storage boxes.
Wake up and smell the roses
Flower storage, £5, primark.com
Add a pop of colour on the wall with this fun storage box. A great place to put all those tiny trinkets.



Don’t get your knickers in a twist!


Homelife pack of 2 drawer organisers, £8, studio.co.uk



An ef cient way to keep your drawers neat and tidy. Ideal for everyone, helping to store anything you choose in an orderly fashion.

FTB LOVES 10 First Time Buyer June/July 2023
That’s














Keep those half-used wrapping paper rolls concealed and stored away from sight with this handy storage tube.



a wrap Gift wrap storage tube, £7.99, therange.co.uk






















Divide and conquer
Skadis free-standing pegboard, £17, ikea.com
You can store things on both sides of this clever pegboard when you use it as a divider on a table or desk. Choose your own accessorises to add to the board to suit what you need!

Hole in one
Skadis pegboard combination, £19.75, ikea.com








A great way to make it easy to organise all the rooms of the home and quickly nd what you need.










I only have my shelf to blame
Three tier shelf cupboard organisers, £4.49, therange.co.uk






























Found a can that expired in 2012?! Then you need this cupboard organiser which enables you to see what you can have for dinner tonight!
Save your sole!







Extendable and stackable shoe rack, £26.99, lakeland.co.uk

The perfect shoe rack to expand with your shoe collection.
A touch of glam
You’ll be blown away


Norberg drop leaf table, £45, ikea.com

Storage bench, £99, tkmaxx.com
A storage box with a velvet nish to add a touch of glam to the bedroom and hide away all the mess.


This is a great space saver! You save space when the table is not being used as it can be easily folded away.


FTB LOVES First Time Buyer June/July 2023 11
LET THE SUN SHINE!













































































We don’t know about you, but this has had to be the longest winter of all time! Finally, the evenings are longer, the sun is making an appearance, things are heating up and we couldn’t be happier! We have put together a collection of summer-inspired accessories perfect for the new season

























































Homepage LIVING 12 First Time Buyer June/July 2023
Camping cooler tub, £30, Dunelm
Grow table, £44.99, Dobbies
Glass plant mister, £4, B&M
Picnic blanket, £7.99, Homesense
Chip & dip board, £12, B&M
Planter, £3, B&M
Jug, £8, B&M
Glasses, from £1.50; chip & dip bowl, £12; woven cushions, £10 each; plant mister, £4; candle, £4; candle with rope handle, £12; string lights, £12; planters, from £10; colourful shower resistant cushions, from £10; terracotta planter, £8, B&M
Sun ower wreath, £34.99, Lights4fun
Strawberry plate, £2; drinks dispenser, £8; wine glass, £2, B&M

Seat pads , £8, B&M
Beach chair, £29.99, Dobbies






Lemon and orange plate, £2.50 each, B&M





Flamingo jug, £18; set of 2 bowls; £18; set of 4 wine glasses; £18; set of 4 tumblers; £16; set of 4 plastic tumblers; £16; serving tray, £18, Next






Watermelon dish,




































Cooler bag, £14, B&M

Tumblers with straws, pack of 8, £3.50, B&M







CONTACTS




» B&M bmstores.co.uk » Dobbies dobbies.com » Dunelm dunelm.com































» Homesense homesense.com » Lights4fun lights4fun.co.uk
» Next next.co.uk » TK Maxx tkmaxx.com




































































Homepage LIVING First Time Buyer June/July 2023 13
£9.99, TK Maxx
Plate, £1,50; tumbler, £2, B&M
Tumblers, £5.99, TK Maxx
At home with: Flo Headlam






Flo Headlam changed careers after working in the charity sector for 25 years to become a horticulturist. While continuing her horticulture studies at Capel Manor College, London, the opportunity came along to join the presentation team on BBC Gardeners’ World. She was one of the presenters for three years and is now filming her third series of Garden Rescue for BBC1. Flo is also joining the new team of gardening presenters on QVC. She talks to Lynda Clark about her first home, her fascinating career and has some good advice for first time buyers
FTB Tell us about your first step on the property ladder?



FH: It was in 1991 and I bought a lovely top floor flat in a fourstorey Victorian house with my boyfriend at the time. It had wonderful dormer windows and as we were so high up it felt like a real rooftop retreat. Unusually, it had a sunken bathroom and there were many comedy moments when we had to warn visitors about it otherwise they would’ve fallen into the bath! We did lots of decorating and weren’t afraid of using colour! We had deep green in the sitting room, a bright yellow kitchen, lavender in the bathroom with black and white tiles – it was vibrant and energetic; a great first home. We stayed there for around 10 years and then bought an Edwardian house. It was an interesting layout as the kitchen/diner was downstairs with a utility room and an old coal chute which served as extra storage. The ground floor consisted of a double reception room and a smaller room, which the previous owners used as a fourth bedroom. We converted it into a study/music room. The bathroom and bedrooms were upstairs, so from cooker to shower involved two sets of stairs. It kept me fit! Again, we used lots of colour – we had lilac on the walls and terracotta on the chimney breasts in the through lounge. The hallway was painted white, with chocolate brown skirting and the dado rail was mint green. I remember watching a movie and in one scene, set in a New York apartment, they’d used similar colours. At the time the combination resonated with me, and I reached into that memory and employed those colours. It looked great and really inspired me to be brave with colour.
FTB: Where do you live now?
FH: I live in a 1930s semi-detached house with my two teenage daughters. It is small but perfectly formed, as I like to think of it. But I had to do quite a bit of work to it when we moved in – a complete rewiring, new boiler and radiators, and I completely reconfigured the bathroom, taking out the oversized bath and putting in a generous D-shaped shower. It is west facing so gets a lot of light. The plants love it there!
FTB: Tell us about your career?

FH: I worked for 25 years in the charity sector and for 14 of those years I worked for Comic Relief. It was a great job and I loved it, but I came to a point, after returning from my second maternity leave, when








Homepage LIVING 14 First Time Buyer June/July 2023
“GET TO KNOW THE AREA YOU ARE INTERESTED IN BUYING IN AND DO LOTS OF RESEARCH. IT’S IMPORTANT TO CHECK OUT THE LOCAL COMMUNITY TO SEE IF YOU CAN PICTURE YOURSELF THERE”
I realised I needed to do something completely different. I was lucky that they paid for me to see a life coach and as part of the conversation I was asked to write down everything I’d like to do with my life, money being no object. It was a great surprise when landscaping and grow your own came in my top five. Then I realised that subconsciously I had been going around redesigning people’s front gardens. The penny dropped. I realised that this was something I actually wanted to do. And the stars aligned. I was talking to a friend who had just completed their Level 1 Horticultural City and Guilds qualification at Capel College in Crystal Palace and suggested it might be a route for me. I searched online and found that the one day a week course was running on one of my days off (I was working part time at the time). I signed up and that was the beginning of my journey. Five years later I completed my Diploma in Garden Design at Capel Manor. I absolutely love my job. I bring all the skills I’ve acquired from my previous jobs into what I do now. Most of all I love the creativity and physicality.
FTB: How did your TV career start and what are you working on currently?
FH: It was sheer chance that I got the opportunity to work on television. I was at a professional plant nursery in Kent and ran into Danny Clarke, the Black Gardener, a professional gardener and television gardening presenter. He was with one of the producers of Gardeners’ World. Danny and I just clicked, chatting and connecting. We stayed in touch. Then about six months later, Gardeners’ World was expanding its presenting team and remembered me as they were keen to get more women presenters on the show. They got in touch with Danny who contacted me and the rest, as they say, is history. I got the job! I was part of the presentation team for three years from 2017-2019, during which time I had the pleasure of travelling around the country and meeting incredible individuals, all united in their love of growing. They let me go just before we went into lockdown in 2020. I was actually working quite a lot during lockdown, not really thinking about the next TV adventure when Spungold TV came knocking and offered me the opportunity to join the Garden Rescue team. I am now filming my third series and loving it. I call it my best day at work. I see my design come to life in a matter of days. Telly magic! I love the challenge of each new brief and the chance to push the envelope with my designs. It’s a balance of giving people what they want, what they didn’t know they wanted and making the garden exciting and intriguing. It really does make peoples’ dreams come true and

I love going on that journey with them, making an impact.
FTB: Do you still work with any private clients?
FH: Oh yes, I have a portfolio of private clients I look after, working in London and the South East. This is both design work and some ongoing development in private domestic gardens. I am involved in a few community gardening projects, and support a number of organisations with their campaigning, in particular The Climate Coalition, as a supporter for its Great Big Green Week annual campaign. Having worked in the education team at Comic Relief, I also like to give back to education. I am involved with a couple of organisations that take role models into schools to talk about careers and inspire students to think about working in horticulture. I am an Equity
Ambassador for BALI [British Association of Landscape Industries] and an ambassador for The Great British Garden Festival. I have a lot energy and like to be busy and these roles are very important to me.
FTB: What advice do you have for first time buyers?
FH: Get to know the area you are interested in buying in and do lots of research. Visit at different times of the day to see what is going on and what facilities the area has to offer. Check out the green spaces, shops, cafes and get a feel for the place. It’s important to check out the local community to see if you can picture yourself there. If you don’t get good vibes about an area there’s no point thinking of living there. Transport is key. Even if you have a car, bus and train links are important.
floheadlamgardens.com
Homepage LIVING First Time Buyer June/July 2023 15
“I LOVE THE CHALLENGE OF EACH NEW BRIEF AND THE CHANCE TO PUSH THE ENVELOPE WITH MY DESIGNS”
The HOUSE HUNTER
This month FTB goes on the hunt with Kate and Rich Rowe who are returning to the North to find a family friendly home
What we found…
THE TOWN LIFE THE CITY CONNECTIONS
The Gateway Ascots Green, Manchester
Oakwood Fields Warrington, Cheshire
Names Kate Rowe, 36, and Richard Rowe, 38

Occupations PR manager, IT consultant








Maximum budget £300,000
Requirements A house with two or more bedrooms with a semi-rural feel, good access to local amenities and links to a city or a large town. Room to start a family and have friends to stay is a must
What they wanted…
Myself and my new wife Kate have decided to make a big, bold move and shift our lives back up to the North of the country after years of living in the South West. We’ve rented in Bristol for several years – it’s how we met – but after getting married and changing jobs, we’ve decided to make the move. Kate is originally from Shef eld, while I have family in Manchester and Lancaster. We’re quite open to where we move to – it’s about the lifestyle for us. We want to nd a family friendly place to have children, with lots of space, some nice countryside, pretty villages and a slower pace of life. Both of us work mostly remote, only having to visit of ces in London and Bristol once a month or so, which gives us quite a lot of freedom when it comes to location. We have saved for several years and have a deposit of £30,000 and a budget of £300,000.”
Located on the edge of lively Ancoats, these homes are around a 15-minute walk from the bustling city centre. The new properties here range from contemporary two bedroom apartments to three and four bedroom houses. The houses feature spacious living areas that open to back gardens, plenty of storage and exible spaces. Inside, there are high-quality features throughout, including a rain shower in the bathroom, granite work surfaces in the kitchen and natural stone ooring. The locality has shops and entertainment, while the Northern Quarter is an easy walk.


lovell.co.uk

Set on the edge of open countryside, close to Pennington Flash, this new collection of homes enjoys a semi-rural location, yet with great links to Liverpool and Manchester. For commuters, the development enjoys great road and rail links, while nearby Wigan and Warrington offer shops and leisure facilities. There are just over 100 new three and four bedroom properties here, ideal for growing families, with large living spaces, downstairs WC and en suite from the main bedroom. Outside, the development has communal play areas and parkland.


redrow.co.uk




What they thought…
Manchester is a wonderful and diverse city and we’ve loved it whenever we’ve visited family here. It has de nitely been at the top of our list when we’ve been speaking about moving back to the North. We really love the city, and this location is great for enjoying everything that’s on offer. The homes seem ideal for raising a family, with lots of space and a great garden. It may be a bit more lively than we’re looking for at the moment, but it’s still an excellent option.”
We absolutely love the style of these properties – they remind us of some of the beautiful period homes that we’ve always dreamed of. The design is just lovely – and we can really imagine using the great spaces and making one of these our forever home. Location-wise, it’s pretty good for enjoying two amazing cities, while also getting out and about in the fresh air and some amazing rural surrounds. Having an option like this is pretty exciting to us!”
16 First Time Buyer June/July 2023 Homepage FIRST RUNG
PROFILE
FROM £294,950 FROM £349,995
THE COASTAL CHARMERTHE HISTORIC SETTING
First choice!
Mill Green Warton, Preston Mabel Gardens Lancaster, Lancashire
FROM



The coastal village of Warton is home to this collection of homes offering a great lifestyle for families. The new three and four bedroom houses are on the Fylde Peninsula, close to the popular town of Lytham, with easy access to the coast at Morecambe Bay and Ribble Estuary. Warton is a traditional village with independent shops and pubs, with highly regarded schools within a short drive. The three bedroom homes are arranged over three oors, with a main bedroom with en suite and dressing room on the top oor and exible living spaces.
anwylhomes.co.uk






We’ve always loved the coast and you get your fair share of it here, with options for outdoorsy activities and making the most of the coastline and countryside. Preston is a short drive away if you’re missing the hustle and bustle, plus Blackpool is within easy reach too. There is a good range of property styles on offer here – we particularly like the larger homes with the integral garages. I’ve always dreamed of having that extra garage space and a bit of a workshop.”





This collection of two and three bedroom properties sits just outside Lancaster city centre, close to a great range of facilities, schools and green spaces. The city, known for its medieval castle and food and entertainment scene, was recently named as one of the best places to live in the North. The homes are thoughtfully designed, with separate living and dining rooms downstairs, a ground oor WC, and three well-sized bedrooms upstairs. Travel into the city centre takes as little as ve minutes by car, while the Morecombe coastline can be reached in under 10 minutes.
plumlife.co.uk
THE PERFECT BALANCE

 Rowe Gardens Catcliffe, Rotherham
Rowe Gardens Catcliffe, Rotherham
What a fabulous location – so close to lovely Lancaster and the amazing coast at Morecombe Bay. The Lake District is also easy to reach by car from here, and we’d have endless options for day trips or weekends away. This is a lovely part of the country and a far cry from our current lifestyle, which is exciting. We like the properties – the layouts offer so much space and we like the separate living and dining rooms. It would be nice to have a garden after years in a at.”
Just 15 minutes from the centre of Shef eld, yet with beautiful countryside on the doorstep, the homes at Rowe Gardens offer a perfect balance of lifestyles. There are two, three and four bedroom homes available in a range of styles, including semi-detached and detached houses. Inside, the homes have bright living spaces, downstairs WC, and en suite bathrooms in larger properties. All have a rear garden and parking or a driveway. This is a fantastic location, with the pretty village of Catcliffe and local amenities on the doorstep, and Shef eld is an easy car or bus ride away.
plumlife.co.uk
“We have spent some long weekends exploring different areas to get an idea of where we’d like to move to. We’ll now be spending lots of time in and around Catcliffe and Shef eld to get a proper feel of what living here can be like. We have our mortgage offer agreed in principle so we’re ready to go as soon as possible.”
This is what we really wanted to nd: a perfect balance between city and country. These new homes are ideally located for that. We really want to embrace a different lifestyle to our current city centre life and enjoy all that a rural area can offer – but we still don’t want to be too far from it all, so this is ideal. Shef eld is a great place – Kate grew up nearby and she still has some friends and family here, so that’s a de nite plus for us. There’s plenty of shops and amenities in the area, with some beautiful rolling hills within a short drive. Rotherham is also easy to get to, which is a huge bonus. Of course, the properties are really attractive too – we particularly like the three-storey townhouses.”
Homepage FIRST RUNG First Time Buyer June/July 2023 17
*Based on a 25% share of the full market value of £220,000
*Based on a 25% share of the full market value of £235,000
£234,995
FROM £58,750* FROM £55,000*
THE NEXT STEP
Louise Mills is Sales and Marketing Director of shared ownership housing provider St Arthur Homes, which currently has developments across the South and South East of England, with plans to expand into the Midlands. Bringing a fresh approach to the affordable housing market, Louise and the rest of the St Arthur team believe in providing high-quality homes in desirable locations, while passionately expounding on the many benefits for buyers of choosing this route into homeownership

QI am a first time buyer and I am looking at the various ways of getting on the ladder and I have a couple of questions, as I am getting a little confused. In the last year there has been a 36% increase in affordable housing sales. Why do you think that is?
AWe’ve certainly seen that jump reflected in our visitor and buyer numbers, and I believe there’s a few different reasons for that. Firstly, with Help to Buy ending, first time buyers have had to look at a different way of getting on to the property ladder, and shared ownership has proven ideal for many of them.

Buyers can also choose to embark on a process which we call “staircasing” – which means that initially they buy a percentage of their home and pay rent on the rest of it, then they can choose to buy further percentages of that property as and when they can, building up to 100% ownership if they wish.

Also, with the cost-of-living crisis and house prices being what they are, shared ownership gives hard-working professionals the chance to be a homeowner much sooner, and often for less money, than the other options. It just makes sense.
QWhat do you think is the biggest appeal of a new build home, from a buyer’s point of view?




AThere are so many aspects of a new build that make it more appealing to many people than going for an older property. The obvious answer is, of course, the energy efficiency of newer properties. Recent research from the Home Builders Federation shows that buyers of new build properties can save an average of £3,100 on their energy bills each year – a significant amount!

Then, of course, there’s the fact that, with a new home you aren’t having to fix the mistakes of past homeowners, deal with dodgy decor or rip out old units and appliances. A new build home is a canvas to paint your own life on to.
QThere are many affordable ownership providers around, so what



do you think sets St Arthur Homes apart?




AMany of us at St Arthur Homes come from a background of working at national housebuilders, and we carry a lot of those values with us still. We absolutely believe that a shared ownership home can be an aspirational place to live, and in the current climate they are needed now more than ever. Any stigma that people hold about shared ownership houses dissolves as soon as they look around one of our homes.
We pride ourselves on supporting the





The rst phase of St Arthur Homes’ agship development, Whiteley Meadows, is very nearly sold out, with the next phase set to be released for sale in autumn/winter this year.
Currently, there are a handful of two and three bedroom homes left for sale – with prices currently starting from £141,750 for a 45% share of the two bedroom Hardwick house type.
homebuyer throughout the whole process –from the moment they first contact us, right through to long after they have the keys to their new home.
But we also pride ourselves on the way we work with our partners on-site too. Building relationships with homebuilders is incredibly important, and we strive to be easy to work with, transparent and honest – so that we can continue to work with the very best builders and meet our aims of acquiring 2,000 new homes over the next few years.
Fareham,
Cat Samuels and Tarryn Williams bought a three bedroom property at Whiteley Meadows. They said, “Even though both of us have good jobs, with the current economic climate we knew we’d be looking for a shared ownership property. Without using a scheme like that, we wouldn’t have had a hope of buying our own home for several more years.
“That brought us to St Arthur Homes, which is selling shared ownership properties at Whiteley Meadows, just a few miles away from Fareham. The location was perfect for us and the service was spot on, so we knew we wanted to go for a home here.

“Our sales adviser, Trin, was incredible. No question was too big or small, she guided us through the whole process brilliantly. In fact, everyone we spoke to at St Arthur was lovely. We really wouldn’t hesitate to recommend them to anyone at all.”
through the whole process brilliantly. In fact, everyone we spoke to at St Arthur was lovely. We

When complete, Whiteley Meadows will also include two primary schools, a secondary school and two nurseries, providing an ideal location for families. Handy shops, cute cafes and leading restaurants are also located nearby at Whiteley Shopping, along with a cinema and leisure facilities.
starthurhomes.com















June/July 2023
Whiteley Meadows
*Based on a 45% share with a full market value of £315,000
Louise Mills, Sales & Marketing Director, St Arthur Homes
FROM £141,750*













HAPPY EVER AFTER!

Olivia Bowen, then Buckland, is well known for coming second on Love Island in 2016 with Alex Bowen and they were the first Love Island couple to get married. She has appeared on many TV programmes including This Morning, where she covered for Ferne McCann and Rylan Clark-Neal. Boasting over three million followers on Instagram, she is passionate about property and interiors and has renovated her own home and keeps her followers updated @thebowenhome, where she is also an ambassador for Frenchic Paint. She talks to Lynda Clark about her life and career and has some great advice for first time buyers
Photos © jamesrudland.com

THE VIEW
20 First Time Buyer June/July 2023

THE VIEW First Time Buyer June/July 2023 21
"I JUST LOVE FRENCHIC PAINT AND USED IT IN EVERY ROOM IN THE HOUSE. I LOVE THAT IT IS A BRITISH COMPANY AND IT IS ECO-FRIENDLY AND CERTIFIED SAFE ENOUGH TO PAINT EVEN CHILDREN’S TOYS"

THE VIEW 22 First Time Buyer June/July 2023
"KNUCKLE DOWN ON THE NUMBERS TO MAKE SURE YOU CAN ACTUALLY AFFORD THE HOME"
Olivia is one of the easiest people to chat to – she is warm, friendly and totally charming. She starts the conversation talking about her upbringing. “I have a brother and we had a wonderful childhood. My mum and dad were together until I was 11 and they then split up but it was totally amicable. We went on super holidays, and I was very close to my brother growing up. I did my A-levels and was planning to go to university to study fashion.” Olivia got an unconditional offer but she was then offered a job as a visual designer for American Apparel, which was her dream come true, but sadly the job didn’t quite work out the way she had planned and she decided to leave and get another job. She said, “I found another job in fashion but I really didn’t get along with the managers and I hated being there. I watched the first series of Love Island with my exboyfriend, who I lived with, but it turned out he was a really awful person who eventually cheated on me and we split up.”
After Olivia and her then-boyfriend broke up, she couldn’t go back to live with her mum so she had to rent her first flat on her own. “It was very, very hard and I had no money, so I lived on chicken and rice from a can! It was quite an experience though and because I was young and had so much freedom it really made me grow up! After that I ended up moving in with a friend in Chelmsford and six months later I applied to go on Love Island. I needed a total change and I had to get out of the job I was doing. I was in total shock when I got an interview as it is very rare that anyone actually applies to go on the show as most people are scouted. But to my complete surprise, me and one other guy got on to the show and I was totally amazed.”
While she was on Love Island she met Alex, who later was to become her husband, and they came second in the competition. Three days later, after the end of Love Island, Alex moved into Olivia’s flat. They then rented a house together and bought their first home in 2017, which they lived in for two years until they eventually bought their dream home in the countryside. In the meantime, Alex proposed to Olivia and they got married in 2018 and now have a beautiful little son, Abel.

Olivia says, “ I absolutely love the house we now live in. It was built around 20 years ago and is in the area where I grew up, so it is very special to me and is the best of town and country living. I loved the house and we drove by and I could just imagine us living there. Then it went on the market and our offer was accepted so it was really meant to be. It is a five bedroom house, which had not really been touched and looked very dated. It needed a lot of work but had so much potential.”
They moved in during lockdown and Alex and Olivia had to do a lot of the renovations themselves. Olivia started looking at social media for some inspiration and came across Frenchic paint. She immediately loved the huge range of colours and the endless possibilities it could create and decided to use the paint for her home. “I just love Frenchic paint and used it in every room in the house. I love that it is a British company and it is eco-friendly and certified safe enough to paint even children’s toys. I painted the furniture in Abel’s room, which looks amazing, and it doesn’t bubble or lift, has no nasty painty odours and you can use the paint indoors and outside – it’s so versatile." While they were doing all the renovations, Olivia who studied for an interior design diploma, started an Instagram account, @thebowenhome, documenting all the work they were doing, which has over three million followers and is hugely successful.
She also runs a property business, buying homes and renovating them and then renting them out. “Of course, we use Frenchic paint as it’s brilliant and so easy to use. We have two properties at the moment, but we are looking for another one. I am also going to Paris for work soon, which will be great fun I’m sure and I have my brand work as well. Life is pretty fast-paced especially with Abel running around, but we plan to take some holidays this year to enjoy Abel while he is little and spend time as a family. I also have my horse, Dolly, as I adore riding. When I was little I went horse riding all the time but it became too expensive for my mum, so I worked at the stables to earn my rides but with school and everything it became too much. So, two years ago I decided it was time to start riding again and I got Dolly and ride her as much as I possibly can. We also have two French bulldogs – so life is really hectic!”
With such a busy schedule it’s amazing that she still has any extra time but she is also passionate about fashion and together with Alex they own Exempt Society, a highly successful clothing brand for both women and men.
Olivia has some excellent advice for first time buyers and said, “Live within your means and don’t stretch yourself as you still have to live and pay the bills. I think it’s a good idea to knuckle down on the numbers to make sure you can actually afford the home. Take your time and see at least four or five other properties so you can do a comparison as you never know what you might find if you rush into the first property you see. Finally, don’t get pressurised to complete – just take your time and ensure you understand the process and are completely happy with it.”
Olivia’s passion and enthusiasm is infectious. I will certainly remember our conversation for a long time – she is definitely one to watch!
Follow Olivia’s home renovations on Instagram – @thebowenhome, and find out more about Frenchic at frenchicpaint.co.uk


THE VIEW First Time Buyer June/July 2023 23
Clay Pot, Frenchic
Vintage Rosie, Frenchic
BUY AND SAVE
The average monthly cost of owning a home for first time buyers is now £971 – 4% lower than the cost of renting the equivalent property, according to the latest Halifax Owning vs Renting Review. The analysis, based on housing costs for a three bedroom home, found that owners are paying £971 each month compared to £1,013 for renters. The figures, of course, vary nationally, with the greatest difference in London, where homeowners are paying nearly £3,000 less annually than those renting similar homes. East of England is the only region where it is cheaper to rent. While the gap is down from its peak in 2016, when owners were saving £1,567 annually, these are still significant savings equating to an almost £500 saving per year for the average owner.
First time buyers of new build properties also generally enjoy large savings on their monthly energy bills; particularly pertinent at a time of rising energy costs. The design, insulation and energy-efficient features of new build homes mean those

in a newly built property save as much as £1,200 annually in an apartment and £2,600 annually in a house.
Savings are likely to be even more substantial for first time buyers taking advantage of the Government’s shared ownership scheme. Latimer, the development arm of the not-for-profit Clarion Housing Group, has been crunching the latest rental numbers as part of its "Why rent when you can own" promotion. Based on recent rental price data from Rightmove and Zoopla, the monthly cost of a Latimer shared ownership home is now shown to offer buyers a typical monthly saving of £298 nationally and £250 in London for an equivalent rental property in each development’s local area.
Around 70% of Latimer’s buyers at the start of 2023 were making the move from private rented accommodation into shared ownership, compared to less than 30% of its buyers in 2021; it’s clear that shared ownership offers a highly attractive route into homeownership, and away from the
increasingly expensive rental market. Paul Walker, National Sales Director at Latimer by Clarion Housing Group, comments, “Homebuyers are surprised at how quickly they can get on the housing ladder with shared ownership, as deposit requirements are far more achievable. Many are able to meet the deposit threshold for a shared ownership property in their local area with the equivalent of around two-to-three months’ rent saved as a cash deposit.
"We recognise that may not always be feasible for many renters, but with our latest promotion we encourage those who can save up a small deposit to come and talk to us about the benefits of investing that money into a shared ownership property.”
Share to Buy's website (sharetobuy.com) is a great place to start your search for an affordable home. When you find a home you like, register your interest with the housing provider and arrange a viewing. This is also a good time to enquire as to what schemes and incentives they offer. Help to Buy may have ended, but other
GET ON THE LADDER 24 First Time Buyer June/July 2023
The cost of living continues to rise and, for many, the prospect of homeownership can seem unachievable. However, the latest research shows us that it still pays to buy. Debbie Clark examines the figures and considers some of the best schemes available to help first time buyers get a foot on the ladder
schemes have quickly plugged the gap. Uswitch.com mortgage expert, Kellie Steed, comments, “There are several comparable homeownership schemes in the UK, as well as specialised mortgages that can assist first time buyers or individuals who are unable to qualify for a traditional mortgage.”
When you’ve found a home, and checked you meet any eligibility criteria, you can put down a reservation fee to secure the home and a financial assessment is completed. You will then need to secure your mortgage and instruct a solicitor to handle the conveyancing.
Remember, there are other costs to consider besides the mortgage – make sure you’ve budgeted for those too! It’s recommended to allow £4,000 to cover the associated costs of buying a property; you will need money for solicitor’s fees, moving costs and any broker or mortgage arrangement fees. You may also need to pay Stamp Duty, though most first time buyers will benefit from First Time Buyer Relief, meaning you pay 0% on the first £425,000, and 5% on the remainder (on a property costing up to £625,000).
SHARED OWNERSHIP
Shared ownership is a Government-backed scheme allowing buyers in England to purchase a share of a leasehold home and pay rent on the remaining share. The aim is to make homeownership more affordable for those on lower incomes, or with small deposits. The scheme is available on purpose-built new homes and preloved shared ownership homes, called resales. You will need to meet the eligibility criteria:
9 You must be at least 18 years old
9 Your annual household income must be less than £80,000 (£90,000 in London)
9 You cannot own another home (if you do own another property, you must be in the process of selling it)
9 You should not be able to afford to buy a home suitable for your housing needs on the open market
9 You must show you are not in mortgage or rent arrears
9 You must be able to demonstrate that you have a good credit history (no bad debts or County Court Judgements) and can afford the regular payments and costs involved in buying a home.
Individual housing associations may also have their own additional eligibility criteria, for example that you live or work in a given area.
You will undertake a financial assessment to determine the share you can afford to purchase. This is usually a minimum of 10% and maximum of 75%.
In addition to your mortgage repayments,
Paul, a store manager, has bought his first home as a single buyer after five years of saving, thanks to help from a Government-funded scheme.

Paul attended one of Chestnut Homes’ First Homes Discovery Days and was able to secure his dream home at its Kings Manor development in Coningsby, Lincolnshire, using the new Government First Homes scheme. Chestnut Homes is one of the first housebuilders in Lincolnshire to offer the scheme.
He says, “I’ve been wanting to buy a home for over five years now, but with paying rent on a property at the same time and being a single buyer, I never thought it would be possible.”
Paul adds, “It’s always scary buying your first home, especially when you’re going through the process independently, but the team provided endless support throughout, putting me in contact with financial advisers and local solicitors. From putting down the reservation fee to choosing fixtures and fittings, the service was second to none.”
Reflecting on his journey, Paul says, “It’s taken a lot of hard work and time to get to this position, but I am so happy to be settled into my new home. I hope my story shows that it is possible to get on the property ladder without help or a second income.”
you will pay rent on the remaining share, plus a service charge that pays for the upkeep of communal areas of the building. You can then purchase additional shares as your situation allows, "staircasing" in increments of as little as 1% a year for the first 15 years, and will benefit from a share of any increase in the property’s market value. The housing provider will contribute the first £500 of any repairs or maintenance annually for the first 10 years.
DEPOSIT UNLOCK
Deposit Unlock is a relatively new scheme, developed by the Home Builders Federation (the body that represents housing developers) and reinsurance firm Gallagher Re, designed to "unlock" 95% mortgages for those buying new build homes. Mortgage lenders often set the minimum deposit for new build properties at 15% or even 25% to protect their own interests; with Deposit Unlock the housebuilders pay to insure the mortgages, so lenders are more comfortable offering high LTV mortgages. The property purchased must be your only home and main residence. There are now many housebuilders participating, but some developers do not include studio or one bedroom apartments so you will need to check the terms for each development.
Participating lenders include Newcastle Building Society, Nationwide and Accord Mortgages, with more expected to follow. Like any mortgage, the amount you can borrow will depend on your personal circumstances, but the maximum loan available through the Deposit Unlock scheme is currently £750,000. When an Independent Financial Adviser has qualified you for the scheme, the housebuilder will provide you with written
confirmation so you can apply to specified lenders for a Deposit Unlock mortgage and hopefully reserve your new home.
FIRST HOMES
First Homes is a Government scheme enabling first time buyers in England to purchase a home for 30-50% less than its market value. This can be a new home built by a developer, or a home bought from someone who originally bought it through the scheme.
You will need to meet the eligibility criteria:
9 You must be at least 18 years old
9 You must be a first time buyer
9 You must be able to get a mortgage for at least half the price of the home
9 Your annual household income must be less than £80,000 (£90,000 in London).
The local council may also set some eligibility conditions, for example giving priority to the First Homes scheme to essential workers, people who already live in the area or those on lower incomes (exemptions apply for members of the armed forces and their families).
Homes will be specifically advertised as being part of the First Homes scheme and every home sold is valued by an independent surveyor to make sure the discount is based on its true market value. Homes cannot cost more than £250,000 (£420,000 in London) after the discount has been applied.
To apply, you will need to contact the developer (or estate agent if buying from a previous First Homes buyer) who will help you to complete the application, then send it to the local council. You will pay a fee if buying a new build, which will be refunded if your application is unsuccessful.
GET ON THE LADDER First Time Buyer June/July 2023 25
CASE STUDY
SAVE TO BUY
Fairview New Homes has launched Save to Buy – the only scheme of its kind – to help first time buyers to save for their final deposit via fixed monthly payments while living in their new home, rent free.
Payments are based on the area’s average monthly rent and the buyer’s personal finances, and 100% goes towards the buyer’s deposit and/or affordability deficit on their Fairview home. The maximum term a buyer can use the scheme is two years, but Fairview expects most will complete their home purchase within six to 12 months. Buyers will own 100% of the property, once legally completed.
Chris Hood, Sales and Marketing Director at Fairview, explains why Save to Buy is the perfect solution for many, “Our survey of 1,000 first time buyers found that 79% of renters in the UK and 83% in London feel the cost of renting is negatively impacting their ability to save for a house deposit. In fact, almost two-thirds (64%) blame the cost of rent for saving little or nothing at all towards a house deposit. The Save to Buy scheme is designed to break the vicious rental cycle, which could save first time buyers in London around £15,000 in rental payments over a year.” He believes the Save to Buy scheme could bring forward homeownership for prospective buyers by six years, based on how long it would otherwise take to save a deposit.
Who’s eligible? First time buyers aged 18+, in full-time employment (for a minimum of three months) with minimum savings of 1% of the value of the house they wish to buy. Buyers will need to be qualified by a thirdparty financial adviser to confirm affordability and credit score.
Save to Buy will run until December. Given a record 12-month increase of 16.1% in advertised rental prices in London, the scheme is available on selected Fairview plots in and around London. The scheme will operate on a first-come, first-served basis, and properties are expected to be snapped up quickly. However, plots will be available throughout the year, so if you are interested but not in a position to take part immediately you can be added to a waiting list.
Get in touch with a member of the Fairview Save to Buy team – email sales@fairview.co.uk or call 020 8023 7092. Eligible developments can be found on the Fairview website fairview.co.uk/savetobuy
BUDDY UP INCENTIVE
Fairview New Homes is covering legal advice and fees worth up to £2,000 to empower first time buyers to "Buddy Up" and buy a home with a friend.

Fairview’s national survey of first time buyers revealed that over two thirds (70%) are not able to buy on their own and over half (54%) want to buy their first home with a partner one day. Fairview believes all independent and/or single people are just as entitled to homeownership, and as an incentive to encourage young professionals to purchase their dream home with a friend, are offering those who "Buddy Up" legal fees and expert advice paid up to the value of £2,000, plus a lifestyle gift worth up to £500.
There were many reasons why almost half (43%) of first time buyers said they were unlikely to buy a home with a friend:
9 One in four fear it would risk their friendship
9 24% wouldn’t want to make a long-term commitment with a friend
9 23% do not think it is sensible financially
9 17% do not think it is sensible legally
9 13% say their friends are reluctant
9 12% don’t know how to buy with a friend
Fairview wants to help first time buyers understand the feasibility and benefits of buying with a friend, paired with expert legal advice and first-hand experience. It has teamed up with PCS Legal (Property Lawyers
regulated by the Council for Licensed Conveyancers) to offer expert advice, giving friends the confidence and guidance they need to buy together. Daman Singh, Conveyancing Executive at PCS Legal, says, “Buying with a friend is largely no different to buying with a partner or a family member. We’d always advise parties buying together to get a Trust Deed, also known as a Declaration of Trust, a legally binding document which outlines how much money each person contributed and what happens in various scenarios such as the property being sold or one buying the other out. We advise buyers hold the property as Tenants in Common, so they can detail different shares and enter a Declaration of Trust.”
The Buddy Up incentive is available to friends who purchase a home together with Fairview, and includes a lifestyle gift they can enjoy together to celebrate becoming joint homeowners. Despite the scepticism of some aspiring homeowners over buddying up, friends Dani and Danielle did exactly that and are loving life in their two bedroom flat at the NewHayes development in Hayes.
First time buyer nurse, Dani, who bought with her friend and fashion technician demonstrator Danielle after renting together, says, “I had been renting in London for three years, and I was fed up paying someone else’s mortgage when I could be paying my own. I saved as much as I could, and worked really hard, picking up extra shifts in my role as a nurse throughout the Covid-19 pandemic, but I was still not eligible to buy on my own. Without each other, Danielle and I would not have been able to buy a home by ourselves in London.” She adds, “I had a huge amount of trust in our decision to invest in buying a place together as friends, especially after the legal advice we received which was great, and the whole process was very straightforward.”
Dani hopes to inspire others to purchase a home with a friend, if doing it alone isn’t possible, and has some great tips, “If you cannot afford a property you love and have a very close and reliable friend, buy with them so you can both get out of the renting cycle! If you’re unsure of the process, get trusted legal advice, and have every potentially awkward conversation with your friend in advance, on all of the situations that could play out, to prevent trouble in the future.”
For more information about the Buddy Up scheme visit fairview.co.uk/buying-with-fairview/ways-to-buy/buddy-up/
GET ON THE LADDER 26 First Time Buyer June/July 2023

FIRST HOMES
FROM £250,000
CASE STUDY
Rajeev, 42, his wife Shikha, 42, and their 14-year-old son Kartikeya were keen to set up a permanent base in Chatham, Kent. They had been living in temporary accommodation for six months before moving into a private rented home.

HAYWARDS HEATH, WEST SUSSEX Spring Bank
Sigma Homes’ new development consists of 20 energyefficient homes, two of which will be sold through the First Homes scheme, enabling first time buyers to benefit from a discount of at least 40%. They are now available to reserve off-plan and will be ready in the autumn. The homes will feature EV charging points, contemporary kitchens with Bosch appliances, fitted wardrobes to all bedrooms, and high-quality vinyl and carpeting provided as standard throughout. Mid Sussex District Council has set the eligibility criteria for the First Homes on the development; buyers must have lived in the area for 12 consecutive months, or have a close family member living locally.
sigmahomesgroup.co.uk/developments/west-sussex/ spring-bank

020 3019 0740





LOUGHTON, ESSEX


Epping Gate
Rajeev explains, “We really wanted to buy our own home, but our budget meant we struggled to find anything suitable. During our search we came across Garrison Point, and after researching further, we discovered a new scheme called First Homes which could help us finally buy something. We had a budget of £200,000 which really gave us little option to buy something in Chatham. I work as a Plant Manager in nearby Rochester and my son is settled at secondary school locally, so making a move further afield just wasn’t feasible. The scheme has allowed us to stay in the local area and establish firm roots for our family.
“We’ve been able to purchase a ground floor two bedroom apartment off-plan at Garrison Point, which is ideal for what we need. The development is close to the bus station and in a peaceful location, and the way it has been designed really appealed to us, especially the two bathrooms. We are expecting to move in at the end of the year and it will mean my son will be able to walk to school, which is just 10 minutes away. We will also have our own parking space, which will be such a change from us having to find one at our current rental property.”

FROM £320,000
FIRST HOMES SAVE TO BUY & DEPOSIT UNLOCK




Epping Gate comprises spacious and modern one, two and three bedroom apartments. There is a private residents’ podium garden to enjoy and electric car charging available. Debden station is only a nine-minute walk, where you can get the Central Line to Stratford in 22 minutes and to Liverpool Street in 31 minutes. Fairview’s Save to Buy scheme and Deposit Unlock are both available here, subject to availability. Buyers also benefit from Fairview’s "Essential Starter Pack" – a gift of household items like cleaning products and kitchen items worth £200.

fairview.co.uk/developments/epping-gate
020 8362 7935
CHATHAM, MEDWAY
Chatham Waterfront
FROM £215,000
Waterfront is Chatham’s newest riverside community offering a range of contemporary one and two bedroom apartments by the Medway Development Company. Located less than 40 minutes away from central London, the eye-catching homes are designed to be spacious, affordable and energy efficient with high-quality finishes. These new apartment buildings are complemented by landscaped garden areas, a new public square and spacious remodelling of the riverside park.
medwaydevelopmentcompany.co.uk/find-your-home/waterfront 01634 557 780
GET ON THE LADDER 28 First Time Buyer June/July 2023

CASE STUDY
Linu, 28, and Sam, 29, have purchased their first home with the shared ownership scheme. The young couple, keen to stay in Southall, purchased a 25% share of a two bedroom apartment at Union Walk at the Green Quarter from Latimer, by Clarion Housing Group.

Linu, a senior policy adviser and blogger, says, “Previously, we were renting a one bedroom flat in Southall, but when our rent increased it wasn’t financially viable for us to stay there. We’d heard about shared ownership, so decided to research the scheme and quickly realised that it was the best option for us. I’ve spent most of my life in Southall and having my family and friends nearby was a priority. Without shared ownership, there’s no way we could afford to stay in London.”
Linu and her husband, Sam, a freelance book illustration artist, were able to view both the show home and the plot they decided on. Linu recalls, “Looking around the home, we saw a space we could easily imagine living in.” Now, the couple are reaping the benefits of homeownership, and using the second bedroom as an office has helped Linu to regain a healthy work-life balance.
“It’s amazing to have a home to call our own,” she says, “and although we’re taking our time to decorate and buy furniture, we can already see our dream home taking shape.”
SHARED OWNERSHIP
HARINGEY, NORTH LONDON
Evergreen
Evergreen is a modern collection of two bedroom apartments available for shared ownership. All homes boast bright and spacious layouts with engineered oak flooring, modern integrated kitchens with composite stone worktops and integrated appliances, triple glazing for energy efficiency, and private outdoor space to every home. Conveniently located just a short walk from Turnpike Lane underground station, Oxford Circus can be accessed in under 20 minutes. Evergreen is close to Alexandra Palace and Finsbury Park, and is surrounded by eclectic bars, cafes and restaurants.

latimerhomes.com/new-build-homes/london/haringey/evergreen 020 7118 0671






DEPOSIT UNLOCK

FROM £304,995
RAMSGATE, KENT Spitfire Green
Barratt Kent presents a selection of first time buyer and family homes in Ramsgate. Just three miles from the Kent coast, Spitfire Green is surrounded by beautiful green open space with planned wildlife areas and a play park. All homes at Spitfire Green have been constructed with energy efficiency in mind; energy-efficient boilers and high levels of insulation ensure a new Barratt home is up to 57% cheaper to run than the same sized older home with modern day improvements. There will also be electric vehicle charging points to every house. Available with the Deposit Unlock scheme.
barratthomes.co.uk/new-homes/dev-001134-spitfire-green 0333 355 8502

CONINGSBY, LINCOLNSHIRE
Kings Manor
Chestnut Homes is offering an impressive range of two, three and four bedroom homes on the fourth phase at Kings Manor, located in a rural village setting on the edge of the Lincolnshire Wolds. Each house has been designed with traditional architecture and thoughtfully planned internal layouts for modern living. These homes boast a high specification, with carefully considered and selected fixtures, fittings and finishes. With energy efficiency in mind, the homes have gas-fired central heating systems with condensing boilers, thermostatic radiator valves, electronic programmers and high levels of insulation.
chestnuthomes.co.uk/find-a-new-home/kings-manor 01526 343 323
FROM £140,000* FROM £279,950 *Based


GET ON THE LADDER 30 First Time Buyer June/July 2023
25%
on a
share of the full market value of £560,000
FIRST HOMES
ABBEY WOOD Southmere, Crane Court

Peabody is launching a new collection of two bedroom shared ownership apartments at Southmere, which is part of the Thamesmead regeneration in Abbey Wood.

FROM £105,000*
Open-plan living/kitchen/ dining areas have been thoughtfully designed with clear zoned areas, while large windows allow lots of light into the apartments. Most homes benefit from inset balconies, and residents have access to an exclusive podium garden plus purpose-built amenities including a concierge service, residents’ lounge, meeting rooms and workspaces, opening soon. A communal bicycle storage facility on the ground floor also encourages residents to explore the local landscape on two wheels. Transport connections are excellent and Canary Wharf can be reached in just 11 minutes, Liverpool Street in 17 minutes and Tottenham Court Road in 23 minutes.
southmere.co.uk

FROM £120,000*
Having lived in rental properties with their young son for six years, Sahil and Sheetu decided it was time to find a forever home for their family. Starting their search in the middle of the Covid-19 lockdown, they struggled to find a good quality house that they could move into straight away without needing to do additional work.
As Sahil explains, “We initially looked at properties in Birmingham, as we had previously lived in the city, however many of the houses on the market needed renovation and we were eager to move straight in without having to worry about additional costs.”
With prices on the rise, Sahil and Sheetu decided to make use of the Government-backed shared ownership scheme, which would enable them to initially purchase a percentage share of a property, with a long-term plan to staircase. To ensure that they wouldn’t have to compromise on quality, Sahil and Sheetu redirected their house hunt to nearby areas that would offer more space for their growing family but still benefited from direct trains to both Birmingham and London.

When the couple discovered that L&Q had properties available to purchase through shared ownership in neighbouring Warwickshire, the decision was made. The growing community at Beauchamp Park offered them the perfect combination of new build homes within proximity to excellent transport links and an array of nearby amenities, including top-class schools.

WALTHAMSTOW The Chain
Located in the heart of the vibrant neighbourhood of Walthamstow, The Chain is a collection of 518 one to three bedroom shared ownership apartments. Around the corner from St James Street London Overground station, the development offers contemporary homes centred around attractive communal gardens, close to fantastic transport, retail and food options.
All homes at The Chain have a high-quality specification throughout, with stylish kitchens fitted with integrated appliances and bathrooms complete with modern white sanitaryware. Outside, each home has a private balcony or terrace, as well as access to communal gardens. Residents also benefit from a concierge service, on-site bicycle storage and a three year complimentary membership to Zipcar (terms and conditions apply).
Offering fantastic cultural opportunities on the doorstep, The Chain benefits from excellent transport connections; three railway stations – St James Street, Walthamstow Central, and Walthamstow Queen’s Road are within walking distance, providing residents with both underground and Overground links.
lqhomes.com/thechain





After visiting the show home, the family decided it was right for them. As Sahil comments, “Our hearts were set on Beauchamp Park the moment we came across the development. I knew that the Technology Park was nearby, which meant that my commute to work would be significantly shorter. The development also benefits from easy transport links into London, and with great shopping and schools on the doorstep we knew that it was perfect for us and our son. Initially, we were disappointed that timelines hadn’t aligned as there were no homes available when we first looked. However, thankfully, Lisa from the L&Q Sales team took down our details and contacted us the moment the next launch was confirmed, and we were able to buy in the next release of homes.’’
Sahil and Sheetu purchased a 50% share of a three bedroom home with L&Q for £183,750. Reflecting on the first months living in their new home, Sahil comments, “We love the quality and spacious nature of the rooms – it’s a house we can grow in. Since it is a new build property, all our appliances and finishes are brand new so we don’t have to worry about renovating – and the garden has been a joy for the summer months. Beauchamp Park is located close to both Warwick and Leamington Spa, which both offer lots of local community facilities and shops. We also have Warwick Castle nearby, which we really enjoy visiting – the location is perfect.”

GET ON THE LADDER First Time Buyer June/July 2023 31
CASE STUDY
Based on a 25%
of £420,000 *Based
£480,000
share with a full market value
on a 25% share with a full market value of
SHARED OWNERSHIP SHARED OWNERSHIP
SUPPORTING FTBS TAKING THEIR FIRST STEPS ON TO THE PROPERTY LADDER
One of the most significant milestones in anyone’s life is purchasing a first home. Buying a brand new home offers many advantages, and for first time buyers, the benefits are multiplied when buying from an experienced, multi-award-winning and well-respected developer such as Higgins Homes. This is further enhanced by a range of incentives offered by Higgins Homes that is a bespoke tailored offering meeting the different needs of buyers
Higgins Homes has provided homes for first time buyers for many years, so understands their needs and challenges. One of the most pressing issues is finance, which is why Higgins Homes offers a 5% Deposit Top-Up scheme. Purchasers with a 10% deposit in place can unlock a further 5% contribution from Higgins Homes, giving buyers a 15% deposit in total. This enables better interest rates, affordability and lower mortgage payments.
To support buyers even further, Higgins Homes has launched #HomesComfort offering bespoke incentives tailored to meet individual challenges. This includes a mortgage paid for a fixed term, energy bills paid for a fixed term, childcare allowance, and broker, legals or service charge paid.
To assist the buying process, the Higgins Homes team can put customers in touch with a range of legal firms and
independent financial advisers that they have experience with.
Charlotte Bentall, Business Development Director for New Homes Law, explains the benefits of a specialist new homes legal team, “We have good knowledge of the development site prior to release and searches are put in place earlier.
In a nutshell, we have an excellent understanding of the new homes market and the legal processes that sit behind it, leading to a faster and smoother buying process.”
In terms of securing a mortgage, Higgins Homes recommends that first time buyers speak to an independent broker who has an in-depth knowledge of new homes and can tailor a mortgage to specifically meet their needs. “It is important to use a brokerage that can go to any lender in the market, whether they are high street or specialist, and they should have excellent knowledge
and access to the first time buyer schemes that are available,” says Lee Isham, Founder of Lifetime Capital. “For all buyers, we pride ourselves on our high levels of customer care and orchestrate the entire deal from the initial contact call until they have moved in.”
Higgins Homes offers customers the opportunity to create the home of their dreams. Buyers can customise elements of their home, selecting from options available as part of the standard inclusive specification, so creating their bespoke #MyHigginsHome.

There is also a Furniture Pack option, something that will really transform a house into a home. Higgins Homes is delighted to announce a partnership with BoConcept, provider of contemporary Danish furniture, accessories, and lighting for the modern home. The furniture package will not only save you time spent researching interiors, but you are likely to also save money as pieces are carefully selected to create a seamless style, avoiding costly impulse buys. BoConcept aligns with the very highquality fixtures and fittings that Higgins Homes is known for, creating truly original and beautiful spaces. BoConcept works with Higgins Homes’ customers to provide an easy one-stop solution, removing the complexities of sourcing items from multiple suppliers. There is a range of packages available, with the design team taking customers through the whole process. These incentives, together with Higgins Homes’ exceptional reputation for customer care, ensure a stress-free move. Buyers are encouraged to use the hashtag #MyHigginsHome to share their journey and moving home experience. Becoming homeowners should be a joyful time and Higgins Homes does everything possible to provide first time buyers with a hugely positive experience.
higginshomes.co.uk
OPEN MARKET 32 First Time Buyer June/July 2023
BoConcept stock image

RENT, SAVE AND BUY!
HOW IT WORKS AND ELIGIBILITY
Eligibility for London Living Rent is restricted to existing private and social renters with a maximum household income of £60,000, without sufficient current savings to purchase a home in the local area.
General eligibility is:
9 You must be currently living or working in London
9 You must either have a formal tenancy (for example, in the private rental sector) or have an informal arrangement with family or friends as a result of struggling with housing costs
9 Priority will be given to applicants who live or work in the development host borough
9 You must be unable to currently buy a home (including through shared ownership) in your local area – see "Allocations and priority" below for more details on how this works
9 You must provide one month rent in advance and one month rent as a security deposit
9 You must demonstrate the ability to pay the rent without using savings
9 You must demonstrate the ability to save toward a purchase deposit
9 The apartment will be your primary residence
9 You must not already own a property either in the UK or abroad
9 You must supply three months’ payslips, or if self-employed, a full year of accounts or the past tax year's SA302 form, and six months of the latest bank statements
9 You must meet lenders' general criteria to obtain mortgage finance
9 You must have no history of rent arrears from previous properties within the past 12 months
9 You must not have breached the terms of a tenancy agreement.
Priority policy:
To reflect the Mayor of London’s Homes for Londoners programme, priority will be given to serving military personnel and former members of the British Armed Forces discharged in the past two years.
Additionally, for the first eight weeks following the full market release of the development, priority will be given to applicants from the following groups, in priority order:
9 Council or housing association tenants meeting the London Living Rent eligibility criteria living in the development host borough
9 Applicants meeting the London Living Rent criteria living or working in the development host borough
Network Homes is passionate about helping every first time buyer and because it realises it can be tough to raise a deposit, it is offering London Living Rent at some of its developments, which is the perfect way to save and buy.
Funded by the Mayor, the idea behind London Living Rent is to help people switch from renting to shared ownership. It is designed for people who want to build up their savings to eventually buy a home through shared ownership.
London Living Rent offers affordable homes for private rent on shorthold tenancies for up to three years.
SIMPLY:
9 Find a London Living Rent home that suits you and your needs
9 Rent the home at a discount
9 Save the discount for your deposit
9 Buy shares in your home through shared ownership
Discounted rental contracts can be renewed, if needed, for up to 10 years after the launch of each scheme; during which time, you will be able to gradually build up your deposit.
When you’re ready, you have the option to buy the home you’ve been renting (or another eligible Network Homes property) on a shared ownership basis. The good news is that when you buy is flexible and Network Homes will support you to save during your rental stay, so you can buy at your own pace.

LONDON LIVING RENT 34 First Time Buyer June/July 2023
Buying your first home is very exciting but saving for a deposit can be a problem. Help is at hand though, with London Living Rent
QUESTION TIME
Do I qualify for a London Living Rent home?
To qualify for London Living Rent you must meet the following criteria:
9 Your annual household income must not exceed £60,000
9 You must live or work in London
9 You must be unable to buy a home, including through shared ownership, in the local area
9 You must not own a residential property in the UK or overseas
9 You must meet the minimum income required for your preferred property
9 You must meet lenders' general criteria to obtain mortgage finance
The full eligibility criteria and priority policy for a particular development can be found on the advertised listing.
How do I register my interest in London Living Rent?
You can register your interest online through the London Living Rent scheme adverts. This is where you can find an enquiry form and eligibility criteria.
How long does it take to complete the process?
As we complete a thorough vetting process prior to you viewing the property, we can usually move you in within two to four weeks subject to the property’s availability.
How long is a London Living Rent tenancy for?
We ask you to sign an assured shorthold tenancy for three years. Usually, you will have a two-month break clause from the 12th month, so you can move out after 12 months if your circumstances change. At the end of the tenancy, and if you’ve been a reliable tenant, you will be offered a tenancy renewal.
How long can I stay in my London Living Rent home?
If you fulfil your obligations as a London Living Rent tenant, you are entitled to remain in your home for the duration of the London Living Rent term.
The London Living Rent term is separate to your tenancy term and usually lasts between five and 10 years from the date the development was completed. This term can
Juliana Goode, Senior Build to Rent Manager

vary between developments. So, if a scheme with a 10-year term was completed on 1 January 2020, the London Living Rent term would end on 31 December 2029.
Can I move to an alternative London Living Rent apartment once my term ends?
You can’t move to an alternative if you’ve completed the stated London Living Rent term (usually five to 10 years).
Are bills included in my rent? Only service charges are included in your rent, you will need to pay for all other bills.
Must I save a minimum amount each month?
You are the best judge of what amount is affordable for you to save each month. By renting through London Living Rent you benefit from a below-market rent so will have the ability to save based on the minimum income requirement for your London Living Rent home. The more you save the quicker you will raise the deposit required to buy your first home. We are happy to discuss your saving options with you.
Must I deposit any saving with you? No, you will need to manage your savings.
How soon after moving into my London Living Rent apartment can I purchase my first share?
You can buy the first share after six months as long as you have the deposit and income to meet repayment obligations.
Must I buy the apartment I am living in? No, as a London Living Rent resident you will be considered a priority applicant (along with other housing association and council tenants) for shared ownership apartments across London.

networkhomes.org.uk/londonlivingrent
ISLEWORTH, HOUNSLOW St John’s Road
Network Homes' brand new development of one, two and three bedroom homes is available with London Living Rent. Perfectly located for your journey from renting to owning your own home, these light and airy apartments in West London (Zone 4) are the perfect choice for city, nature, culture and leisure and a quick and easy commute – who could ask for more? With easy access to the tube and rail, central London is within easy reach. Locally, there are a host of leisure opportunities to enjoy including Waterman’s Arts Centre on the riverfront, which is a cultural hub showing live and recorded performances and exhibitions. For those who enjoy the great outdoors, you will be spoilt for choice with many walking and cycling routes within easy reach. Syon Park offers 40 acres of gardens to wander in and Osterley Park also has acres of parkland to explore. For all your daily shopping needs there are supermarkets, a post office and pharmacy around the corner and many independent outlets nearby too. Plus, there is also a great selection of pubs, cafes and restaurants on the doorstep. The high-specification, open-plan apartments are spacious and light, with high ceilings in all living spaces. The larger two and three bedroom homes include an en suite shower room, in addition to the main bathroom. Kitchens come with integrated appliances including a fridge-freezer, dishwasher and washer-dryer. Each apartment also comes with a balcony or garden.
To register your interest go to: networkhomes.org.uk/ londonlivingrent
LONDON LIVING RENT First Time Buyer June/July 2023 35
Greenwich HOTspot



The stunning market town of Greenwich is one of South London’s most desirable places to live, and with good reason. Just six miles south east of central London, you’re close enough to feel the buzz of the city, but far enough away to enjoy the peaceful – and plentiful – parklands
UNDER THE SPOTLIGHT
5













REASONS WE LOVE… GREENWICH

1 The incredible architecture
2 Greenwich Park with its skyline views


3 The IFS Cloud Cable Car
4 The Thames – especially the Cutty Sark
5 Cheering on runners at the London Marathon
OUT AND ABOUT
Famous for its stunning architecture and Royal Museums, Greenwich is located in the ceremonial county of Greater London and is a treat for the senses, not least because of its enviable riverside location.

Home to the Greenwich Meridian at the Royal Observatory, the town has a strong maritime history and has been home to royalty since the 15th century. The Royal Naval College, designed by Sir Christopher Wren and his assistant Nicholas Hawksmoor, still stands proudly, the famous clipper, the Cutty Sark, sits on the river front, and the National Maritime Museum can be visited in the former Royal Hospital School. Transport links couldn’t be better. Docklands Light Railway (DLR) offers services to Canary Wharf and beyond on the Lewisham Line, from both Greenwich and Cutty Sark stations, and there are regular trains from Greenwich and Maze Hill to London Bridge, Blackfriars and Cannon Street. Most of Greenwich is in Zone 2, apart from Maze Hill, which is in Zone 3.
Local bus services are fantastic and, if you drive, the M25 South is around 15 minutes away and the M25 North around 35 minutes. The Blackwall tunnel links the Greenwich Peninsula with the Isle of Dogs, Canary Wharf and the rest of east London north of the Thames. On your bike? The Thames Path cycle route is a pretty perfect way to get from A to B.
But why travel by land when you can go by boat? Uber Boats (by Thames Clippers) go as far as Putney to the west and Barking Riverside to the east, with services calling at 24 piers across London. Alternatively, zip across the Thames on the IFS Cloud Cable Car which takes you from Greenwich Peninsula to the Royal Docks.


Beyond the obvious aesthetic and commuter appeal, Greenwich just keeps giving. Families are spoilt for choice when it comes to schools; many of the local state schools have been rated Outstanding by Ofsted, and there are numerous highly regarded independent schools too. The borough also offers some of the cheapest council tax in London – a welcome relief when budgeting for a new home.
Where to begin? We’d suggest with a day on the river. Be it seeing the sights by boat, crossing the river by cable car for afternoon tea on the luxurious Sunborn yacht, or simply whiling away the hours on the waterfront at the historic Trafalgar Tavern.
Alternatively, head to the 183acre Greenwich Park where you’ll find The Royal Observatory and National Maritime Museum, a flower garden, deer park and cafe, and incredible views across the city. A Royal Museums Greenwich Day Pass will give you discounted entry to the Royal Observatory and Cutty Sark, where the brave (aged 10+) can now even experience a unique rig climb experience! Locally, Oxygen free-jumping, Hollywood Bowl and the Greenwich Peninsula Driving Range are also great fun for all ages.



If you like a spot of shopping, Greenwich Market is open daily with shops and stalls packed with everything from art to antiques.
However, there is still








Some areas are, of course, pretty pricey, particularly West Greenwich, which is home to some stunning period properties. However, there is still plenty of affordable housing in East Greenwich, with Greenwich Peninsula boasting an impressive collection of new homes.

The Greenwich Vintage Market is also open Friday to Sunday, offering an eclectic mix of vintage books, jewellery, music, antiques and homeware. Independent stores are peppered around the medieval town square too, so you can easily spend a day here, stopping only to refuel on delicious international street food. For more practical
are peppered around square too, so you can




LOCATION 36 First Time Buyer June/July 2023
Average property price in Greenwich (February 2023) – £446,652

Property breakdown*
Detached – £976,310
Semi-detached – £687,504
Terraced – £510,727

Flat – £371,187
*According to the Land Registry House Price Index




HOMES ON THE MARKET...
FROM £449,995
FAMOUS RESIDENTS
•
•
•
•
purchases for your new home, Greenwich also boasts inner London’s first IKEA!



The food scene in Greenwich is pretty laid back with impressive breakfast and Sunday roast offerings. You have many of the usual chains by the Cutty Sark, but we recommend a wander along the river to Midpoint Restaurant at Anchor Iron Wharf to check out the incredible Turkish breakfasts. There are plenty of pubs to enjoy, and livelier options for the evening, including Belushi’s for cocktails, live music and DJs. Oliver’s Jazz Bar has live music every night, or if you like to dance, head to Studio 338 club on the Peninsula.
The O2 Arena is one of London’s biggest attractions and it’s right on your doorstep. By day, you can enjoy VR experiences, iFLY indoor skydiving or even climb over the iconic dome. By night, enjoy live music by international stars. The Cineworld (at the O2) and the Odeon IMAX in North Greenwich offer the latest blockbuster films, while at the Greenwich Picturehouse you can also enjoy vintage films, arts screenings and dedicated baby, toddler and children’s screenings. The Greenwich Theatre is another local gem.
Unsurprisingly, Greenwich is a great place for rowers; the Trafalgar Rowing Centre, clubhouse of the Curlew and Globe rowing clubs, is located on Crane Street. Runners also have the perfect training grounds in the Thames Path and Greenwich Park. Alternatively, just cheer the runners on as they pass along the route of the annual London Marathon!
GREENWICH Greenwich Millennium Village

This stunning development offers rst time buyers the opportunity to experience the best of city and country living. Located just a short walk from North Greenwich tube station, it is perfect for commuters, culture enthusiasts and those looking for a vibrant nightlife.



Its excellent transport connections means that Canary Wharf, Stratford and London Bridge are all easily accessible by tube within 10 minutes thanks to the Jubilee Line. Just a stone’s throw from the River Thames, Greenwich itself is one of London’s most historic districts but also has a very modern and cosmopolitan culture, which offers great shopping, dining and entertainment.
Greenwich Millennium Village’s tranquil setting is home to an array of everyday amenities including a convenience store, dry cleaner, pharmacy and hairdressing salon. While for those looking to connect with nature, the on-site Ecology Park hosts a diverse range of wildlife. In addition, Southern Park provides an abundance of green space to enjoy.
Homes at The Galleria comprise a selection of one, two and three bedroom homes with a proposed nursery and cafe. Many homes enjoy picturesque views over Southern Park while others overlook a central podium garden planted with a variety of wildlife-friendly ora. Each openplan home boasts bright and airy interiors with a superior speci cation including fully integrated appliances in the kitchen, built-in wardrobes, oor-to-ceiling windows and carpet to the bedrooms, plus under oor heating. Residents also get support from the 24-hour concierge. This development really does offer luxury city living with community at its heart.
greenwichmillenniumvillage.co.uk
020 8023 7177










LOCATION First Time Buyer June/July 2023 37
• Actor Sir Daniel Day-Lewis
Singer and Presenter Marvin Humes
Weightlifter Zoe Smith
Actor Dominic Cooper
Journalist and radio presenter Nick Ferrari
FACT FILE
LONDON LIVING RENT IS THE WAY TO GO!
With rising monthly household costs combined with all-time high prices, navigating London’s property market has become increasingly challenging in recent months
Luckily, for some renters who are looking ahead towards purchasing a home in the capital, London Living Rent (LLR) is a stepping stone scheme which supports eligible tenants with building up savings each month towards a deposit.
First Time Buyer magazine chats to Andrea Palmer, Head of London Living Rent at L&Q, who shares her advice for renters who are looking to apply for the scheme.

She explains, “It is no secret that current property market conditions have meant that renters and buyers alike can be facing further difficulties when it comes to securing tenancies and buying homes.
“A fantastic opportunity for renters who hope to one day buy their own home, London Living Rent is a Governmentbacked scheme that enables you to rent a home at a discounted rate – sometimes up to as much as 50% less than a similar property on the open market. This helps you save additional money each month, which can then go towards buying a home, either through shared ownership or on the open market.”
Do I need to save a certain amount each month?
“As an LLR tenant, you benefit from a below-market rent so will have the ability to save more than you would if you were privately renting. The more you save, the quicker you will raise the deposit required to buy your first home. We have a friendly team on hand to discuss your saving options with you.”
Must I buy the home I live in?
“For those seeking stability, or who simply love the home they’ve been renting, a major benefit of the scheme is that
you can go on to purchase the home you already live in if you’d like to.”
Where can I rent a home in the capital?
“Our developments span the width and breadth of London, with a broad range of homes across several boroughs including Walthamstow, Wandsworth, Newham, Croydon and Barking & Dagenham, meaning that we’re able to help a really wide range of renters find their perfect home.
“For young professionals seeking a well-connected
One of L&Q’s recent tenants, Beatrice, found her new London Living Rent apartment in L&Q at Hayes Village, west London. She comments, “I’m hoping to buy my home in the future. Because of LLR, I’ve managed to start saving towards a deposit and I want to speak to L&Q more about the nancial requirements of buying my apartment through shared ownership. It’s an amazing opportunity to buy the home I’m already living in and I’m really looking forward to taking the next step.”

development in the heart of a vibrant neighbourhood, look towards L&Q at Queen’s Quarter in Croydon, where we have one and two bedroom apartments available. It’s the place to be, as Croydon is London’s Borough for Culture for 2023 and the area is benefiting from a dynamic programme of events taking place throughout the year.
“Alternatively, we also currently have homes available in the sought-after neighbourhoods of Nine Elms and Royal Docks, enabling you to get a slice of riverside living in the capital for less!”
Head to L&Q’s website to nd out more about available developments and eligibility criteria: lqhomes.com/LLR
Andrea Palmer, Head of LLR, L&Q

LONDON LIVING RENT 38 First Time Buyer June/July 2023

THE HIDDEN HEALTH IN A WESTON HOMES PROPERTY
The rise in the cost of energy highlights the efficiency benefits and cost savings provided by new build homes. Energy efficiency is a growing priority when buyers are looking to buy a home and the savings on a new build property demonstrate why it is a financially astute investment and could save you thousands on running costs
NOW IS THE TIME TO BUY A NEW BUILD HOME

Weston Homes are passionate about sustainability and are committed to helping customers save energy and water to keep money in their pocket. Integrating intelligent engineering into every aspect of their homes to reduce their carbon footprint, Weston Homes careful considers every element of the design to optimise energy efficiency. Using modern methods of construction to manufacture the frames, insulation, external walls, bathroom cabinetry and fitted wardrobes in a resourceful and energy efficient way, their homes are cheaper to run because of the accuracy of the construction.
New research based on Government
Energy Performance Certificate (EPC) data found that buyers of a new build apartment will save an average of just over £2,500 a year in energy bills. A report published by the Home Builders Federation shows that in total, last year’s new build purchasers saved more than £500m on annual energy bills, with new build homes emitting a third of the carbon of an older property, reducing carbon emissions by over 500,000 tonnes.
Housing accounts for 40% of the UK’s energy use so it is imperative that this energy is used efficiently. 84% of new build homes have an A or B rating for energy efficiency compared with less than 4% of existing properties according to Government EPC research and data. Weston Homes EPC ratings are rated B.
IT’S ALL IN THE DETAIL
The design team at Weston Homes carefully consider every element of their homes from insulation and glazing to heating and internal specifications, all in a bid to optimise energy efficiency. The less heat that escapes, the less energy is required from the heating system which reduces CO2 emissions and saves on running costs.
LIVING HEALTHILY – INSIDE AND OUT
According to a recent YouGov survey, 33% of home buyers say the pandemic has made having a garden more important to them and 25% of buyers seeking access more green space than they currently have.
NEW HOMES 40 First Time Buyer June/July 2023
THE HIDDEN HEALTH IN WESTON HOMES’ APARTMENTS
Weston Homes has designed its apartments to incorporate some or all of these features


Weston Homes builds affordable homes and brings residents together by creating tranquil outside spaces for people to enjoy.
With many households now opting to socialise at home, buyers are keen to embrace spacious, open plan living. Explore Weston Homes’ range of exceptional homes that offer the perfect space for relaxing and entertaining. Every property benefits from a market leading fully inclusive specification to minimise those ‘start up’ costs of buying a home. You can choose from a wide range of designer kitchen units and quartz stone
worktops.* Every property includes as standard an integrated fridge-freezer, washer-dryer and dishwasher with energy saving ceramic hobs. These products have been chosen for their energy and water efficiency as well as their performance to help reduce CO2, waste and running costs. Open plan living areas to every home are bright and spacious and luxurious flooring is fitted throughout. You can choose from a wide range of choices* at no extra cost and design your new home to your personal style.
Voted ‘Private Developer of the Year 2022’ by readers of First Time Buyer magazine and ‘Best Medium Housebuilder of the Year’ at the 2022 WhatHouse?

Awards, Weston Homes is an awardwinning developer building new and converted homes across London and the South East from £199,000.
For more information contact Weston Homes on 01279 873300 or visit westonhomes.com for development specific information. Marketing suites and show homes are open daily from 10am to 5pm.
To view the animated version of the graphic or for more information about buying a new Weston Homes property visit weston-homes. com/our-homes/why-buy-new-from-westonhomes
*Subject to the stage of construction.

NEW HOMES First Time Buyer August/September 2016 41
Solar panels Energy-efficient appliances Energy-efficient heating Sanitaryware with flow control and reduced water volumes Energy-efficient lighting Electric vehicle charging point Airtight and thermally efficient structural insulated panels (UNI Panels/UNI Walls) High performance thermal windows and patio doors High Efficiency Ventilation Sustainable urban drainage system
*Houses built by Weston Homes also incorporate many of these features; please ask for information specific to your chosen development.
saving energy, water and your pocket.*
“I LOVED HOW INTEGRAL THE COMMUNITY WAS TO LEASIDE LOCK”
registering my interest to handing over the keys has been really impressive. I was moving out of my rental house in Lewisham and Guinness made sure I could move into Leaside Lock on the same day – the personal touch and extra effort was something I really appreciated.”
All apartments at Leaside Lock offer contemporary open-plan living complete with high-specification features throughout, as standard.
David comments, “I knew I was going to purchase my next home, after renting for the last few years, but I was really looking for somewhere that had what my other flat lacked; a modern space with a view and a sense of community.”
Finding homeownership on the open market in Bromley-by-Bow was out of reach for David, but through shared ownership he was able to purchase his first home in Zone 2, east London.

David adds, “I did a lot of research around shared ownership, and found that I was able to afford somewhere that otherwise would never have been in my price range, with amazing views of the city skyline and the tube right on my doorstep. Without the scheme I’d be looking really far outside of London, but with shared ownership I could afford somewhere in Zone 2. I also found that for my maximum budget and current salary, the homes available on the open market needed a lot of work doing to them, but the options available at Leaside Lock on my budget were incomparable!”
Through shared ownership, David was
able to purchase a one bedroom apartment at Leaside Lock – a new development by Guinness Homes in Bromley-by-Bow, a Zone 2 borough in east London.

The location was one of the selling points for David, who said, “I used to live in Bow, so know the area well. It’s also close to one of my best friends, so it’s lovely to have her around the corner! Likewise, the fact I can be in the centre of London in 15-20 minutes from Bromley-by-Bow station is a real selling point.
“Having said that, there’s so much already on my doorstep at Leaside Lock. The roof terrace with views overlooking the Olympic Park is amazing in the warmer weather, and I’m really looking forward to the co-working space and coffee shop coming soon. Being so close to the canal, and having that nature on your doorstep, as well as the hustle and bustle of the city, is a rare balance in London.”
David found the sales team to be very helpful throughout, ensuring his buying process was as smooth as possible.
David said, “The Guinness team were amazing, their communication from
“My favourite part of the apartment has to be the west-facing windows. Being a teacher I’m up really early in the morning, so I don’t get to see the sunrises, but being able to see the sunsets in the evening over east London is really special.”
The sense of community was integral to David’s decision, and he is delighted a community is already flourishing just months after launching.
“We’ve already got a WhatsApp group which is great for sharing bits around the developments, and there were recently drinks up on the roof terrace, so it’s great people have already started socialising.”
David finishes, “The dream is to retire to Italy, but as long as I live in London, Leaside Lock is my home.”
Providing buyers an affordable route onto the property ladder in Bromley-byBow, there is a range of shared ownership homes available.
Shared ownership prices start from £100,000 for a 25% share of a one bedroom apartment (full market value £400,000) and £123,125 for a 25% share of a two bedroom apartment (full market value £492,500).
leasidelock.com
Shared ownership terms and conditions apply
AFFORDABLE HOMES 42 First Time Buyer June/July 2023
After renting in London for 14 years, David was ready to put his roots down and buy a place of his own in east London

LOVE WHERE YOU LIVE: LOUGHBOROUGH JUNCTION
Located between the buzz of Brixton, creativity of Camberwell and historic Herne Hill, Loughborough Junction is an often overlooked and underappreciated treasure. More than just a Zone 2 railway station surrounded by trendy hotspots, this vibrant community is a destination in its own right. Home to Peabody’s stunning collection of apartments at Higgs Yard, buyers here can enjoy everything they need – and more – right on their doorstep
WAKE UP AND SMELL THE COFFEE
Late night? Busy day ahead? Sometimes you just need a proper coffee! Whether looking for an espresso to kickstart the morning or a flat white to enjoy while catching up with friends, pop in and see Ed at Four Boroughs – a coffee lover’s paradise. From tirelessly searching to secure the best beans to ensuring baristas are thoroughly trained, this local business makes a delicious drink every time. Continuing the love and care, Four Boroughs also sells coffee beans, kombucha, kimchi, vegan pastries, sourdough bread, and sandwiches, that are all made locally or in small batches.
EXPRESS YOURSELF
Let your creativity run wild at Artichoke Print Workshop. Offering courses and sessions accessible for all skill levels, this London print studio hosts some of London’s most highly sought-after professionals. With Camberwell College of Arts not far away, Artichoke embraces the local culture of creativity and has a proven track record for supporting young artists following their graduation.
For those looking to brighten up their home, the space also operates as a gallery, showcasing the work of those benefiting from the studio facilities. With a longstanding relationship with the Affordable Art Fair, it is easy to add a splash of colour to any room while also supporting the work of local artists.
FRIENDSHIP AT HEART
Hoping for something just a little bit different to brighten up your week?
Friendship Adventure is a brewery with a twist. As well as serving fresh beer brewed on-site, the Taproom hosts a variety of regular events for memorable moments with friends. With monthly quizzes, live music, and comedy nights, you can enjoy the best of traditional pub culture. For those hoping for something just a little
bit different, weekly early morning yoga sessions get the brain and body moving for a reinvigorating experience.
SIP YOUR WAY AROUND THE WORLD
Looking for a bit of escapism? Explore a world of craft beer at Craft Metropolis without ever leaving the city. Importing drinks from New York, Poland, Sweden, Greece, and Germany, this local business serves refreshing beers in a unique cavern setting. For an even more memorable experience, Craft Metropolis also hosts regular football nights and cinema screenings, that are certain to generate a lively atmosphere.
ENJOY MORE THAN A HOME AT HIGGS YARD

Placing all these local businesses within a five-minute walk from home, Higgs Yard is Peabody’s latest offering of one, two and three bedroom homes. Reflecting the lifestyle on offer locally, homes feature contemporary designs and high specification interiors. An on-site cafe

provides a further venue to socialise with neighbours and grab a coffee before heading across the road to the railway station for convenient commuter services.
With so much to explore in and around Loughborough Junction, a 24-hour concierge on-site ensures that parcels are signed for while residents are out and about. For those favouring active travel, secure cycle storage allows buyers to take full advantage of the nearby C17 and C48 cycle routes. And, at the end of the day, when it’s time to relax and unwind, each apartment at Higgs Yard benefits from its own private outdoor space in the form of a spacious balcony, as well as access to a communal roof terrace.
Discover Higgs Yard today at peabodynewhomes.co.uk/higgs-yard
AFFORDABLE HOMES 44 First Time Buyer June/July 2023
CGI*
CGI*

HELPING YOU MOVE, WITH SHARED OWNERSHIP



Buying a home can be expensive – and with the end of Help to Buy combined with the cost of living continuing to rise, you may feel that getting on to the property ladder is out of reach. From saving for a deposit to moving costs and solicitor fees, it can seem as though there are countless and costly hurdles between you and your dream home




YOU’VE SAVED FOR THE KEYS, NOW LET US HELP WITH THE FEES

At Legal & General Affordable Homes, we want to help your money go further. You’ve saved hard for the deposit and made the commitment, so why not let us help you cover the moving costs? Some of our developments benefit from up to £6,500 towards moving costs if you reserve before the end of June.
THAT’S ON TOP OF ALL THE OTHER ADVANTAGES WHICH SHARED OWNERSHIP ALREADY PROVIDES




Shared ownership is an alternative route on to the property ladder where you buy a share of between 25% and 75% of the home’s full value and pay rent on the remainder. You can purchase further shares until you own 100% of the property should you choose to. Deposits for shared ownership can be as low as £5,000 because you’re only paying a deposit for the percentage that you’re buying. The lower deposits needed for shared ownership mean you can get on the property ladder with a smaller amount than you might have anticipated.
All of our shared ownership properties are new builds with high energy-efficiency standards to help keep bills low. Some homes also have solar panels to help buffer residents from energy price volatility and protect the environment.



We realise that one size doesn’t fit all, so whether you’re a first time buyer, have a growing family, or are looking to downsize in a beautiful part of the country,


we offer a huge range of properties to suit different lifestyles and needs – from studio apartments to four bedroom houses.
CITY, COUNTRY AND SOMEWHERE IN BETWEEN
If you love living in London but are struggling with sky-high rent, the studio and one bedroom apartments at Acer Apartments in White City may be what you’re looking for. Nestled among some of London’s most prestigious postcodes such as Notting Hill, Holland Park and Kensington, it offers a choice of two tube stations in Zone 2. Westfield, Europe’s largest shopping centre, is right next door with over 400 stores and seemingly endless restaurants and cafes for socialising. For a minimum 25% share, prices start at £126,250 for a studio and £177,500 for a one bedroom home.
But if you want to swap the bustle of London for the beauty of the countryside, have a look at our homes at Little Cotton Farm. The two bedroom homes are on the outskirts of the scenic riverside town of Dartmouth and are perfect for nature lovers. Situated close to South Devon’s
Area of Outstanding Natural Beauty, Little Cotton Farm offers pristine countryside and beautiful beaches. Walking distance to Dartmouth Leisure Centre means there are activity options throughout the year, and the popular boat trips and steam railway around the coast provide entertainment during the summer months. For a minimum 25% share, prices start at £58,750 for a two bedroom home.
Looking for a bit of both? Set in the heart of 413 acres of parkland, Trent Park is a green oasis offering fantastic, uninterrupted views across the park and golf course from the one and two bedroom homes. With Cockfosters and Oakwood underground stations a short walk away, Trent Park offers countryside living while still being within touching distance of central London. With a mix of natural and purpose-built landscaping, homes here allow you to escape the city and spend your down-time exploring nature. For a minimum 25% share, prices start at £110,652 for a one bedroom and £130,000 for a two bedroom home.
To nd out more about shared ownership and how you can save up to £6,500 when you reserve by 30 June 2023, visit landgah.com

SHARED OWNERSHIP 46 First Time Buyer June/July 2023
Trent Park, En eld
Little Cotton Farm, Dartmouth Acer Apartments



COMBINE QUALITY, AFFORDABILITY AND LOCATION AT ASPECT CROYDON
Rising above the streets of East Croydon, Notting Hill Genesis’ Aspect Croydon offers a solution, with intelligently designed homes in a vibrant location available to buy through shared ownership.

THE HIGH LIFE AT AN AFFORDABLE PRICE
With just a few apartments on each of the development’s 25 floors, a sense of exclusivity is central to Aspect Croydon, and residents benefit from added luxuries, including being welcomed into an impressive lobby by a dedicated concierge.
The contemporary apartments don’t compromise on quality, with sought-after features for first time buyers including integrated appliances, a utility cupboard with separate washer-dryer, built-in wardrobes and ample storage space. Designed to support efficient living, homes include energy-saving technology such as A-rated kitchen appliances, LED lighting and underfloor heating throughout.

The homes have a sophisticated feel, with statement flooring and warm wood features harmonising the kitchen and bathrooms. Handleless kitchen cupboard units have a two-tone cashmere and white matt finish, while selected apartments feature custom-made fluted wood breakfast bars. The neutral palette of the decor, combined with the use of natural textures and materials, has created homes that feel modern and fresh.
A highlight of the homes are the private winter gardens, many of which are dual aspect, with floor-to-ceiling windows which flood the apartment with natural light. This flexible, sunlit space can be used all year round for al fresco dining, working, or as the perfect spot for plants.

Homes are available from £87,500 for a one bedroom apartment, £108,750 for two bedrooms and £126,250 for three bedrooms – all for a 25% share.
A THRIVING NEIGHBOURHOOD
Located in the heart of East Croydon, the
development is an important new part of the street scene. Outside, a centralised avenue of trees, public art and a landscaped seating area are nestled into the boulevard, where residents can meet with friends or watch the world go by.
Crowned the London Borough of Culture for 2023, Croydon is a hotspot for first time buyers thanks to its amenities, transport connections and community feel. Notting Hill Genesis’ development has been popular so far, including with professional couples living locally, buyers in their 30s and those who commute to central London or work in the local area.
As this vibrant neighbourhood continues to grow, there is plenty on offer for residents seeking entertainment, or a place to grab a bite. Just around the corner, Croydon’s busy hub of restaurants, bars and attractions include the popular Boxpark, with its street cuisine and event space for movie screenings, live music, and comedy nights. At historic Surrey Street Market, locals enjoy two fantastic pubs – craft beer specialist Art & Craft CR0
location and good travel connections
and gastropub Mr Fox. Aspect Croydon’s proximity to green space is another draw, with the borough home to over 120 parks and open spaces. Within walking distance from the development, residents can find the relaxing haven of Waddon Ponds, as well as the 15-acre Park Hill park, with its walled gardens, tennis courts and historic water tower.
EXCELLENT TRANSPORT LINKS
As buyers prioritise fast travel connections, Aspect Croydon delivers with an incredibly diverse transport system on the doorstep. The development is a five-minute walk from East Croydon railway station with trains running to central London in under 30 minutes. Wellesley Road tram stop is also right outside, providing routes throughout south London via one of the capital’s only tram services.
For more information, contact the Notting Hill Genesis sales team on 020 3733 3571 or visit nhgsales.com
SHARED OWNERSHIP 50 First Time Buyer June/July 2023
Finding a first home in London can seem a challenging prospect, and for many buyers there are important boxes to tick – including quality, affordability,

IT’S ALL ABOUT THE LOCATION!
You would never imagine you could live in an affordable home right in the heart of London’s financial district. But it is now possible because Latimer, the development arm of Clarion Housing Group, which has partnered with the Far East Consortium, is offering Alta at Consort Place, an inspiring new address in Canary Wharf



This ground-breaking release of 44 one, two and three bedroom shared ownership apartments stands atop the 32-storey high Alta at Consort Place, which is to become part of the iconic London skyline. Buyers at Alta, which sits alongside shops, a hotel and a restored Victorian pub, will be part of an exciting new community, with private resident lounges on the fifth and 30th floors. Consort Place is not just somewhere to live, but a place to put down roots, work and relax in.
Selected homes benefit from a private balcony and because of the building’s curved windows and impressive altitude, the views are truly incredible. Each home features a versatile design perfect for contemporary living. Kitchens come with integrated appliances including a fridge-freezer and dishwasher. Bathrooms are luxurious and the bedrooms relaxing.
Alta is set in landscaped areas and a new square, and there is also a community hall, cafe and a selection of shops, and a lovingly restored Victorian pub. Right in the heart of iconic Canary Wharf, there is plenty on hand to see and do including Crossrail Place Roof Gardens, West India Quay and Jubilee Park, plus five shopping centres, great event venues and more than 20 green spaces to enjoy. There are more than 100 restaurants within a short walking distance bringing an array of tastes to suit every palate.
EASY TO GET AROUND
Stations on both the Jubilee Line and Elizabeth Line are less than 15 minutes’ walk away, taking you to London Bridge and Stratford in 15 minutes or less. The Docklands Light Railway (DLR) is also available for local journeys, with South Quay DLR stop just a sixminute walk away, offering services to Bank, Greenwich and London City airport in under 15 minutes.
For cyclist and pedestrians, Mudchute Park and Farm is close-by and Queen Elizabeth Olympic Park is only 3.5 miles away. And if you fancy being whisked down the river, Thames Clippers’ Uber Boat will take you to Tower and London Bridge City piers in under 20 minutes.
CHANGING FACE OF CANARY WHARF
After beginning as a financial and business district in the 1990s, Canary Wharf has evolved into a city within a city. It was developed on the site of the West India Docks, once the busiest docks in the world. Now, it is a thriving urban hub with a huge selection of cafes, bars, events, exhibitions and home to a thriving arts scene, with great transport links. Alta is unique in every way and it’s not often first time buyers get the opportunity to buy an affordable home in this trendy area of London! Prices TBC.
Register your interest at: latimerhomes.com/new-buildhomes/london/canary-wharf/alta-at-consort-place
AFFORDABLE HOMES 52 First Time Buyer June/July 2023

ENJOY LIFE ON THE SOUTH COAST WITH SOUTHERN HOUSING NEW HOMES

For those looking to make their dream of coastal living a reality, Southern Housing New Homes has a number of affordable opportunities to live in East and West Sussex on the South Coast. From the buzz of Brighton to the more laid-back atmosphere of neighbouring Hove, or the popular port town of Shoreham-bySea, there are sustainable new homes to suit everybody, with the added benefit of regular trains to London taking between 60 and 90 minutes.
In Hove, which is known for its sophisticated independent feel and varied assortment of boutiques, cafes and bars, Grand Avenue provides a number of spacious one and two bedroom seafront apartments with shared ownership, forming a welcoming new seafront community just two minutes’ walk from the beach.

The development is built to the highest standards, ensuring excellent energy efficiency, with light-filled interiors and a fantastic specification throughout, including stylish navy blue fitted kitchens and modern appliances as standard. All homes benefit from a balcony or terrace, as well as landscaped communal gardens. On the doorstep, enjoy a range of amenities with the popular Hove Lawns nearby and Brighton city centre only a seven-minute bike ride away. Incentives are currently available – speak to the sales team to find out more.
Slightly further inland, between the South Downs and the sea in the Moulsecoomb area north of Brighton, Home X is a landmark new development comprising a collection of studio, one, two and three bedroom apartments available through open market sale or shared ownership. In addition to high-quality new homes with energyefficient EPC B ratings, many offering private outdoor space, residents also benefit
Living by the seaside has long been top of the wish list for those considering a great quality of life. It is little surprise, as numerous studies have shown that people who live by the seaside tend to be happier and healthier, with lower levels of stress. Testament to this, a study commissioned by Brighton & Hove City Council revealed that those living in the area benefit from improved mental health, increased recreational activity and a stronger sense of community
from the new community taking shape that includes landscaped outdoor spaces and inspiring flexible workspaces, wellbeing space and forthcoming new amenities.
A few miles to the west in Shorehamon-Sea, Southern Housing New Homes currently has two exciting new shared ownership schemes under development. This popular port town enjoys a rich maritime history and in recent years has undergone significant regeneration to create a vibrant destination for living, working and leisure.
Free Wharf is a stunning new development of one, two and three bedroom apartments. Once known as Shoreham’s commercial port, the location is now a designated regeneration area which will
create a new sense of community. Set on the riverside, some homes will offer views of the River Adur and Shoreham Harbour, but all will benefit from the landscaped communal grounds and range of local amenities and transport links in the surrounding area.
Nearby, Surry Street will provide one and two bedroom apartments. Residents at Surry Street will benefit from high-quality homes, communal roof gardens, beautifully landscaped surroundings, plus parking spaces and secure cycle stores, within easy access to a range of amenities.

Vikki Walker, Director of Sales & Marketing at Southern Housing New Homes adds, “We are pleased to offer a range of developments in East and West Sussex, allowing buyers to enjoy a fantastic quality of life at an affordable price. Our expert team is on hand to guide customers through every step of the journey, making sure you know what costs to expect and offer you support to make an educated decision on what is right for you.”
To find out more about how Southern Housing New Homes can make homeownership a reality for you, please visit shnewhomes.co.uk
AFFORDABLE HOMES 54 First Time Buyer June/July 2023
Free Wharf
Home X
Grand Avenue

SHARED OWNERSHIP IS SET TO BLOOM THIS SEASON


Homeownership could be within reach by the end of summer, with market data showing shared ownership as the best option, says Kevin Sims, Director of Sales and Marketing at SO Resi

With the arrival of the longer and brighter days, the property market is also heating up. This time of year is traditionally a busy time for the housing market, with buyers and sellers alike evaluating their priorities through the summer.
The race on to the property ladder is fuelled by fast-rising rents across the country, as property portal Rightmove reveals that national average asking rents outside of London have hit a new record of £1,172 pcm, with Greater London prices reaching £2,480 pcm for the first time.¹ So, it’s no surprise that first time buyer properties are leading the recovery of the housing market this spring, just 4% behind the same period in 2019.² As more first time buyers look to escape the rental trap and own their own home, shared ownership remains a fantastic option for buyers looking to make the move this spring.
The greatest benefit of shared ownership is that it offers qualifying buyers the chance to make a move right now, with only a fraction of the deposit requirements compared to buying on the private market. This, along with one to two bedroom first time buyer properties leading the recovery of the housing market 3, means that shared ownership is looking to be the best option for those looking to place a foot on the property ladder over the summer and get moving as soon as possible.
At SO Resi, homes available with shared ownership aren’t just limited to “starter” one bedroom apartments. We recognise that first time buyers come in all shapes and sizes, which is why many of our developments offer one to four bedroom properties at a fraction of full market value homes, so first time buyers who are looking for more space have plenty of options.
We understand our buyers’ priorities, which is why our homes are built to stand the test of time, with many including features such as off-road parking, private outdoor space, en suite bathrooms, economical heating systems and open-plan living areas.
1 2 3 rightmove.co.uk/news/house-price-index
SO Resi Farnham: SO Resi Farnham offers a selection of shared ownership apartments in the desirable town of Farnham, Surrey. Conveniently located in central Farnham, the development is within walking distance of Brightwells Yard, a 25-unit shopping centre and cinema, with parks, shops, bars and restaurants on residents’ doorsteps. The development is incredibly friendly for pedestrians, with walking routes throughout, alongside a green border and riverside walk. Prices start from £67,500 for a 25% share of a one bedroom apartment. soresi.co.uk/find-a-property/so-resi-farnham/
SO Resi Bracknell: Located in the heart of Berkshire, almost a billion pounds has been invested in the Bracknell Forest regeneration scheme, which means amenities and transport links are plentiful for residents here. The development is less than a 10-minute walk to Bracknell railway station, which offers services to Richmond, Clapham Junction and London Waterloo all within an hour. Prices start from £73,500 for a 30% share of a one bedroom apartment with a full market value £245,000, requiring just a £3,675 deposit.
soresi.co.uk/find-a-property/so-resi-bracknell/
SO Resi Welwyn Garden City: This development in the exciting Welwyn Garden City is surrounded by rolling green hills for late summer walks and landscaped on-site gardens for residents to relax in.
All two bedroom apartments also include an en suite, as well as allocated parking as standard. You can buy a 25% share of a one bedroom apartment for £71,875 with just over a £3,500 deposit, and a combined monthly cost of £1,509 – comparable with similar rental properties in the area. The full market value is £287,500.
soresi.co.uk/find-a-property/so-resi-welwyngarden-city/

SHARED OWNERSHIP 56 First Time Buyer June/July 2023
SO Resi Farnham
SO Resi Welwyn Garden City
SO Resi Bracknell

WELCOME TO THE ELMS
In the vibrant north west suburb of Harrow, these modern shared ownership apartments are a brilliant choice for first time buyers. Ticking all the boxes for quality, convenience, transport links and proximity to green spaces, this outstanding development from Octavia provides the perfect place for contemporary city living
If you’re looking for modern, highquality shared ownership apartments in Harrow, you’ll be excited to hear about The Elms. Built around a central courtyard, this stylish collection of 20 one and two bedroom shared ownership apartments, developed by Octavia, boasts an exceptional range of amenities, with prices starting from just £86,875.
The development’s outstanding location on Elmgrove Road means that The Elms is just a short walk away from Harrow on the Hill’s bustling shopping centres, cafes and restaurants.
Each apartment is beautifully finished with luxury vinyl flooring in the main living areas and hallways, carpets in the bedrooms, and contemporary tiled bathrooms with chrome towel radiators and white bathroom suites. Striking kitchens feature a range of Zanussi integrated appliances, fridge-freezer, dishwasher, ceramic hob, oven and washer-dryer. Moreover, some two bedroom apartments feature en suite shower rooms, while all apartments come with their own private outdoor space in the form of a balcony or terrace. The development is also walking distance to both Harrow-on-the-Hill and Harrow & Wealdstone stations, boasting quick connections into central London.
Furthermore, residents of The Elms can indulge in a wide range of activities to suit their tastes. Retail therapy is just a stone’s throw away, with both St Ann’s and St George’s shopping centres within close proximity, offering a range of high street and independent boutiques to explore. The development is also close to Kenton Park and Harrow Leisure Centre, which offers activities like a high climbing wall, swimming pool, and gym. Meanwhile, foodies can indulge in the Wealdstone High Street’s wide range of restaurants
and cafes. You’re just a short journey from Wembley, where the redevelopment around the stadium has created a wide range of shopping experiences, including the London Designer Outlet.
The Elms is also well connected, with Harrow-on-the-Hill and Harrow & Wealdstone stations just a 10-minute walk away. The development is only 11 miles away from central London and surrounded by excellent transport links, making commuting to the city or further afield a breeze, with trains reaching Euston in just 12 minutes and Bank in 35 minutes from nearby Harrow & Wealdstone station (Bakerloo Line, Overground & West Midlands Trains).
Lastly, The Elms is an excellent opportunity for first time buyers looking to put down roots and be part of a vibrant
new community. This is the ideal base for anyone who works locally or in the centre of London. And for those who love the countryside, you’re never too far away from a great escape.
Prices at The Elms start from just £86,875 for a 25% share of £347,500 for a one bedroom shared ownership apartment, while two bedroom apartments start from £118,125 for a 25% share based on the full market value of £472,500.


Overall, The Elms is an outstanding development, offering everything one could need and more for contemporary city living.
For more information about The Elms, or to book a private appointment, please visit the website octavialiving.org.uk or call us on 020 8354 5500
AFFORDABLE HOMES 58 First Time Buyer June/July 2023

DEMAND SOARS AT CITY & COUNTRY’S HISTORIC CONVERSION & NEW BUILD APARTMENTS

Located in the vibrant Bedminster district of Bristol, City & Country’s Factory No.1 development is proving a popular choice for first time buyers, who currently make up over 60% of purchasers
Once the site of Imperial Tobacco Company’s headquarters, stylish new homes are now being meticulously crafted from the former factory’s historic buildings, alongside five new apartment buildings. There is currently a range of one and two bedroom new and conversion apartments available at Factory No.1, set around beautiful courtyard gardens – offering a private oasis for residents in the heart of the city.
A LUXURY DEVELOPMENT
Originally designed by Sir Frank Wills, the Edwardian-Baroque style of the restored buildings is one of the most distinctive in Bristol.
Exclusivity is key at this gated development, where residents enjoy security, access to private landscaped gardens, and an on-site concierge service.

The individually designed homes benefit from ultrafast broadband and a high specification, including smart thermostats as well as integrated SMEG appliances in the kitchen – including the oven, induction hob, fridge-freezer and more.
Alex Winn, a first time buyer at Factory No.1, commented, “Anything with this quality that I had looked at before was much further out of Bristol. The finish of the homes City & Country has created here is exceptional – my one bedroom flat is a huge space and the ceilings and large windows make it feel so spacious.”
Conversion apartments in The Directors’ Wing, set within Regent House, have recently launched with a remarkable show home ready to view now. Many of the homes include beautifully restored original

features such as oak panelling, alongside floor-to-ceiling windows, intricate ornate ceilings and statement fireplaces. For those who prefer new build, the Cutting Room apartments have been released ahead of schedule due to incredible demand, comprising 42 stylish homes across nine storeys with floor-to-ceiling windows offering spectacular views over the city skyline. Two new show homes are opening in the coming month.
A total of 284 converted and newly built apartments are available at this landmark development, which features the sensitively restored, elegant facades of Consort and Regent House. Located off East Street, a short walk from Bristol Temple Meads railway station and the city centre, this development is perfectly placed, and provides a great opportunity to invest in one of Bristol’s most up-and-coming areas.1
DEVELOPER’S VIEW
Jennifer Rhodes-Finch, Head of Marketing for City & Country, said, “The restoration of this historic site has really revitalised the local area and will be enjoyed by residents for years to come. Around 100 of the 284 homes at Factory No.1 are newly completed and occupied, and with the majority of purchasers being owneroccupiers, there is a brilliant community emerging within the development.”
Simon Vernon-Harcourt, Design and Planning Director for City & Country, added, “Factory No.1 continues to play a significant role in the ever-changing area of Bedminster.
Once leading the way for the industrial revolution, it is now playing a role in making the area the best new place to live.”
Prices start from £265,000* for a one bedroom apartment, while two bedroom homes are priced from £350,000* with selected plots benefiting from allocated parking. A 5% deposit contribution worth up to £22,750** is available on selected homes. The new Deposit Unlock initiative is also available on selected apartments, allowing buyers to purchase a new home with just a 5% deposit.
The Factory No.1 sales suite is open daily from 10am to 5pm, located at East Street, Bedminster, Bristol BS3 4HH. For more information, call 01174 535 135 or visit cityandcountry.co.uk
*Prices correct at time of publication and subject to change. **Terms and conditions apply – see cityandcountry.co.uk for full details
1bristolworld.com/news/the-most-up-and-coming-areas-inbristol-4038528
AFFORDABLE HOMES 60 First Time Buyer June/July 2023

START YOUR SHARED OWNERSHIP JOURNEY IN EDGWARE AND BURNT OAK WITH NETWORK HOMES
Boasting connectivity, culture, and calming green spaces, Edgware and Burnt Oak are fantastic locations for London’s homebuyers. As well as easy connections to London’s most famous shopping streets, each has its own hotspots perfect for a bit of retail therapy. Broadway Shopping Centre is home to a wide assortment of popular high street chains, while Burnt Oak Broadway is also home to a range of shops, cafes and restaurants. Reflecting the area’s diversity, Edgware offers residents a chance to take their tastebuds on a world tour without travelling far from home
Providing exceptional transport links, Burnt Oak and Edgware stations provide links to Euston in as little as 22 and 24 minutes respectively on the Northern Line. Bus services provide easy links to destinations such as Harrow, Wembley and Kilburn, as well as night services towards Trafalgar Square and Victoria. For a breath of fresh air, green space is also abundant, with Edgwarebury Park, Silk Stream Park and Stonegrove Park all close by. Canons Park offers an extensive 45 acres to explore, complete with a children’s play area, idyllic ponds brimming with wildlife and plenty of shaded woodland for gentle walks or morning runs.
For those looking to take their first steps on to the property ladder, Network Homes’ latest collections at ICON at Burnt Oak and Edgware Parade provide two promising opportunities that are certain to impress.
ICONIC LONDON LIVING
Located in Edgware’s Burnt Oak community, Network Homes’ trendsetting new development, ICON, offers a stunning collection of homes ranging from one
bedroom apartments to three bedroom duplexes. Showcasing the architectural prowess of two award-winning architects, DRMM Architects and Frederick Gibberd Architects, ICON is set to become a new landmark location on the skyline.

For a luxury look, ICON features a premium specification and high-quality finish throughout. Open-plan living spaces, complete with soft tones, allow buyers to personalise the space to reflect their unique sense of style. Kitchens boast contemporary units, brushed-steel-finish integrated appliances, and complimentary worktops and upstands, perfect for budding chefs and bakers. After a long day exploring Edgware, bedrooms are a welcome retreat complete with calming downlighting, built-in wardrobes and plush wool-mix carpeting. Primary bedrooms to selected homes also benefit from the added luxury of a contemporary en suite shower room in addition to the home’s main bathroom suite.
Creating a charming new community where people want to live, work and play, ICON is bursting with gorgeous green spaces. A spacious courtyard garden enjoys naturalistic inspired planting and forms a

tranquil haven for residents to unwind. For those looking to socialise with neighbours, a first-floor roof terrace hosts a play area for children. Homes also benefit from private projecting balconies, providing space for buyers to create their own serene sanctuary. In addition to the homes, ICON features new commercial space, which will provide an extension to the existing high street to support new jobs and local businesses.
EXHIBITING EDGWARE’S ELEGANCE
Alternatively, buyers looking for a home in the heart of Edgware need look no further than Edgware Parade. Occupying a prime position in the centre of town, Edgware Parade is conveniently just moments from assorted restaurants, cafes, shops and leisure facilities, while exceptional transport links provide easy access to everything London living has to offer.
Set across four distinct blocks ranging four to 17 storeys, homes at Edgware Parade provide contemporary living alongside spectacular views across south London. Centred around a spacious and landscaped podium garden, the development hosts new green spaces for children to play and neighbours to meet and socialise. Complementing the abundant green space on offer in Edgware and the idyllic country surroundings, private balconies provide further outdoor space to enjoy. Parking spaces to selected properties and cycle storage on site make getting out and about a breeze.
Discover Edgware living at networkhomessales.co.uk
AFFORDABLE HOMES 62 First Time Buyer June/July 2023
ICON
Edgware Parade

CONTEMPORARY HOMES, DESIRABLE COMMUNITIES
Places for People started more than 50 years ago and today we’re building and managing happy, healthy and inclusive communities up and down the UK
Our spacious and high-specification homes are designed to adapt to your unique lifestyle, both now and into the future, while our thriving and wellconnected communities offer everything you could want on your doorstep. What’s more, when you buy new with us you can look forward to all the benefits of an energy and cost-efficient home without having to compromise on comfort or quality.
And with our 10-year insurance-backed warranty, you can move in with peace of mind.
MODERN COUNTRY HOMES IN ATTLEBOROUGH, NORFOLK
If you’re looking for a high-quality home in an idyllic location, White House Park in Attleborough, Norfolk, has everything you need and more. Not only will you be able to access all the amenities of a bustling market town; you will be surrounded by Norfolk’s beautiful, unspoiled rural landscape – the ideal backdrop to modern country living. Choose from a selection of two and three bedroom terraced and semi-detached homes, all available to buy through the Government-backed shared ownership scheme. The Lemongrass fitted kitchen and dining area is a real showstopper, featuring an integrated oven, fridge-freezer and washing machine along with soft close
COMING SOON…
More brand new homes will soon be available at our popular Carvers Meadow development, also located near Attleborough in Norfolk. The contemporary two and three bedroom houses benefit from generous living space, an open-plan kitchen and dining area, and that allimportant car parking.
Modern country living is also coming to a development in the village of Gosfield in Essex, where a selection of two and three bedroom homes offers the dual appeal of attractive rural surroundings and good local amenities in the neighbouring market town of Halstead.

All the homes are available to buy through shared ownership.
doors and drawers. A separate, sizeable lounge opens through French doors on to a turfed rear garden, complete with clothes drying area.
You will be pleased to know that each property comes with space for parking, while this attractive development also includes attractive landscaping, a play area and even a sustainable pond.
THE PERFECT MIX OF TOWN AND COUNTRY
Attleborough itself offers a good mix of independent and high street shops along with a wonderful choice of cafes, pubs and restaurants – its Thursday Charter market held in the town’s pretty focal point of Queen’s Square has been a regular feature since 1226!
The stunning Norfolk countryside and coastline are just waiting to be explored, while for families, excellent community facilities along with a good selection of local schools make White House Park the ideal place to put down roots. Getting around couldn’t be easier, with excellent connections to Cambridge and London as well as the neighbouring medieval city of Norwich.
MOVE INTO YOUR DREAM HOME WITH SHARED OWNERSHIP*
With shared ownership, you could be enjoying your brand new Places for People

home sooner than you think. The scheme works through buying a percentage share of your home (between 25% and 75%) and paying rent on the rest. Even better, your deposit only needs to be 5% of the share you buy (not of the full property value) while your monthly mortgage repayments will be smaller too. There is also the flexibility to increase your share in the future, should you choose to. It’s a simple yet cost-effective way of owning your home.
DISCOVER MORE
Register your interest for our brand new homes today and find out if you qualify for shared ownership.
Visit placesforpeople.co.uk/find-a-home *Terms and conditions apply
AFFORDABLE HOMES
64 First Time Buyer June/July 2023


MAKE YOUR FUTURE HOME A SNUGG HOME
WHY SNUGG HOMES?
Snugg Homes has a long and successful reputation for building high-quality homes throughout the North West and East Midlands. From the rolling hills of Ribble Valley and the Peak District, to the leafy suburbs of Cheshire and Nottinghamshire, and the vibrant cities of Manchester and Preston, Snugg Homes has the perfect property in a location to suit you.
Our experienced property sales team will make sure your journey to homeownership is as smooth as possible. They will be with you every step of the way; from the moment you find your dream home, to the moment you pick up your keys.
Many of our stunning properties have been recognised nationally at prestigious housing awards. Our Edge View scheme in the Yorkshire Dales was crowned “Best Shared Ownership Development” and Rowan Wood in Longridge has been shortlisted for the First Time Buyer Award’s Best North West Development. Snugg Homes’ impressive catalogue of award-winning schemes proves that our properties are made to the highest standard so homeowners can thrive in their homes.

WHAT IS SHARED OWNERSHIP?
Shared ownership is the perfect alternative for you if you can’t quite afford to purchase 100% of a home.
With shared ownership you can buy
BUT DON’T JUST TAKE OUR WORD FOR IT...
a share of the property (between 10% to 80% of the home’s full market value) and pay affordable rent on the remaining percentage share. When your finances allow, you can purchase more shares up to 100% of the home through staircasing; the more shares you own, the less rent you pay.
The shared ownership scheme is open to anyone aged 18 or over with a total household income of less than £80,000. To be eligible, you must simply meet the specified criteria and not own another home or have an agreed sale on your home.
BUSTING THE SHARED OWNERSHIP MYTHS
There are many misconceptions about shared ownership homes, but it is important to set the record straight and debunk some of the common misunderstandings.
“Rising house prices were making it harder to purchase a property outright, and it was becoming a seemingly impossible dream, until I came across Snugg Homes on Google while looking at housing associations in my area.
“I sent an email to Snugg Homes and its answers to my questions explained the whole shared ownership process and I now own a 75% share of a beautiful three bedroom home! I’m so happy to have my independence back, more space, and the peace to look after my own home.

“My experience with Snugg Homes was amazing. The service was super fast and all my questions were answered when I needed them. I would highly recommend Snugg Homes to anyone hoping to purchase their own home.”
own home
Some people believe that shared ownership means you will be sharing your home with someone else. This is not true –only you and your family will be living in the house as it is not a house-share scheme. While you initially purchase a share in your home, the remaining share will be owned by your housing provider, and you pay rent on their share.
Another common myth is that you won’t be able to decorate or carry out any DIY on your shared ownership home. As a shared owner, you have the right to decorate your home as you wish. However, for any structural improvements such as fitting a new kitchen or bathroom, you will need written consent from the leaseholder. Many also believe that through shared ownership, you will never be able to fully own your home. You can buy 100% of most shared ownership homes by staircasing in the future. Although, if the home you wish to purchase is in a Designated Protected Area, the share you can own may be restricted to 80%. However, if this is the case, it will be highlighted in the Key Information Documents.
A HELPING HAND
The Snugg Homes team is always on hand to answer any questions about shared ownership or advise you on any of our spectacular schemes.
For more information, please visit our website snugghomes.co.uk. You can also follow us on @SnuggHomes on Twitter or @snugghomes on Instagram and TikTok
AFFORDABLE HOMES 66 First Time Buyer June/July 2023
Rowan Wood
Getting on to the property ladder has been made easier thanks to the shared ownership scheme – and specialist Snugg Homes can help you take that first step towards owning your
New homeowner Kelly Butler of Alexandra Gardens, Crewe

MAKERS YARD, E16, IS THE PLACE TO CALL HOME
Makers Yard, E16, offers an exciting new build collection of one, two and three bedroom apartments and two and three bedroom duplexes for shared ownership, with a small selection coming soon for shared equity
Split across two blocks and surrounding landscaped communal gardens, the 245 homes will be available to move in from summer 2023. Developed by One Housing, part of Riverside, each apartment includes a high-quality specification throughout, with Bosch kitchen appliances, spacious living areas and private outside space in the form of a balcony or terrace.
LIVING AT HALLSVILLE QUARTER
Canning Town has seen much regeneration in recent years and now finds itself home to several new shops, bars, restaurants, a hotel, gym, cinema and amenities. Part of the larger new £600m town centre of Hallsville Quarter, Makers Yard is at the heart of an exciting future, transforming the historic London Docklands. The overall £3.7bn regeneration is producing one of London’s most exciting districts to live in.
With new independent bars, shops and restaurants opening in Hallsville Quarter, you don’t have to venture far to support your local community and transform the small businesses of today into the trailblazers of tomorrow.
Due to this regeneration, property prices in Canning town are expected to rise by 9%* in the next two years, meaning buying your new home at Makers Yard is not just investing in your new home but your future too.

TRANSPORT
Perfectly located on the doorstep to Canning Town station (on the DLR and Jubilee Line) which offers a five-minute commute to Canary Wharf and Stratford, while The City, London Bridge and Westminster can all be reached in 15 minutes or less. London City airport is only six minutes via the DLR, allowing connections to Paris, Amsterdam, Munich and much more.
The long-awaited Elizabeth Line at Custom House now offers fast connections to central London, the West End and beyond to Heathrow. Located less than a mile walk from Makers Yard, the travel connections are endless.
WHY BUY NEW?
With energy prices soaring, buying a new build home can save you up to £3,000 on your energy bills a year in comparison to buying a secondhand property. Most new build homes come with a EPC rating of B or above, meaning they are also much more efficient to run, with high-quality insulation, windows and appliances.
The homes at Makers Yard are covered by the NHBC warranty, giving you a 10year guarantee for any building issues. All the apartments come with a range of brand new appliances, offering an additional peace of mind.
SHARED OWNERSHIP
The shared ownership scheme allows you to purchase a percentage of the full market value while paying a subsidised rent on the remainder**. For example, at Maker’s Yard you will be able to purchase between 25% to 75% at the beginning. You will have the opportunity to buy further shares in your property later, and eventually staircase to 100% ownership.

WHY BUY WITH SHARED OWNERSHIP?
9 The monthly payments are generally lower than if you were to rent privately in the area
9 You have the opportunity to get on to the property ladder for less, offering long-term stability without stretching yourself financially
9 Your deposit will be lower than purchasing on the outright sale market
9 You are able to sell your share at any time
9 You have the option to buy more shares in your home via a process that is known as staircasing.
Our stunning show home is now available to view by appointment only Tuesday to Saturday from 10am to 5pm.
One, two and three bedroom apartments are currently available at Makers Yard from £90,500 for a 25% share (full market value of £362,000).

We are due to release phase 2 to the market this summer, which will consist of a further collection of one, two and three bedroom apartments and duplexes.
For more information contact the SiteSales team on 0344 892 0124 or makersyard-e16.co.uk
*Please get in touch for reference to report **T&Cs apply, speak to a member of the sales team for more information
AFFORDABLE HOMES 68 First Time Buyer June/July 2023

Raymond Wardle, 31, and Mark Wardle, 51, had been living abroad for years, travelling around the Middle East with Mark’s job as a DJ. In March 2020, the couple came back from Bahrain for a short holiday in England, but ended up stuck in the country as the Covid-19 lockdown hit the UK. Unable to travel and trapped living in a friend’s spare room, Raymond and Mark decided they needed to find a permanent place of their own
Mark said, “My best friend lives in Newhaven, East Sussex, and we had asked to stay with him for three nights while we were visiting the UK. Lockdown hit and all our plans were put on hold – we ended up living in his tiny spare bedroom for two years and three months. It was a single room, and there was barely enough space for a bed. We slept on an airbed for a few months, and then eventually bought a double bed and a desk. There wasn’t even enough space in there for the two of us to stand up at one time. It started to really impact our relationship.”
Desperate for their own space, Raymond and Mark began looking to buy a property. Mark continued, “We started looking for somewhere to live quite quickly, but Raymond couldn’t get a job straight away because he didn’t have a visa. Once lockdown eased, I began working in a restaurant, but most of my earnings were going on Raymond’s visa. We were looking for homes on the open market, but they were all well outside of our price range. There was only ever about one house a month that came on the market within our budget, but we couldn’t even get a look in. It would always disappear straight away.”

Running out of options, Raymond explains how one of their friends pointed out new homes from Guinness Homes. He said, “In the second year of living in the spare bedroom, one of our friends told us about a new development from Guinness Homes, just 10 minutes down the road. Immediately we thought there was no way we’d be able to afford it – I assumed it would be totally out of our price range and we’d be wasting our time. Nonetheless, we decided to book an appointment and have a look around anyway. We opened the door, and fell totally in love.”
Mark, a customer care assistant,

Open market: Newhaven, East Sussex
and Raymond, a finance administrator, purchased a three bedroom house at August Fields by Guinness Homes for £367,500. “The house was beautiful. The open-plan kitchen/dining room, the en suite, the garden, the spacious hallway, how light the whole place was – we loved everything. I’d heard some negative things about developers and service charges, so I went online and tried to find bad things about Guinness – and I just couldn’t! My research just brought up positive reviews, so we felt very reassured.
“There’s another development nearby from a different developer, and you don’t get any of the add-ons included with the house – things like a fridge, washing


FACT FILE
Property: Three bedroom semi-detached house
Purchase price: £367,500
Mortgage: £801 per month

Service Charge: £38 per month
Bills: £398 per month approximately (water, gas, electricity and council tax)


machine and dishwasher all must be bought as extras... even the carpet! At August Fields everything is included – we were given the keys on move-in day and walked into a fully fitted home.”
Now settled in their new home, Mark and Raymond are enjoying decorating the home and are already beginning to look to the future. “It hasn’t really hit me that it’s ours yet. This is actually our home, and we own it. We’re so happy to be here. The house gets more beautiful every day because we can’t stop buying new furnishings and accessories! Raymond has a real eye for design, so the whole place has been decorated brilliantly. The neighbourhood is also lovely – all of our new neighbours are so friendly, so we’re really happy here.
“Having gone from a tiny single bedroom to this huge three bedroom house, we have more space than we know what to do with! As we have extra rooms, we plan to get a tenant in the future and that will also help us with repayments. All in all, we’ve been very lucky. We’re so excited to be here.”
REAL LIFE 70 First Time Buyer June/July 2023
“WE DECIDED TO BOOK AN APPOINTMENT AND HAVE A LOOK AROUND ANYWAY. WE OPENED THE DOOR, AND FELL TOTALLY IN LOVE”
THE CREAM OF THE CROP FOR SALE
Each month, FTB scours the market for the best starter homes for rst time buyers. So, whether you’re searching for your rst home in the capital or a pretty property at a perfect price, we hope you will enjoy our selection





Open market p70






FIRST CHOICE
EASTERN PROMISE
Affordable homes p72-73








FIRST CHOICE




BEST OF BOTH
City style p74-75





FOR SALE First Time Buyer June/July 2023 71
REAL LIFE
ROYAL DOCKS, EAST LONDON LIVERPOOL, MERSEYSIDE
★★★
★★★
AFFORDABLE HOMES



FROM £79,375*
EASTERN PROMISE

Indigo House at Royal Albert Wharf

Indigo House is the latest addition of apartments at this landmark development. Just a few miles east of Canary Wharf, and with inspiring views in all directions, these waterside homes occupy a prime position. The one, two and three bedroom apartments are bordered by the Thames, Royal Albert Wharf and Royal Albert Basin, and with a great range of cafes, workspaces and bars within seconds from the front door, are ideal for professionals working in the city, from home, or both. Getting around the capital is easy, too – Gallions Reach DLR is a ve-minute walk away.

Notting Hill Genesis 020 3944 8054 nhgsales.com
*Based on a 25% share of the full market value of £317,500





FOR SALE 72 First Time Buyer June/July 2023
ROYAL DOCKS, EAST LONDON
★★★ FIRST CHOICE
BROMLEY-BY-BOW, EAST LONDON
Leaside Lock
London E3 has fantastic links into central London and a host of trendy locales on the doorstep. Leaside Lock sits on the banks of the River Lea, with a range of studio, one, two and three bedroom apartments available, along with communal courtyard gardens, co-working spaces, on-site shops and leisure facilities.
The apartments feature well-sized living spaces with separate utility rooms and private outdoor space. The development forms part of a wider revival that will see new green spaces, river walkways and cycle and pedestrian bridges.
Guinness Homes 020 8131 6456 leasidelock.com


*Based on a 25% share of the full market value of £400,000
BRENTWOOD, EAST LONDON
1023 West

Set within landscaped grounds, residents at this new development can enjoy attractive gardens as their daily backdrop. The collection of one and two bedroom apartments is less than half a mile from Brentwood town centre and has been created with modern living in mind: open-plan living areas lead to private balconies;
kitchens are contemporary and windows are sized for optimal light. Residents also have allocated parking. Those who live or work in Brentwood and surrounding areas may be eligible for a 20% Discount Market Value price.

Weston Homes 01277 885 947 weston-homes.com
ERITH, SOUTH EAST LONDON
The Quarry
Created on a former quarry, this new collection of one and two bedroom apartments and three and four bedroom terraced houses is proving popular. The homes have open-plan living spaces, en suite bathrooms in the larger properties and plenty of storage. There’s private outdoor space in the form of terraces,


SOUTH QUAY, EAST LONDON
balconies or gardens. The development is close to gyms, shops and parks. From Erith station (a 10-minute walk), trains to London Bridge take under 40 minutes. Meanwhile, the River Thames is a 15-minute stroll.
L&Q 0333 003 3737 lqhomes.com









Hampton Tower at South Quay
Floor-to-ceiling windows throughout Hampton Tower’s one bedroom apartments allow for spectacular views out to Canary Wharf and South Dock. As well as impressive vistas, the properties also enjoy great commuting links (it’s a two-minute walk to South Quay DLR), a plethora of dining and entertainment opportunities on

the doorstep and 2.6 acres of communal gardens to explore. The homes are perfectly located for getting around the city, either by DLR, tube or boat, and offer an ideal, luxury retreat in a sought-after part of the capital.
Legal & General Homes 0808 115 0793 landgah.com
FROM £69,000* FROM £132,500* *Based on a 25% share of the full market value of £276,000 Based on a 25% share of the full market value of £530,000
FOR SALE First Time Buyer June/July 2023 73
FROM £100,000* FROM £250,000* *Price includes 20% Discount Market Sale reduction
COUNTRY CONNECTIONS

BEST OF BOTH
The Finches at Hilton Grange

Nestled on the edges of the thriving city of Liverpool, the family homes at The Finches are ideally located for striking that perfect city/country balance. The three and four bedroom houses have been created in awardwinning style, re ecting late 19th and early 20th century property styling. The homes are bright and spacious, with open-plan living/dining rooms, separate living room, downstairs WC and well-proportioned bedrooms upstairs. Liverpool city centre – with its wide-ranging offering of cultural delights – is around 25 minutes away by both road or rail.
Redrow 01513 919 253 redrow.co.uk









FOR SALE 74 First Time Buyer June/July 2023
MERSEYSIDE
LIVERPOOL,
★★★
FIRST CHOICE FROM £299,995
Goodsyard




The picturesque market town of Bishop’s Stortford in Hertfordshire is home to this new collection of properties that offers a balance of stunning surroundings and excellent commuter links into the capital. The one, two and three bedroom apartments occupy an ideal spot alongside the canal, close to the railway station and
St Mary’s Garden Village
Just a mile from the stunning town centre of Ross-on-Wye, residents at this new development will have no shortage of beauty right on the doorstep. The surrounds are simply stunning, with rolling hills meeting the sweeping river, which passes through the medieval market town. There are a number of three and four bedroom houses for sale here,
all the amenities that the town has to offer. Rolling countryside lies just a few minutes’ drive away for endless outdoor adventures. Meanwhile, trains take just 40 minutes to reach London Liverpool Street.
Sage Homes 020 8168 0300 sagehomes.co.uk
FROM £81,875* FROM £299,995*


Hampton Water
Just a few three bedroom houses remain at this pretty development on the southern edge of Peterborough. The popular collection of properties sits surrounded by a country park and lakes and offers a serene environment. The houses feature separate kitchen/dining and living rooms and downstairs WC, along
with several available through shared ownership. The homes feature an en suite from the main bedroom as well as a downstairs WC, while the open-plan living/ dining rooms open on to private rear gardens.




Edenstone Homes 01291 674 800 edenstonehomes.com


Wild Walk
Residents at this new development just outside Telford are encouraged to take a walk on the wild side and keep sustainability at heart. Not only does it boast excellent green credentials, but it sits next door to sprawling Granville Country Park, one of the most wildlife-rich areas in Telford. For everyday life, the local area is
with three well-sized bedrooms upstairs. Peterborough’s city centre is four miles away and boasts a good range of amenities, while trains from Peterborough reach London’s Kings Cross in as little as 50 minutes.
Barratt Homes 0371 454 3593 barratthomes.co.uk
FROM £284,995 FROM £250,000
home to a great choice of shops and cafes, while pretty Telford is a 10-minute drive for day trips and entertainment. The properties range from two to four bedroom houses in a range of styles, and are perfect for family life.
Lovell 01952 924 401 lovell.co.uk




FOR SALE First Time Buyer June/July 2023 75
BISHOP’S STORTFORD, HERTFORDSHIRE
PETERBOROUGH, CAMBRIDGESHIRE
ROSS-ON-WYE
TELFORD, SHROPSHIRE
*Based on a 25% share of the full market value of £327,500













































Shortlist Revealed Vote at ftbawards.com VOTE NOW!
take our readers very seriously and want to know your views as first time buyers. That’s why we need you to vote for your favourite developments, housing providers and other categories, listed on the following pages, in our First Time Buyer Readers’ Awards 2023. For more details, see page 99
We
Best Sma Dev opment


SETTLE | IVELDALE DRIVE

Iveldale Drive offered 10 beautiful two, three and four bedroom homes, a development consisting only of shared ownership properties, with each home designed with comfort, convenience and style in mind. All homes complemented the local landscape; featuring a traditional exterior finish with varying styles of brickwork, rendering, cladding and windows, with an environmentally friendly timber frame. The interior of the homes offered modern design and quality for all the contemporary family’s needs. The 10 new homes on the development offered privacy, which appealed to the target market who were all looking for a local “forever” home. The site had previously been used as a health centre, but this was replaced in 2012 with a new health centre, the building became derelict and the site was left unloved. In purchasing the land in 2021, settle made a commitment to ensure local people had the opportunity to purchase brand new affordable homes through shared ownership.
PLUMLIFE HOMES | MABEL GARDENS

Plumlife is delighted to present Mabel Gardens in Lancaster. The development includes a contemporary collection of 14 homes which were made available to purchase through shared ownership at the end of 2022. Mabel Gardens is an ideal place for people who are looking to reside just outside of the city centre in a beautiful new home. A majority of buyers at Mabel Gardens are from the local area, proving that these affordable shared ownership homes have helped community members step on to the property ladder. Plumlife researched into demographics and demand within the local area and as a result, Mabel Gardens is offering a mix of homes ideal for families and those looking to downsize or own a smaller property, which was the identified target market. Each contemporary home is energy efficient, considering future ambitions for net zero while ensuring residents can save money on their bills.



PEABODY | ABBEY CORNER
A small development having a big impact on the Colchester property scene, Abbey Corner is a collection of 25 two and three bedroom family homes set in a soughtafter area where homeownership has decreased over the past two years, according to the Government Census. Available exclusively through shared ownership, the development by Peabody offers truly extraordinary properties for first time buyer families looking to find their forever home in the quintessential English town. Designed by Hunters Architects, the development is built around traditional family friendly street scenes, interspersed with pockets of landscaped greenery featuring native flowers, trees and shrubs. A natural extension of the local community, Abbey Corner marries green space with Colchester’s distinctive character and architectural language, taking its identity from the surrounding area. Available in an impressive five different layouts and designs, from traditional two bedroom houses to threestorey homes with multiple parking spaces, Abbey Corner offers a unique mix of housing to create the true community feel families seek.
78 First Time Buyer June/July 2023 READERS’ AWARDS buyer
THIS AWARD WILL BE GIVEN TO SMALL DEVELOPMENTS THAT HAVE USED THE BEST DESIGN AND QUALITY TO CREATE DESIRABLE, AFFORDABLE AND INSPIRING ENVIRONMENTS IN WHICH PEOPLE WISH TO SET UP THEIR FIRST HOME. THE AWARD IS FOR SCHEMES OF FEWER THAN 30 HOMES.
Sponsored by
Best Use of Online T ls

THIS AWARD CATEGORY CELEBRATES THE INTEGRATION OF TECHNOLOGY WITHIN THE HOUSING MARKET. THIS AWARD LOOKS AT HOW A SCHEME OR DEVELOPMENT HAS ENGAGED WITH TECHNOLOGY, MAKING ACCESS OF INFORMATION EASIER FOR FIRST TIME BUYERS. THIS INCLUDES THE USE OF ONLINE VIEWING TOOLS, VIDEO FOOTAGE, AS WELL AS WEBSITES, DIGITAL MARKETING AND DIGITAL BROCHURES.

NOTTING HILL GENESIS | ASPECT CROYDON



Set across a leafy 20.9-hectare site, Beauchamp Park is a major new residential neighbourhood in Warwick, which will see housing association L&Q deliver 450 homes, new public open space, footpaths and cycleways, and children’s play areas in the heart of the beautiful English countryside. The first launch of the development took place in November 2021, at a time when many Covid restrictions were still in place. It was crucial that the sales and marketing strategy for Beauchamp Park reflected the new hybrid-digital world, and made use of pioneering new online tools. From a state-ofthe-art application installed on a large touchscreen in the marketing suite, to virtually furnished CGI tours and an extensive series of Matterport tours, the digital tools allow for a seamless customer journey that not only reaches the growing database, but also sets a benchmark for L&Q’s future developments in the area.
At Aspect Croydon in south London, Notting Hill Genesis’ use of innovative and dynamic technology is transforming the way first time buyers view homes, providing them with the confidence to buy off-plan and driving huge early demand. Engaging visual tools enhance the traditional homebuying experience – Aspect’s interactive viewing platform is easily navigable, with 360° virtual tours, 3D floor plans, crisp CGIs and a detailed search filter. This platform smoothly integrates with tablets in the development’s marketing suite. Scannable QR code hotspots throughout the development also offer visitors a sales-led augmented reality experience, revealing a digital replica of an actual furnished apartment. Empowering buyers to make the best decision, a concise website and detailed digital brochure are packed with key information such as specifications, buyer case studies, and stepby-step walkthroughs of shared ownership. A bespoke shared ownership calculator also matches customers to developments based on their deposit saved and other requirements.
In today’s fast-paced world, we expect immediate gratification, making it more important than ever for businesses to find innovative and effective tools to engage with customers. The digisuite™ platform and smart speaker integration within our sales environment at Sage Homes’ Uplands Park development is the perfect example of this. First time buyers are time-poor and expect to have all of the information readily available. Overall, it comes down to convenience. The digisuite™ platform invites customers to take an immersive tour of their future home at Uplands Park, discover local amenities, and explore the development all from the marketing suite during their sales appointment, or comfort of their home on their mobile devices. The smart speaker addition adds to the appointment experience, offering a new level of interactivity and convenience within the sales environment, with the strategically placed speakers providing a unique and immersive experience for prospective buyers.
How do you attract tech-savvy first time buyers in a saturated market? In 2022, Spitfire Homes became the first UK housebuilder to launch a show home and customer suite in the metaverse. Going further than the widely used virtual tour, it gives customers a first-of-its-kind fully immersive experience inside Spitfire’s new house type range, built in the metaverse, from anywhere. A sales consultant “meets” you in the customer suite before “walking” you around the metaverse show home, demonstrating its key features, highlighting Spitfire’s signature attention to detail and answering any questions. A social, personal and engaging one-on-one experience, it makes purchasing a new home off-plan easier to visualise for prospective buyers. Backing up its metaverse experience, Spitfire has created a series of CGI virtual tours for its new house type range, helping a broad range of buyers explore the cut-above properties before a spade goes in the ground.


First Time Buyer June/July 2023 79 READERS’ AWARDS buyer
SAGE HOUSING & FOCUS AGENCY GROUP | UPLANDS PARK
L&Q | BEAUCHAMP PARK
SPITFIRE HOMES | THE UK’S FIRST SHOW HOME IN THE METAVERSE
Best First Time Buy Apartment
THIS AWARD IS FOR AN APARTMENT SUITABLE FOR A FIRST TIME BUYER, WHICH IS AFFORDABLE AND ALSO OFFERS EXCELLENT DESIGN FLAIR, BOTH INSIDE AND OUT.


PEABODY | THE OAK AT NEWMAN PLACE
A notoriously expensive area to live—rated least affordable for first time buyers outside London—Oxford’s property prices make purchasing an apartment near the prestigious town feel out of reach for many first time buyers. Offering the opportunity to buy an affordable home just south of Oxford’s evocative skyline and cobbled streets, Newman Place is a collection of 162 one to four bedroom homes for shared ownership, part of a 100% affordable development bringing 270 highquality new homes to Oxford. The Oak two bedroom apartments are designed with flexibility in mind, featuring a large open-plan living area, which extends to a covered balcony, while the second bedroom could be used as a home office, gym or cinema room. Statement wide-planked flooring features throughout, while kitchens are equipped with A-rated appliances and available in three colourways. Providing an affordable route on to the ladder, prices start from £85,000 for a 25% share, with a deposit from as little as £4,250. The development’s design, sustainability and ecological credentials respect and enhance the site’s heritage, blending old and new.
NOTTING HILL GENESIS | ASPECT CROYDON



Aspect Croydon by Notting Hill Genesis is bringing high-quality homes for first time buyers to this vibrant south London neighbourhood through shared ownership. Offering modern luxury, the two bedroom apartment features a doubleheight, open-plan interior with a modern kitchen, statement flooring, and bespoke features throughout. A highlight is the winter garden – a flexible, fully enclosed sunlit space, perfect for dining, working or relaxing. Affordability is key at Aspect – with an estimated monthly cost of £1,656, the two bedroom apartment doesn’t cut corners when it comes to quality, with integrated appliances, energy-efficient underfloor heating, custom-built storage space, and a neutral palette to make one’s own. Residents at Aspect enjoy an impressive lobby, featuring a multi-functional mezzanine, and dedicated concierge. Outside, a centralised avenue of trees, public art and landscaped seating area is nestled into the street scene of east Croydon. And with travel times of just 30 minutes into central London, residents are always well-connected.
TRINITY WALK BY LOVELL LONDON
The two bedroom apartment at Trinity Walk, Lovell London’s flagship regeneration scheme in vibrant Woolwich, offers first time buyers an appealing, affordable vision of city living. Priced at just £465,000, with a deposit of just £23,250 (5%) required, buyers don’t have to compromise on price, style or location. Expansive windows flood the open-plan living, kitchen and dining area with natural light, and the space leads out on to a large private terrace. In the main bedroom, an en suite shower room provides additional value, while the second bedroom is of similar size to the main – ideal for two friends sharing. The home is highly energy efficient, paramount for those on a budget. Trinity Walk is ideally positioned for commuting. It’s a sixminute walk from the DLR station of Woolwich Arsenal, and one mile from the area’s new Crossrail station. Also nearby is the high street.

80 First Time Buyer June/July 2023
READERS’ AWARDS buyer
AT THE SILK DISTRICT



Bringing affordability to a burgeoning new neighbourhood in the heart of Whitechapel, L&Q at The Silk District is a major new development comprising 73 one and two bedroom shared ownership apartments – and an exceptional array of resident amenities, rarely available to first time buyers. Part of an award-winning joint venture scheme with Mount Anvil, the development is nestled in the heart of an ambitious £300m masterplan which is seeing this well-connected, central district revived with a new urban quarter of 698 new homes, commercial buildings and public space. One of east London’s coolest developments, The Silk District features a plethora of exclusive resident facilities including a state-of-the-art gym (the first residential development to offer Peloton Bikes) and a private cinema room. This is apartment living that goes beyond just four walls. Carefully designed to facilitate the multi-functionality of a modern lifestyle, the stylish and contemporary shared ownership apartments start from £123,125 for a 25% share with a full market value of £492,500, with a deposit from as low as £6,156.
ORIGIN HOUSING | HARROW AND WEALDSTONE HEIGHTS





















A landmark new development by Origin Housing, transforming the north west London skyline, the impressive Harrow and Wealdstone Heights is a collection of 81 shared ownership apartments in Harrow. Offering sky-high apartment living in an architecturally striking development, 18 storeys at its highest, homes at Harrow and Wealdstone Heights offer panoramic views. Suitable for singles, couples and sharers alike, apartments at Harrow and Wealdstone Heights are flexible and multi-functional. The generous open-plan kitchen/living and dining area provides ample space for cooking and hosting, while still offering room for a cosy, relaxing area. Making things even easier for first time buyers looking to move straight in, the kitchen is fitted with integrated appliances. Prices at Harrow and Wealdstone Heights started at £80,625 for a 25% share of a one bedroom apartment with a full market value of £322,500.
COUNTRYSIDE PARTNERSHIPS | BEAULIEU GATE



Offering first time buyers the chance to step on to the property ladder in a soughtafter location, The Whitebeam two bedroom apartment at Beaulieu Gate is part of Countryside’s latest collection of homes to be launched in Chelmsford, Essex. Featuring a generous open-plan living/dining space with a bay window, this bright and airy space is flooded with natural light. Sold with a superior specification as standard, including luxury flooring and fully integrated appliances, this is the perfect, hassle-free first home. Ideally suited to first time buyers, the First Home scheme was also available for this release of homes*. Surrounded by 176 acres of public open space, residents also enjoy a variety of amenities on the doorstep alongside excellent transport connections to London and beyond. This stylish apartment is perfect for those seeking to be part of a vibrant new community in a semi-rural setting, while remaining within commuting distance of central London. *T&Cs apply.

First Time Buyer June/July 2023 81 READERS’ AWARDS buyer Sponsored by
L&Q
Best Partn ship


THIS AWARD CATEGORY CELEBRATES A COLLABORATION OF TWO OR MORE COMPANIES WHICH HAVE WORKED TOGETHER TO DELIVER BOTH QUALITY AND AFFORDABLE HOMES FOR FIRST TIME BUYERS. IT WILL HIGHLIGHT BEST PRACTICE OF PARTNERSHIP WORKING WITHIN THE HOUSING SECTOR AND CHAMPIONS THE ETHOS OF WORKING TOGETHER TO DELIVER MORE.
The partnership between Barratt David Wilson North Thames and shared ownership provider heylo housing has allowed first time buyers to take their first steps on the housing ladder in the leafy new neighbourhood of Linmere in Bedfordshire. The developer selected heylo and its Home Reach scheme, part of the Government’s shared ownership offer, to work at Linmere, allowing first time buyers to put down roots with just a £5,500 deposit. The companies joined forces to offer 20 new homes to lower income buyers, a mixture of one and two bedroom apartments with open-plan living areas, private balconies and allocated parking, where prices began from just £101,000 for a 50% share. Barratt David Wilson’s development at Linmere has proven extremely popular with first time buyers, with 85% of homes sold off-plan to those buying for the first time, as the new relationship with heylo opened its doors to an even wider audience.
COUNTRYSIDE PARTNERSHIPS | ASHMERE
Ashmere is a sustainable landmark neighbourhood in Ebbsfleet, Kent, that will comprise 2,600 new mixed-tenure homes of which 25% will be affordable, as well as a new primary school and a village centre, when fully complete. Ashmere is being delivered through an innovative joint venture between Countryside Partnerships, the UK’s leading mixed-tenure developer, and Latimer, the development arm of Clarion Housing Group, the country’s largest housing association. The new scheme is also being delivered in collaboration with landowner Henley Camland, as well as the Ebbsfleet Development Corporation, to deliver their vision for the wider area of Ebbsfleet. With the aim of reconnecting the local community to nature, the development is set against the dramatic white cliffs synonymous with Kent, while a country park, lake and expansive open green spaces weave throughout the area to give residents a healthy, safe and sustainable lifestyle.
COUNTRYSIDE PARTNERSHIPS AND LATIMER, PART OF CLARION HOUSING GROUP


Countryside Partnerships is building 3,500 homes in Sherford, of which 1,500 are being built in partnership with Latimer, the development arm of Clarion Housing Group. Working together to increase the number of affordable homes on this ambitious development, Sherford is a 12-year partnership and has already become one of Latimer’s best performing shared ownership developments. Latimer delivers homes through private sale and shared ownership and reinvests any surplus back into the organisation to support its social mission. Committed to providing good quality and affordable homes, Latimer also prioritises communities with its long-term interests in supporting residents to thrive in their neighbourhoods. Countryside Partnerships is part of Vistry Group PLC and is one of the country’s leading mixed-tenure developers. The combined business incorporates over 40 years’ experience of collaborative working with partners in both the public and private sectors, creating a positive legacy for future generations.

82 First Time Buyer June/July 2023 READERS’ AWARDS buyer
BARRATT DAVID WILSON AND HEYLO HOUSING AT LINMERE
SO RESI X RESI HOUSING & RESI HOMES







SO Resi, the dedicated shared ownership brand of Metropolitan Thames Valley Housing, and specialist asset management group ReSI Housing & ReSI Homes first established their partnership in 2018. Following an initial investment of £16.5m to launch 34 new homes in Totteridge, north London, the partnership has scaled significantly and delivered 430 homes over the last five years. Most recently, the partnership enabled the launch of SO Resi Hope Green in Stanford-le-Hope, Essex: the first and largest operational net zero carbon development in the UK with four guaranteed bill-free houses. All 153 new homes are available through shared ownership, providing accessible housing options to buyers otherwise priced out of the market. The partnership has delivered 11 developments in total, and is a stellar example of how private investment firms can help tackle the UK’s housing crisis by partnering with not-for-profit organisations to accelerate the delivery of affordable, sustainable new homes for the next generation of buyers.

BARRATT LONDON, L&Q AND TRANSPORT FOR LONDON (TFL) | BLACKHORSE VIEW












Blackhorse View in Walthamstow has transformed a car park into a 1.82-acre mixeduse development of 350 new homes and 17,500 sq ft of commercial floorspace. The project is a joint venture between Barratt London and housing association L&Q, joining forces as BLLQ LLP and Transport for London. This highly successful partnership released brownfield land for regeneration, providing homes and jobs for local people and improving the public realm. A wide variety of housing types, from studio apartments to larger three bedroom apartments, ensures a well-rounded community, with 50% affordable housing. Sustainability has been well-considered. Homes benefit from rooftop solar panels and an energy network to reduce carbon footprint. The car-free development improves air quality in the area, helped by the extensive tree and hedge planting. New footpaths, the provision of a public cycle hub outside Blackhorse Road station and generous bike storage all encourage residents and the community to travel sustainably.
DAVID WILSON HOMES SOUTHAMPTON | NIVEUS WALK













A partnership between David Wilson Homes’ Niveus Walk in Shaftesbury and Dorset Council has played a significant role in helping Dorset residents priced out of the local housing market, achieve their homeownership dreams. The Discounted Market Homes [DMH] scheme offers a 20% discount to all properties at Niveus Walk to buyers with a local connection to Dorset. This was in addition to other deals run separately by David Wilson Homes. For example, under the scheme, plot 27, a two bedroom Charlton home, had a price tag of just £216,000. Plus, a deal running through David Wilson Homes offered £10,800 cashback that could be used towards mortgage contributions, deposit or moving costs – an attractive deal for first time buyers, downsizers or growing families. Since its launch in January 2023, the scheme has provided the largest number of discounted homes that Dorset has ever had on one site.

First Time Buyer June/July 2023 83 READERS’ AWARDS buyer
Sponsored by
Best Show Home
PEABODY | ZONE AT OVAL VILLAGE
Offering an unmissable opportunity to live in the heart of the capital without the astronomical cost, is Peabody’s shared ownership offering at Berkeley’s iconic Oval Village development. Beautifully conceived in partnership with a leading interior design studio, apartment 75 showcases a seamless living experience for trendy first time buyers. With a refined and minimalist material palette, statement high street pieces and DIY panelling, apartment 75 shows what buyers can achieve on a budget. The open-plan kitchen, living and dining space demonstrates how first time buyers can socialise, relax and work at home. With an Instagram-worthy walk-in wardrobe, contemporary Jack & Jill bathroom and spacious balcony, every detail of the home has been selected to show what is achievable at Zone. Carefully designed to be easily replicable, video content demonstrates the home’s transformation from empty unit to enviable apartment. Achieving an aspirational yet accessible look, Apartment 75 will excite and inspire homeowners.

BARRATT LONDON | HAYES VILLAGE


Hayes Village’s new show apartment showcases Barratt London’s industry-first collaboration with major furnishings retailer IKEA – which has long been the first port of call for young people choosing to furnish their new homes. The 504.3 sq ft show apartment at Hayes Village, a Barratt London development in Hayes, is at the heart of the collaboration and the show apartment has been dressed in affordable and stylish IKEA furnishings and accessories to appeal to first time buyers. The show home has been kitted out with features that include fully integrated kitchen appliances, engineered laminate flooring and built-in wardrobes, all making that first move as easy as possible. Buyers across Barratt London’s sites can purchase the show home vision by choosing from three tailored IKEA furniture packages, they will also be offered a consultation session with an IKEA interior designer.
WESTON | NIGHTINGALE HOUSE

Nightingale House is a meticulously converted three bedroom show house at Gun Hill Park, Aldershot, part of the restoration of the magnificent Grade II listed former Cambridge Military Hospital. Weston Homes commissioned GP&J Baker to create an interior that had an air of individuality, yet was designed with affordability in mind. Using its extensive portfolio of high-end and more affordable fabric and wallpaper brands, GP&J Baker created a masterclass on how first time buyers can design affordable interiors by mixing luxurious and accessibly priced fabrics, wallcoverings and soft furnishings. The eclectic design includes a curated mixture of new items from high street retailers such as Zara Home and John Lewis, and around 80% of pre-loved items from eBay. Not all first time buyers can transform their new home to emulate a show home from the moment they move in. This shows what is possible with a little bit of imagination and a resourceful approach.

84 First Time Buyer June/July 2023 READERS’ AWARDS buyer
THIS AWARD GOES TO THE COMPANY WITH THE BEST SHOW HOME ALLOWING BUYERS TO SEE THE PROPERTY TO ITS MAXIMUM POTENTIAL, GIVING THEM A REALISTIC INSIGHT INTO THEIR NEW HOME
L&Q AT HAYES VILLAGE
Offering much needed affordable housing in the heart of Hayes, West London, L&Q is delivering a collection of studio, one, two and three bedroom shared ownership homes at L&Q at Hayes Village. Transforming the site of the former Nestle Factory, Hayes Village will become the capital’s newest urban centre, ultimately providing over 1,300 new homes, with landscaped communal gardens, 338 of which will be delivered through shared ownership by L&Q. The studio homes at L&Q at Hayes Village, designed by Lifestyle Interiors, provide a relatively rare – and unique – offering for first time buyers in the capital, with interest levels high from young professional single and couples particularly. But faced with one large, open space to live, work and relax in, L&Q felt buyers could struggle with how to decorate their home, or feel overwhelmed about how best to utilise the internal layout. Offering value for money in west London, studio apartments at L&Q at Hayes Village start from £57,500 for a 25% share (FMV: £230,000), with 5% deposits from just £2,875 – in comparison, according to Zoopla, the average price paid for a studio in London is £313,500.
The three bedroom Cypress is one of Vistry’s most sought-after house types. The ambition was for its interior design to authentically show how a first time buyer, regardless of age, relationship status or working lifestyle, might live in the property. This included a deliberately unfinished appearance, which Edward Thomas Interiors achieved by incorporating modest amounts of furniture, alongside artwork and accessories sourced from high street stores or online retailers. Edward Thomas Interiors has illustrated how first time buyers can create eye-catching features like statement walls, together with multi-purpose rooms suitable for young, mature and four-legged family members, on a budget with style and vibrancy. The result is a warm and welcoming home with affordable, realistic finishes. Edward Thomas Interiors designed and installed The Cypress show home in January 2023. Vistry has sold five of the seven Cypresses currently available at Hampton Water, including one to the development’s field sales manager.

GRAND AVENUE FOR SOUTHERN HOUSING BY


























Working with Southern Housing, we were asked to create an inspirational two bedroom show home at Grand Avenue, within the Kings House development in Hove. The interiors needed to appeal to young professionals familiar with the area. Much of our inspiration came from the property’s historic and iconic location, as well as the famous Birdcage bandstand in Brighton. The art deco and classic influences allowed us to explore styles that included geometric shapes, bold patterns, monochrome palettes, mosaic styles, and botanical touches. It was also important for us to recognise the distinction between Hove and Brighton in our design, given Hove is typically regarded to be a more affluent area with all the benefits of Brighton being nearby; all while creating a vibrant and playful home that was affordable and attainable to first time buyers.

First Time Buyer June/July 2023 85 READERS’ AWARDS buyer Sponsored by
EDWARD THOMAS INTERIORS FOR VISTRY HOMES EAST MIDLANDS | THE CYPRESS AT HAMPTON WATER
INVESTA
Best First Time Buy Fam y Home
THIS AWARD IS FOR A FAMILY STARTER HOME WHICH IS AFFORDABLE FOR A FIRST TIME BUYER. IT SHOULD OFFER A COMFORTABLE ENVIRONMENT, AT A REALISTIC PRICE, WHICH IS IDEAL FOR FAMILY LIVING
PEABODY | ABBEY CORNER



It’s well-documented that the cost-of-living crisis is impacting hopeful homeowners across the country. Offering affordable forever homes in affluent Colchester, Abbey Corner is a collection of 25 two and three bedroom family homes, available exclusively through shared ownership. Family living at Abbey Corner is best exemplified by The Spindle – a high-specification semi-detached three bedroom house perfectly meeting the demands of family life. Designed with flexibility in mind, this house type caters to all walks of family life, from generously sized bedrooms for the children, to spacious entertaining zones for the teenagers to have friends over or enjoy a Sunday roast with grandparents, together with an expansive main bedroom with a larger than normal en suite bathroom offering parents their own retreat. The Spindle homeowners can also enjoy a private garden, two parking spaces and generous storage inside and out – all must-haves for modern family life. The family-focused development offers communal green space and a children’s playground. The Spindle providing buyers with a high quality of living and value for money for a home of their own in South East England.

Rowan Wood, in the heart of the Lancashire landscape, really does have it all. Not only has this development provided much-needed affordable family homes, but it is set in a stunning location close to a city centre and an Area of Outstanding Natural Beauty, making it a rare find. Designed with families at their heart, the high-spec homes with open-plan kitchens and en suite bathrooms look as good on the inside as they do on the outside. Carefully crafted to reflect the existing stone-fronted properties in the area, these have a modern twist including electric car charging points and solar panels – ready for life today. Our ethos at Jigsaw Homes Group is Building Homes, Changing Lives and this is exactly what these homes embody. Their generous size, kerb appeal and ideal location gives younger families room to grow, and older families the chance to relax and enjoy life to the full.


SPITFIRE HOMES | THE BROXTON
The Broxton is a versatile and affordable family home. Unlike your typical first time buyer property, this striking three bedroom home has been created with a focus on design – offering kerb appeal and a desirable internal layout. Externally, inspiration comes from the timeless Georgian architectural style with large sash-style windows and a balanced symmetry to the elevations. This is paired with modern finishing touches, including black and anthracite grey detailing and a contemporary front door, bringing the aesthetic into the 21st century. Within the property, the doublefronted layout comes into its own, maximising the 928 sq ft of available space. The open-plan layout encompasses a large lounge and a kitchen/diner with external access. A real appeal of this home is the stylish specification, with a designer kitchen and premium brand bathrooms paired with a wealth of energy-efficient features such as underfloor heating with a smart thermostat and air-source heat pump.
86 First Time Buyer June/July 2023 READERS’ AWARDS buyer
SNUGG HOMES | ROWAN WOOD
SOUTHERN HOUSING | CARMEN FIELDS

Nestled in the countryside of east Sussex, Carmen Fields is a stylish neighbourhood comprising two and three bedroom semi-detached and detached shared ownership houses being delivered by Southern Housing. An affordable route to homeownership in the picturesque village of Ninfield, Carmen Fields is the optimum choice for family buyers. Outstanding specifications are blended with spacious gardens in a beautifully landscaped development, all within easy reach of everyday amenities and good schools. Surrounded by pockets of woodland and lush countryside. Carmen Fields is enveloped by a perimeter of greenery, which includes a dedicated wildlife corridor, and wide tree-lined streets, creating a truly family friendly new neighbourhood. The Sussex, a three bedroom semi-detached house at Carmen Fields, available from £102,000 for a 30% share, is the ultimate family home, with a thoughtful layout and ample space to accommodate the demands of modern life.
BARRATT HOMES SOUTHERN COUNTIES | THE ELLERTON


















The Ellerton, by Barratt Southern Counties, is a spacious three bedroom semidetached home at Meadowburne Place in Eastbourne, East Sussex. Plot 273 is bright and practical, with a large open-plan kitchen/dining room with French doors leading to the south-east facing rear garden, alongside a roomy separate lounge to relax in. Upstairs, the main bedroom has an en suite shower room, while there is a further double bedroom, a single bedroom and a family bathroom. Externally, the Ellerton has been designed with a classic, formal architecture that fits in with its suburban surrounds, with red bricks and tiles. The home is positioned along a quiet road and includes a two-car driveway. Access to green space is prioritised, with a large, equipped playground near to Plot 274. Well-appointed landscaping and trees complete the street scene. Available from £339,995, first time buyers will pay no Stamp Duty and can benefit from schemes such as Deposit Unlock to boost affordability.
NETWORK HOMES | FABER GREEN








Set in the green and leafy borough of Ealing is Network Homes latest shared ownership collection at Faber Green in Northolt. Surrounded by vibrant neighbourhoods, highly rated schools and a wide choice of restaurants and shops, this is the ideal backdrop for families looking to balance quiet suburban settings with easy access to a thriving community. Comprising 126 stunning homes, the collection at Faber Green encompasses one and two bedroom apartments, and two, three and four bedroom houses. Combining soft tones, clean finishes and high-quality fixtures, homes at Faber Green enjoy open-plan living, private outdoor space and plenty of freedom for families to get creative and showcase their own style. Ideal for those looking to establish their first family home, properties at Faber Green are available to purchase through shared ownership.

First Time Buyer June/July 2023 87 READERS’ AWARDS buyer Sponsored by
Best Law Firm for Conveyancing

LAWCOMM SOLICITORS


Lawcomm Solicitors is one of the country’s leading first time buyer specialists. We have dedicated conveyancing teams working in the New Build, Affordable Housing and Residential Conveyancing sectors. Most importantly, we live by the simple business ethos of placing our clients at the centre of our business. Our service ethos means that we will communicate with our clients regularly, honestly and without jargon. By using the latest digital technology, including the use of electronic forms, a secure portal for document upload and digital signatures, we are able to drive our clients’ transactions forward so exchange and completion expectations are met. As a customer-focused firm, we concentrate on delivering an exemplary service to all the parties involved in first time buyer transactions. Consequently, we have developed an enviable reputation leading to a stream of recommendations from housing associations, developers, and mortgage brokers as they recognise that their clients will benefit from friendly legal advice, delivered by solicitors who are experts in the first time buyer sector.


SOLICITORS
PLS Solicitors’ mission is “to be the country’s favourite conveyancer”. Set up in 2008 by its two co-founders Aash Dhand and Rob Thomas, PLS has grown to become the leading provider of new build conveyancing services to purchasers across the UK. Our outstanding conveyancing package has been tailored around the demands of the modern 21st century techie first time buyer. Our firm provides first time buyers with the perfect balance of innovative app-based technology allowing the customer to conduct and progress their transaction from their smartphone, together with the warm and personable experience that you would expect to receive from a local high street practice. Around 50% of our purchasers are first time buyers and we represent around 800 purchasers of new build properties each month.
PRINCE EVANS SOLICITORS LLP


Prince Evans Solicitors LLP is an independent full service law firm based in west London. Our experienced New Build Homes team specialises in acting for buyers of new build and shared ownership properties. We help hundreds of first time buyers to take their first steps in to homeownership every year. At Prince Evans we pride ourselves in putting our client service at the heart of everything we do. We strive to provide an excellent client experience combining our friendly and dedicated team with the use of our App. Our App allows clients to be involved every step of the way. Our conveyancing team has vast experience and understanding of acting for first time buyers and we were proud to be voted the Best Law Firm for Conveyancing at the First Time Buyer Readers Awards in 2020 and 2021 and Highly Commended in 2022.

88 First Time Buyer June/July 2023 READERS’ AWARDS buyer
THIS AWARD CELEBRATES LAW FIRMS WITH OUTSTANDING CONVEYANCING PACKAGES FOR FIRST TIME BUYERS
Sponsored by
PLS
Best Medium Dev opment


THIS AWARD IS FOR DEVELOPMENTS OF 31-80 HOMES THAT HAVE USED THE BEST DESIGN AND QUALITY TO CREATE AN AFFORDABLE, DESIRABLE AND INSPIRATIONAL ENVIRONMENT AND THAT HAS PROVIDED ADDITIONAL FACILITIES TO BENEFIT THE LOCAL COMMUNITY AND SURROUNDING NEIGHBOURHOODS. THESE HOMES ARE ON LARGE DEVELOPMENTS IN A MIXED-TENURE ENVIRONMENT OR STAND-ALONE DEVELOPMENT

ALTA AT CONSORT PLACE BY LATIMER

Offering first time buyers affordable homes in an outstanding central London location, Latimer, the development arm of Clarion Housing Group, introduces Alta at Consort Place. The 44 one, two and three bedroom shared ownership apartments are situated over the highest eight floors of the cutting-edge high-rise building within Canary Wharf’s newest neighbourhood. Consort Place also offers a wealth of new amenities including cafes, a community centre, an international hotel and a charming Victorian pub. Buyers at Alta can enjoy an enriched lifestyle, with a residents’ lounge, workspace areas and landscaped terraces. Stepping outside this municipal oasis brings residents to the lively centre of Canary Wharf. The renowned business district includes five shopping centres, more than 20 green spaces and exhilarating event venues. Jubilee and Elizabeth Line stations, and South Quay and Heron Quays DLR, are all a short walk away, as is the river bus from Canary Wharf pier.

NOTTING HILL GENESIS | WOOLWICH REACH


Since its launch, the 49 shared ownership apartments at Notting Hill Genesis’ Woolwich Reach have proved popular with first time buyers, as a striking waterside development in an emerging part of east London’s Royal Docks. Contemporary open-plan homes feature a specification designed for first time buyers – including energy-efficient underfloor heating and window blinds; integrated appliances; and floor-to-ceiling dual-aspect windows with stunning water, park and city views. Spacious private balconies are complemented by the development’s landscaped communal garden, maximising river views. Adjacent to leafy Royal Victoria Gardens, restoration of the riverside pathway has improved important public access to the popular Capital Ring walking route. With prices starting from £95,000 for a 25% share, homes have provided a real opportunity with young professionals, couples and families – many renting locally – who champion the development for its fast transport connections, stunning location, and huge potential in a largely untouched part of the Thames.
SQUARE ROOTS | SQUARE ROOTS KINGSTON
Set within a sought-after residential area, Square Roots Kingston is an outstanding boutique development offering 41 one, two and three bedroom shared ownership apartments and 11 affordable rent properties, surrounded by woodland and landscaped green spaces. Available from affordable homes registered provider Square Roots, which is backed by award-winning developer London Square, this stunning development enjoys a well-connected location near Norbiton station, Richmond Park and Kingston-upon-Thames. Designed to offer aspiring homeowners an attainable way to own a high-quality property within a prime location, this development offers spaciously designed apartments complemented by a superior specification. Ideal for first time buyers, this pet friendly development includes landscaped communal grounds, play area, allocated parking and cycle storage. With an impressive EPC B rating, energy-efficient features include air-source heat pumps to selected homes, electric car charging points and photovoltaic panels.

First Time Buyer June/July 2023 89
Sponsored by
Best Off-Plan Dev opment


GUINNESS HOMES | SIGNAL PARK
With Phase One bringing 211 stylish new shared ownership properties to Tolworth, Guinness Homes’ Signal Park development is making homeownership in London an affordable option for first time buyers with a range of budgets. With practical completion expected in Q3 2023, eager customers are reserving off-plan and are celebrating buying their first home. Comprising a combination of one, two and three bedroom apartments and six two bedroom duplexes, the 211-unit Phase One block offers a starting price of just £88,125 for a 25% of a one bedroom apartment, meaning that first time buyers would only require £4,406.25 for a 5% deposit. Affordability does not mean a compromise on interior quality or location. Strategically situated in bustling south east London, residents have direct access to Waterloo in just 31 minutes, with Tolworth station a convenient three-minute walk from the development; perfect for commuting or visiting the attractions of central London.
HAMPTON COURT PLACE BY CHANCERY HOMES, PART OF THE OCTAGON GROUP
Recognising the need for contemporary, high-quality apartments in Surrey, Chancery Homes, part of The Octagon Group, bought Hampton Court Estate in 2022. A highly desirable 1.59-acre site moments from Hampton Court station –offering a frequent service into London Waterloo from just 32 minutes – the newly named Hampton Court Place is now set to house 78 apartments perfectly suited to first time buyers and 3,000 sq foot of commercial space. Comprising one, two and three bedroom accessibly priced apartments from £350,000, Hampton Court Place offers an affordable solution, with eight units also available to buy through shared ownership. The design-led development is arranged across three buildings, and apartments will be between 538 and 990 sq ft, most with private balconies and access to a large rooftop terrace, adding to the sense of community. Designed with sustainability in mind, homes will have entirely electric heating systems and include heat pump combi units.


MONTREAUX HOMES | URBAN PICTUREHOUSE

Located in the desirable south east London neighbourhood of Sidcup, Urban Picturehouse (UPH) is a collection of contemporary studio, one, two and three bedroom apartments, impeccably designed for smart urban living. The development combines chic design with architectural finesse to create a development that offers timeless quality. The classically proportioned and striking emerald-glazed brick facade reflects the cinematic heritage of the site. Each apartment has its own private outside space, complemented by a private landscaped courtyard garden for the residents to share. Urban Picturehouse is designed to create a community environment to attract first time buyers alongside upsizers and downsizers. Out of 31 apartments, four are studios and 13 are one bedroom – both are ideal for first time buyers. We also have eight, two bedroom apartments for joint purchasers or first time buyers looking to share and enjoy a larger space.

90 First Time Buyer June/July 2023 READERS’ AWARDS buyer
THIS AWARD WILL BE LOOKING TO RECOGNISE A DEVELOPMENT THAT HAS NOT YET BEEN BUILT/COMPLETED BUT OFFERS GREAT POTENTIAL TO FIRST TIME BUYERS
BE WEST | THE BOLLO COLLECTION






Just moments from the revered Chiswick High Road, The Bollo Collection by BE WEST epitomises everything London living has to offer, with close proximity to a variety of leisure facilities, speedy transport links and stunning green spaces. Perfect for first time buyers looking for an affordable route on to the property ladder, homes at The Bollo Collection are available to purchase off-plan with shared ownership. Located in a rapidly changing neighbourhood, adjacent to the Acton Gardens Development and the TfL regeneration scheme, the redevelopment of the Bollo Lane area offers a perfect opportunity for first time buyers to reap the rewards of regeneration. Set across two distinct buildings, the collection includes 40 one and two bedroom apartments. Offering high-quality design, an excellent specification and a variety of layouts, homes feature a neutral decor palette, allowing buyers to add their own style. The development includes new, flexible commercial spaces.


HIGGINS HOMES | THE GARRATT COLLECTION














The Garratt Collection is a superb off-plan development of 36 new apartments and houses in Earlsfield, London SW18, by Higgins Homes. With properties ranging from one bedroom apartments to four bedroom townhouses there is something for everyone – with Higgins’ care and attention to detail evident throughout. Elegantly architecturally detailed outside and full of light inside, most apartments are dual aspect, and all include a balcony or terrace. The communal garden, with seating and natural play areas, provides space for nature as well as people. The Garratt Collection is a short walk from Zone 3 Earlsfield station, with services to Waterloo in 13 minutes, while The Southside Shopping Centre, the fifth largest indoor shopping centre in London, with a Waitrose and Cineworld, is a similar distance away. An abundance of nearby parks offer tennis courts, sports pitches and play areas, while the riverside Wandle Trail provides scenic cycling and walking. There is so much on your doorstep, you may never feel the need to wander far.

NOTTING HILL GENESIS | INDIGO HOUSE





In east London’s Royal Docks, 65 shared ownership homes are available off-plan at Indigo House, the newest phase of Notting Hill Genesis’ award-winning Royal Albert Wharf. Already a thriving destination and emerging cultural hub, artists, entrepreneurs, families and young professionals are making this exciting waterside development home. Ready to move in from late 2023, homes at Indigo House are intelligently designed for the long term. A wide-ranging specification includes integrated appliances and energy-efficient underfloor heating for sustainable living, and open-plan layouts with light-filled interiors to make one’s own. Along with a concierge and landscaped linear park – complete with playground – residents can enjoy the neighbourhood’s Well Bean cafe, celebrity chef Cyrus Todiwala’s, Café Spice Namasté, and workshops by on-site creative learning provider Bow Arts. Buyers are taken smoothly through the off-plan purchasing process with Notting Hill Genesis’ expert sales team, first-class show homes and innovative marketing suite technology.

First Time Buyer June/July 2023 91 READERS’ AWARDS buyer Sponsored by
Best Large Dev opment

THIS AWARD IS FOR DEVELOPMENTS OF 81 OR MORE HOMES THAT HAVE USED THE BEST DESIGN AND QUALITY TO CREATE AN AFFORDABLE, DESIRABLE AND INSPIRATIONAL ENVIRONMENT AND THAT HAS PROVIDED ADDITIONAL FACILITIES TO BENEFIT THE LOCAL COMMUNITY AND SURROUNDING NEIGHBOURHOODS. THESE HOMES ARE ON LARGE DEVELOPMENTS IN A MIXED-TENURE ENVIRONMENT OR STAND-ALONE DEVELOPMENTS


L&Q | BARKING RIVERSIDE
At Barking Riverside, L&Q is offering new buyers exceptional value for money, design-led homes and impressive transport links in one of the country’s most exciting new developments. Barking Riverside is a major placemaking project of over 10,000 homes, public facilities, and commercial and leisure amenities, on the banks of the River Thames in east London. Delivered by Barking Riverside Limited (BRL), a joint venture between housing association L&Q and The Mayor of London, the development is quickly proving a first time buyer hotspot. The addition of a new Overground station and an Uber Boat pier by Thames Clippers have made the area even better connected and more enticing for buyers. Facilities promoting a strong sense of community include The Wilds, an award-winning multi-purpose building serving as a community hub, alongside open spaces and five schools (with two more to come). With a range of homes for shared ownership and outright sale, deposits for L&Q’s homes at Barking Riverside start at £4,063 – truly affordable for first time buyers.

Barratt and David Wilson Homes’ Harbour Place is an exceptional example of how a development showcases sustainability at its heart without compromising on style and comfort. Located between Drayton and Bedhampton, the dual-branded development comprises 320 attractive two to four bedroom homes, built to a high standard with a 10-year NHBC warranty and a Built for Life stamp of approval. With more than 30.5 acres of green space, the development is home to 31,000 bee-friendly shrubs and trees, 15,682 new sapling hedgerows, nine acres of wildflower meadows and six biodiversity areas with ponds. The homes are 63% more energy-efficient than a traditional home and each has advanced systems and smart technologies. The properties hold an energy-efficiency rating of either A or B, a level of energy efficiency shared with just 3.1% of existing homes.
ESQUIRE DEVELOPMENTS | WOODLANDS
Bringing premium specification to a tranquil setting, Esquire Developments proudly presents Woodlands, a completed development of 94, two to five bedroom homes in Cliffe Woods, Rochester. As one of Esquire’s largest developments to date, Woodlands provides the foundations of futures, with a select range of private and affordable homes and bungalows alongside newly built office spaces, a nursery and community play area. Perfectly placed in the Cliffe Woods, Woodlands is surrounded by open countryside, ancient woodland and existing neighbouring communities. The housing mix was chosen to complement the existing surroundings of the development, and to also reflect the vision of the existing local community, which was taken into consideration during the consultation phase. House types range from two to five bedroom bungalows, apartments and houses, and 23 of the homes were affordable (shared ownership/affordable rent) housing which was provided by mhs Homes.

92 First Time Buyer June/July 2023 READERS’ AWARDS buyer
BARRATT AND DAVID WILSON HOMES | HARBOUR PLACE
CITY AND COUNTRY | FACTORY NO.1







A former tobacco factory, Factory No.1 is an award-winning development of 284 conversion and new build apartments in Bristol’s up-and-coming Bedminster area. City & Country has converted and lovingly restored the Grade II listed Victorian tobacco factory which is set around beautifully landscaped private courtyard gardens. Whether looking for a characterful property, or a more modern apartment, this highquality development presents a fantastic opportunity to first time buyers looking for an affordable step on to the property ladder. Ideally located for Bristol City centre and speaking directly to a generation of first timers, this unique conversion development is unlike any other in the area.

PEABODY | NEW MANSION SQUARE

Part of Battersea Power Station – one of London’s most iconic and historic landmarks as well as one of the most prominent new neighbourhoods in the UK –New Mansion Square is a beautiful collection of studio, one and two bedroom shared ownership homes. New Mansion Square gives first time buyers an affordable route to homeownership and offers them so much more than just a place to live, in a prime Zone 1 location. Meticulously designed for modern living, these contemporary homes border around a central garden square, which provides a beautiful backdrop to everyday life. Offering a unique sense of community, the development hosts a dedicated concierge service designed to help effortless living – from collecting parcels, holding keys, to helping with general queries, alongside a new NHS medical centre, cultural space, play area and flexible workspace for both residents and the local community to benefit from. Discover more about New Mansion Square: newmansionsquare.london
BELLWAY LONDON | EASTSIDE QUARTER

















Bellway London’s Eastside Quarter development has transformed a former civic offices site into an attractive new residential community in the heart of Bexleyheath –providing attainable and desirable housing that meets the needs of first time buyers. The development comprises studio, one, two and three bedroom apartments within six buildings, with a host of additional features including roof-top and podium gardens, a residents’ gym, a concierge service, parking and a car club. The appeal for first time buyers is clear, with 291 of the 394 apartments (74%) completed so far provided to those buying their first home. Customer satisfaction rates are exceptionally high, with 93% of buyers here saying they would recommend the homebuilder to a friend. Eastside Quarter has supported the ongoing regeneration of the wider neighbourhood, providing 3,000 sq m of commercial floorspace and public realm improvements which have enhanced the vitality of Bexleyheath town centre.

First Time Buyer June/July 2023 93 READERS’ AWARDS buyer Sponsored by
Best New Deveopment in the South
THIS AWARD IS FOR THE BEST DEVELOPMENT OF ANY SIZE IN THE SOUTH OF ENGLAND (FOR THE PURPOSES OF THIS CATEGORY – BELOW BIRMINGHAM). A HIGHLY COMPETITIVE MARKETPLACE WHERE THE CONSTRUCTION OF NEW HOMES IS INCREASING, THIS AWARD RECOGNISES AN EXCEPTIONAL RANGE OF NEW HOMES THAT STANDS OUT FROM THE CROWD WHILE REMAINING ACCESSIBLE TO FIRST TIME BUYERS



GUINNESS HOMES | MCARTHUR’S YARD

McArthur’s Yard is situated in the heart of Bristol’s city centre with a dynamic community on its doorstep. As one of the only waterfront developments currently available in Bristol, its location perfectly mixes vibrant city living with the tranquillity of a waterside setting. With necessary amenities and cultural attractions within walking distance, it is the perfect Southern location for first time buyers. The development offers one, two and three bedroom apartments, penthouses and duplexes, each equipped to a high specification with stunning design finishes to reflect modern, contemporary living. McArthur’s Yard offers competitively priced outright sale properties and will have a variety of affordable shared ownership homes available to reserve later this year. This mixture of homeownership pathways ensures that this desirable location is within reach of first time buyers of any budget and affordability, making it a worthy winner based on the location, specification and high standard of living that it promotes.

L&Q AT HIGH STREET QUARTER
Meeting the increased demand for new properties in west London is L&Q at High Street Quarter, a new development of 155 homes in Hounslow. Offering one to three bedroom apartments, L&Q at High Street Quarter offers a remarkable breadth of homes available through shared ownership in West London, giving first time buyers an opportunity to get on to the property ladder. With prices for a one bedroom home starting at £75,063 for a 25% share, buyers can purchase a home in Hounslow with a deposit from as little as £7,500, a staggering 16 times less than the London average according to Halifax. Positioned just off of Hounslow High Street, the new neighbourhood – which will eventually consist of over 500 new homes – will have 134,000 sq ft of commercial floor space, comprising a multitude of retail, leisure, and transport options right on the doorstep, creating the perfect destination for first time buyers hunting for the convenience and access to amenities offered by city living.
PEABODY | SOUTHMERE


Part of Peabody’s 30-year regeneration plan for Thamesmead, Southmere is an exciting addition to an established neighbourhood that offers the local community a new public square, state-of-the-art public library and community spaces, an enhanced commercial offering and over 500 new homes. Set in a vibrant lakeside setting, Southmere residents have access to exclusive amenities including a landscaped podium garden, convenient concierge services, a calming residents’ lounge featuring a cosy snug space to watch films, and dedicated co-working spaces. Shared ownership apartments are unapologetic in design with modern fittings and integrated appliances throughout. First time buyers can enjoy every inch of their home with the help of open-air balconies and terraces. Abbey Wood station – the start of the newly opened Elizabeth Line – is less than a 10-minute walk away. Southmere delivers value for money with exclusive and public amenities within a proud community; all competitively priced for first time buyers.


94 First Time Buyer June/July 2023 READERS’ AWARDS buyer
Sponsored by
Best New Deveopment in the North

THIS AWARD IS FOR THE BEST DEVELOPMENT OF ANY SIZE IN THE NORTH OF ENGLAND (BIRMINGHAM AND ABOVE), AN AREA OF THE COUNTRY WHERE HOUSEBUILDING IS INCREASING AND OFFERS A HIGHLY COMPETITIVE MARKETPLACE. THIS AWARD RECOGNISES AN EXCEPTIONAL RANGE OF NEW HOMES THAT STAND OUT FROM THE CROWD, WHILE REMAINING ACCESSIBLE TO FIRST TIME BUYERS



GUINNESS HOMES | POINTS CROSS



Guinness Homes’ Points Cross development is at the heart of a vibrant neighbourhood in Leeds city centre, targeted specifically towards first time buyers. Points Cross is set to be the largest development in Guinness Homes’ 130-year history, with a planned total of 928 homes on completion that are designed to suit a variety of lifestyles. Phase One of the development brings 193 shared ownership apartments to Leeds, offering one, two, and three bedrooms, and 24 three bedroom duplexes. With prices starting from £84,500 for a 50% share in a one bedroom apartment, shared ownership is an affordable alternative to traditional homeownership, with a 5% deposit on a one bedroom apartment potentially as low as £4,150. Perfectly situated in a lively and picturesque dockside community, with conveniently placed amenities including artisan bakeries and yoga studios, Points Cross is the ideal development for first time buyers looking for a slice of city living.
SNUGG HOMES | ROWAN WOOD
Rowan Wood is a rare find. Set in the heart of the stunning Lancashire landscape, its location close to Preston city centre and an Area of Outstanding Natural Beauty makes it an enviable development for first time buyers. Not only do these stone-fronted properties reflect the characteristics of the local area, they provide everything families and couples need for sustainable, modern living with room to grow in a fast-establishing community. With their generous size, high specification and energy efficiency, coupled with excellent transport links, a raft of local amenities and close proximity to good local schools, it’s no wonder this development was one of Snugg Homes’ most popular. Crucially, Rowan Wood provides much-needed affordable homes in an area that has traditionally priced locals and young people out of the market.
PLUMLIFE HOMES | THE POPLARS

Plumlife is delighted to present The Poplars in Heaton Mersey, Stockport. A brand new mixed-tenure development featuring two, three and four bedroom homes with 54 of these available to purchase through the shared ownership scheme. Set on the outskirts of Stockport, and within easy reach of Manchester via tram, train and road, the new homes are ideally positioned for commuters, while offering spacious and flexible living for those working from home. The area is in very high demand and shared ownership has allowed local people to step on to the property ladder. Affordability does not mean any compromise on style, and homes at The Poplars have a very high specification. Situated next to Heaton Mersey common, The Poplars and surrounding areas are blessed with great open spaces in the thriving suburbs of Stockport. The Poplars also maintains a sympathetic approach to the beautiful natural surroundings.

First Time Buyer June/July 2023 95 READERS’ AWARDS buyer
Sponsored by
Best Prov to the FTB Market
FAIRVIEW NEW HOMES
Fairview prides itself on helping first time buyers get on the property ladder and builds affordable homes for those looking to take their first step into homeownership. Since 2013, Fairview has helped almost 2,700 first time buyers become homeowners through Help to Buy. With the loss of the Government scheme this year, Fairview launched its own exclusive Save to Buy scheme. Designed to help first time buyers save a deposit while living in their new home, Save to Buy means buyers can move straight into their new home, while 100% of the fixed monthly payments go towards their deposit. The first time buyer developer is also supporting new homeownership with its “Buddy Up” incentive, which offers legal fees and expert advice up to the value of £2,000, to help navigate the process of buying with a friend, and provides new Fairview homeowners with an “Essential Starter Pack” of household essentials worth £200.

SHARE TO BUY
By the side of purchasers since 2013, the Share to Buy property portal receives on average a property enquiry every two minutes from a hopeful first time buyer. Now a decade old, the property portal hit a remarkable milestone this year, having generated its two millionth lead for the sector – firmly cementing its position as the destination for first time buyers. Unrivalled in both its volume of properties and wealth of impartial informative content, at any one time on Share to Buy, there are almost 5,000 homes listed – including shared ownership, Discount Full Ownership and London Living Rent. In addition, Share to Buy host the capital’s largest first time buyer event – the London Home Show. An exceptional resource for first time buyers, the free-to-attend event gives buyers the opportunity to speak face-to-face with housing experts, mortgage advisers and solicitors. The show has welcomed over 60,000 guests since starting in 2013 and continues to grow each year.

METRO FINANCE



We just love shared ownership! Partnered with over 100 housing associations across the UK, we help around 3,000 shared ownership buyers every month, helping the buyer into their new home and ensuring our partner HAs meet regulatory requirements. Supporting the sector, we developed affordability chatbots, staircasing chatbots and a series of portals for buyers and HAs, all of which track and streamline the shared ownership journey. And, for the long-term benefit of SO buyers, we’ve encouraged new lenders into the shared ownership lending space, while existing lenders rely on our input for product evolution. Constantly improving service levels, we pioneer tech in the shared ownership mortgage world, introducing facial recognition ID checks and Open Banking software to our portals, focused on making it even easier for buyers and HAs. We constantly evaluate ourselves as a business, striving to achieve best in class service for shared ownership buyers and our HA partners. Our dedicated team of around 60 has helped drive our Trustpilot rating to the highest in our field. Can we do more? Always… working with lenders, regulators, and stake holders to give shared ownership the positioning it deserves.

96 First Time Buyer June/July 2023 READERS’ AWARDS buyer
THIS AWARD GOES TO A SERVICE, COMPANY OR AGENCY THAT SUPPORTS THE FIRST TIME BUYER INDUSTRY. THIS COULD BE A PRODUCT OR SERVICE THAT HELPS TO SUPPORT AND PROMOTE THE MESSAGE OF HOMEOWNERSHIP
Affordable Housing Prov of the Year

THIS AWARD WILL GO TO AN ORGANISATION THAT HAS SHOWN INNOVATION IN THE WAY IT DESIGNS, BUILDS AND MARKETS ITS PROPERTIES AS WELL AS OFFERING A VARIETY OF SERVICES WHICH CAN HELP FIRST TIME BUYERS ON TO THE PROPERTY LADDER



Metropolitan Thames Valley Housing (MTVH)


formed in 2018 when Metropolitan and Thames Valley Housing merged. It owns or manages 57,000 homes across London, the South East, East Midlands and East of England, is a member of the National Housing Federation and currently Chair of the G15, which represents London’s largest housing associations. MTVH not only offers affordable rent and open market sales, but has a dedicated home for shared ownership via its SO Resi brand. Constantly innovating, SO Resi’s sister brand SO Flexi will release its first London Living Rent and Rent to Buy units this year, which will provide a crucial foothold in the renting to homeownership pipeline for first time buyers. In a further bid to increase the supply of affordable homes, MTVH continues its focus on forging strategic, dynamic partnerships through its established SO Resi Partnerships arm to help buyers find a home while supporting the market and working with other organisations to bring homes into use more quickly.
HOMES




Plumlife Homes is a profit-for-purpose housing organisation that has been helping people with affordable homeownership for over 20 years. Some of Plumlife’s specialities include the development, sales, and marketing of shared ownership homes. For Plumlife, it’s not just about helping people on to the property ladder, the organisation is led by a purpose to help people and create great places to live. Over the past 12 months, Plumlife Homes has transformed to help people who need to access affordable homes. They have rebranded and launched a new customer-centric website to better communicate with people, shifted the build of their properties in response to people’s behaviours, launched a shared ownership resale agency called Plumlife Move, continued to offer incredible support to first time buyers and much, much more!
Helping an impressive 1,465 buyers get on to the property ladder last year through shared ownership and Help to Buy, L&Q is committed to helping make homeownership an affordable and accessible option for as many first time buyers as possible. Showing how accessible the shared ownership scheme can be for first time buyers in the capital and beyond, the average deposit for an L&Q home in London is less than half the capital average – with a whopping 754 purchasers buying a home on their own – with deposits from just £3,250. Showcasing the long-term investment and security offered by a shared ownership home, an impressive 400 residents staircased with L&Q last year, some to full ownership. L&Q is also set on building and investing in communities, including delivering much-needed transport infrastructure for one of the UK’s most important housing developments, Barking Riverside.
GUINNESS HOMES
Guinness Homes is part of The Guinness Partnership, founded over 130 years ago and one of the largest affordable housing and care providers in England. Guinness is committed to providing as many high-quality affordable homes as possible, and the housing and care services that customers most need. Guinness Homes manages the new build shared ownership and outright sale pipeline across England, with far reaching coverage: as far down in the South as Exeter and Brighton; to London in Bromley-by-Bow, Tolworth and Hornsey; East to Southend-onSea; West to Bristol and Gloucester; to up North, in Leeds and Crewe. With an ambitious development programme of 2,500 homes in the works – featuring use of sustainable modular built homes, marketed with grassroot community engagement projects, helpful FTB financial incentives, and a dedicated aftercare support service, Guinness Homes are determined to bring affordable quality homes to everyone.
First Time Buyer June/July 2023 97 READERS’ AWARDS buyer
Sponsored by
L&Q
PLUMLIFE
METROPOLITAN THAMES VALLEY HOUSING
Private Dev op of the Year
THIS AWARD WILL FOCUS NOT ONLY ON THE DESIGN AND QUALITY OF THE PROPERTIES BUILT, BUT








LIFE LESS ORDINARY LIMITED



Challenging accepted norms of what the increasingly discerning first time buyer market wants from a new home, makes Life Less Ordinary (L-L-O) stand out from the crowd. A boutique property developer specialising in creating well-designed, considered and exceptional new homes, L-L-O began by utilising PDRs to convert derelict offices into modern residential apartments across Zones 3-6 of London, in areas offering the perfect mix of local amenities and strong transport links. This is particularly important for young professionals for whom proximity to leisure and retail is on a par with ease of commuting into the capital. An L-L-O home recognises that a high-specification finish and a functional layout is more important to its target market than redundant hallway space or enclosed kitchens. As such, open-plan living areas are accented with bespoke German kitchens, and homes feature luxury bathrooms and creative colour palettes.
Putting customers at the heart of everything is the key to Bellway’s trusted reputation as a developer of quality homes, with the homebuilder having helped 3,000 first time buyers step on the property ladder since 2021. Customers & Communities and Quality & Safety are two key priorities within the company’s “Better with Bellway” strategy. Excellence in construction and customer satisfaction has led to Bellway retaining five-star builder status with the Home Builders Federation for the seventh consecutive year. Bellway’s Customer First programme is driving further improvements to customer service, while ambitious goals have been set to raise the quality and safety of work to even higher levels. First time buyer Ella White said, “Bellway stood out to us straight away. They were on top in terms of quality of their builds and customer service. Susan and Fiona in the sales office were brilliant and the assistant site manager, Andy, has been amazing.”

Weston Homes, whose motto is “Built with Passion, Delivered with Pride”, delivers quality properties in London and the South East and has won numerous industry awards. Its in-house architectural team combines traditional craft skills with modern methods of construction to create beautiful, energy-efficient homes, such as Abbey Quay in Barking, praised by planners for its design quality. The company’s £40m off-site construction complexes fabricate fully insulated structural wall panels, wardrobes, bathrooms and wall panels, ensuring flawless finishes, customer choice and enable higher quality fixtures and fittings. All properties have a boiling water tap, microwave, dishwasher, fridge-freezer and washer-dryer. Buyers can personalise their home, choosing the worktop, cupboards, vanity unit, tiles and carpets – within the price. Stunning marketing suites, with furnished apartments and scale models, help buyers choose; while initiatives for first time buyers and dedicated customer service ensures they are cared for every step.
Together with its affordable homes registered provider Square Roots, which provides aspirational and affordable solutions to get on the property ladder, London Square builds flourishing new neighbourhoods across Greater London, delivering much-needed homes and bringing communities together. It transforms often neglected areas to create wellconnected places that offer private, affordable, build-to-rent and commercial properties where the whole community can thrive. London Square meticulously considers each land opportunity to ensure high standards of build are met, while also creating exceptional places and communities. Passionate about making high-quality homeownership accessible for everyone, Square Roots schemes offer the opportunity to secure a home with a lower-level deposit using shared ownership. Also offering well considered incentives across private sale developments, the London Square Group offers homes that are uncompromising in design, specification and location.
98 First Time Buyer June/July 2023 READERS’ AWARDS buyer
Sponsored by
BELLWAY
WESTON
LONDON SQUARE
How to vote
VOTE NOW FOR YOUR FAVOURITE IN EACH CATEGORY AT FTBAWARDS.COM


Voting closes at midnight on 18 August 2023. FTB Award winners will be announced during the Awards Lunch at the London Marriott Hotel, Grosvenor Square on 1 September 2023. A full list of winners will be published in the October/November issue of First Time Buyer.

TERMS & CONDITIONS
• Voting closes on 18 August 2023
• Voting is open to First Time Buyer readers, aged 18 and over, with the exception of employees of shortlisted nominees, their immediate families, agents, or anyone else associated with the administration or production of these awards











• Random authenticity checks will be made
Special thanks to o sponsors



AWARD SPONSORS

DRINKS SPONSOR

First Time Buyer June/July 2023 99

UPGRADE YOUR BATHROOM WITH PROOFVISION
Do you often find that your toothbrush has run out of battery just when you need to clean your teeth? Say goodbye to the frustration of a powerless toothbrush with our latest competition! We have teamed up with ProofVision to provide seven lucky readers with the chance to enhance their bathroom and win a stylish in-wall, wire-free, single electric toothbrush charger
HOW TO ENTER
Answer the following question:
Which toothbrushes are compatible with the charger?
Send your answer with your full name, address and telephone number to: lynda@ rsttimebuyermag.co.uk
Closing date: 3 July 2023
THE PRIZE… SEVEN LUCKY WINNERS HAVE THE CHANCE TO WIN A PROOFVISION IN-WALL SINGLE TOOTHBRUSH CHARGER (WITH A CHOICE OF PREFERRED FACEPLATE FINISH)
T&Cs
• *ProofVision chargers can charge Braun and Oral-B electric toothbrushes that work with the Braun Oral-B Advance Power charger (model 3757). This excludes the Oral-B i0 range
• The prizes will be delivered to UK mainland addresses only
• There is no cash or prize alternative
• Seven prizes of a ProofVision In-Wall Single Electric Toothbrush Charger (PV10P) with choice of preferred faceplate nish are available to be won
• Installation is not included with the prize
• The ProofVision Single Electric Toothbrush Charger (PV10P) is suitable for mounting with a 47mm deep, two gang ush metal box. It can be installed in bathroom zone two.
• Installation work should be undertaken by a competent person and if in doubt, consult a quali ed electrician
• ProofVision is not responsible for any bathroom alterations needed to install the charger


• The promoter of this competition is ProofVision
• The promoter of the competition may use the data supplied by entrants to process the competition, including informing the winning participant and to arrange delivery of the prize
• By entering this competition, you agree to the terms and conditions listed above.
Designed to be installed into a wall, like a shaver socket, the ProofVision single electric toothbrush charger (PV10P) will help to streamline your bathroom and ensure your toothbrush has a stylish base to recharge. Furthermore, without the wires on display, your bathroom is clutter-free and easy to maintain, while also saving valuable counter space.

The single charger, which is compatible with both Braun and Oral-B electric toothbrushes*, offers aesthetic, functional and convenient bene ts for the home. What’s more, it can also help you to maintain good oral hygiene habits by ensuring your toothbrush is always charged and ready to use, day or night, exactly where you use it. No longer will you have to worry about running out of battery power just when you need to brush your teeth! Additionally, the ProofVision in-wall, single electric toothbrush charger also offers the added convenience of no longer having to hunt for a traditional charger and a place to charge either.
Offering a perfect blend of style and functionality, the sleek ProofVision single electric toothbrush charger can complement any bathroom decor style, colour scheme or personal preference. Not only does the charger come complete with a white faceplate as standard, it can also be customised with a choice of one of three additional nishes to match your bathroom decor – polished steel, brushed steel or matt black.
Whether you’re embarking on a complete renovation or interested in freshening up your bathroom, the ProofVision single electric toothbrush charger is easy to install into any bathroom space. The single charger is part of the ProofVision TBCHARGE range, which also includes a dual charger (PV11P) that is perfect for couples and families, as well as a single charger with a shaver socket (PV12P),
bene cial for those with an electric toothbrush and shaver.
Visit the ProofVision website for more information and to view the full range of sleek and stylish TBCHARGE electric toothbrush chargers: proofvision.co.uk/
Don’t miss out on the chance to declutter your countertops and remove endless tangled charging cables from your bathroom by winning one of seven ProofVision in-wall single electric toothbrush chargers (PV10P), with a choice of preferred faceplate nish.
Enter now for your chance to enhance your morning routine with a practical and stylish toothbrush charger that offers both convenience and simplicity and will ensure your toothbrush is always charged and ready to use.
First Time Buyer June/July 2023 101 COMPETITION
WIN! APROOFVISIONIN-WALLSINGLE (WITHTOOTHBRUSHCHARGER ACHOICEOFPREFERRED FACEPLATEFINISH) WORTH£56.90
FIRST HOME, FIRST MEAL
Transform classic French ratatouille into a simple savoury tart for only 91p per serving! From Tesco Real Food this vegan and dairy-free recipe is ideal for a stress-free midweek dinner. Rich and sweet, with jammy flavours topping light puff pastry, getting a tasty meal on to your table couldn’t be easier

RATATOUILLE TART
FIX YOUR FOOD WASTE
Got a few leftover slices of bread? An odd onion in your cupboard? Some milk that needs using up?
Make your ingredients go further with Tesco’s "What Can I Make With…" recipe nder tool.





Type in a minimum of three ingredients and this handy online tool will produce multiple options for you to rustle up a meal, so none of your food ever goes to waste.

Today’s sausage stew is tomorrow’s caponata pasta!
realfood.tesco.com/what-can-i-make-with.html

INGREDIENTS (serves 4)
375g pack ready-rolled lighter puff pastry
350g courgettes
1 pepper, cut into chunks
1 onion, cut into chunks
3 garlic cloves, unpeeled
1 tsp herbes de Provence
3 tsp olive oil
75g tomato puree
250g cherry tomatoes, larger ones halved
10g fresh basil
1 Preheat the oven to Gas 7, 220°C, fan 200°C. Unroll the pastr y on to a baking sheet, still on its paper, and score a 2cm border around the edges. Use a fork to poke holes all over the pastry inside the border, then transfer to the fridge.
2 Thickly slice half the courgettes. Put in a bowl with the pepper, onion, garlic, herbes de Provence and 2 tsp oil; season and mix well. Tip on to a lined baking tray. Take the pastry, on its baking sheet, and put in the oven along with the tray of veg. Roast together for 15 minutes.
3 Use a spatula to push down the centre of the pastry. Squeeze the garlic cloves from their skins and mash with the tomato puree and 1 tbsp water, then spread inside the pastry border. Scatter over the roasted vegetables and dot the tomatoes among them. Reduce the heat to Gas 6, 200°C, fan 180°C and bake for 20 minutes more until the tomatoes are soft.
4 Meanwhile, peel the remaining courgette into ribbons; season and toss with 1 tsp oil. When the tart is ready, scatter with torn basil leaves, cut into four and serve with the courgette ribbon salad.
Cook’s tip: No herbes de Provence? Use any dried herbs you have – rosemary, thyme and sage will all work well.
FIRST MEAL 102 First Time Buyer June/July 2023
HOW TO...
Freshen up your microwave

Those ready meals can create quite a smell and seem to cling on to the insides of the microwave!
To get rid of that late night curry you reheated on Saturday night just add a few drops of lemon juice and water to a microwave-safe bowl and place on high for 10 minutes. This allows the steam to ll your microwave. Once you hear the ping be sure to wipe away the softened food that has been clinging to the walls and ceiling with a soft sponge. Ta-da… it will smell fresh and zesty and be just like new!

HOW TO...
Clean your air fryer
If you were taking note in 2022 then you most certainly bought yourself an air fryer! They are so incredibly easy to use and a lot easier to keep clean than the oven. To pave the way to a sparkling clean basket just soak it in baking soda, washing-up liquid and hot water for 10 minutes!

Taking pride in your first home is important and it is always fun to decorate but unfortunately cleaning isn’t on many people's list of enjoyable pastimes! At FTB we know that not everyone is an avid follower of Mrs Hinch, so we decided to put together our favourite simple but necessary cleaning hacks that you can have at your disposal to spruce up your home
HOW TO... Clean your tap
Before moving to a new home no one ever considers what type of water will come from your tap. For those hard water areas, you will need to descale your taps to ensure they remain clear. Just cut a lemon in half and squeeze the esh side on to the end of the tap as far as it will go, securing with an elastic band. This will help to dissolve hard water build up. Leave on for as long as possible and run the tap through when removed! Goodbye limescale!
HOW TO... Clean a saucepan
Ugh! We just hate that residue that gets stuck on to the bottom of saucepans. It’s all very well using one of those lovely sponges, but more often than not you have to chuck that straight in the bin because it can never be used again! We have a simple hack to try – all you will need is a piece of aluminium foil. Roll it into a loose ball and add some water, shaking off the excess. Then start to gently remove the stubborn stains from the pan. It will be so clean you could even use it as a mirror!

HOW TO... Clean your shower head








Let’s face it, no one wants the hassle of removing the shower head and giving it a clean because it will probably be a nightmare to get back on! So, grab a bottle of cola, a sandwich bag and string or elastic. Fill the sandwich bag with cola and then tie the bag around the shower head. Make sure the shower is dry before giving this a go and don’t be wearing socks! You don’t have to use an entire bottle of zzy drink, just enough to cover the shower head, so treat yourself and nish the rest after all your hard work! Leave for as long as possible. When removed, run the shower for a minute and voila! A clean and descaled shower head!
HOW TO...
Get rid of mould in your bathroom
Stubborn mould can be a nightmare to get rid of! Grab toilet paper and any bleach and work the bleach gently into the mould to remove. Be sure to wear gloves to protect your hands and remember that the best way to prevent mould is to air the bathroom after use. Open a window or pop on your fan!

HOW TO...

Banish paper towels
Don’t get us wrong, paper towels certainly do have their uses, from wiping up spills to cleaning up children after their meals. However, there are some things they should never be used for. Cleaning a mirror or windows with a paper towel is all well and good but it will deposit behind dust-like particles which are just a pain. Instead, convert to using micro bre cloths and sponges. You can thank us later!

HOME TIPS First Time Buyer June/July 2023 103
Spotlight on Shared Direction Conveyancing
Shared Direction Conveyancing is the only law firm in the UK dedicated solely to acting for purchasers of new build shared ownership properties
We were previously the new build shared ownership department of Direction Law which, having dealt with some of the earliest shared ownership purchases in the late 1980s, grew to become one of the largest specialist affordable housing solicitors in the country. We have large specialist teams across our three offices in the South East, South West and the Midlands and in the 2022/23 financial year acted for over 3,800 new build shared ownership buyers across the country.
Now, as a stand-alone niche firm, we continue to work closely with and are on the recommended panels for a plethora of dedicated housing associations and selling agents and over the past year our offices have worked with over 180 different housing providers. We are also recommended by a large number of specialist mortgage brokers with whom we have built close working relationships over many years.
Walk around most towns and you will find a firm of solicitors offering conveyancing services. However, the vast majority of these will have little or no experience of affordable housing schemes such as shared ownership. Although it has been around for many years, it is only in more recent years that shared ownership has become more prevalent. However, affordable housing is still only a comparatively small proportion of the overall housing sector, and most solicitors
still see shared ownership conveyancing as more complex than “ordinary” conveyancing. Indeed, those solicitors aren’t wrong, shared ownership conveyancing can be more complicated for a number of reasons:
9 Shared ownership leases contain many provisions that you won’t find in other leases
9 Mortgages must be approved by the housing association the property is being purchased through, and lenders have more detailed requirements
9 The legal paperwork for new build properties is extensive
There are some mortgage lenders who only have a limited number of conveyancing firms on their panel that they trust to act for them on shared ownership cases. A buyer who instructs a firm of solicitors which doesn’t specialise in affordable housing may therefore end up paying two sets of legal fees – their own solicitor’s fees for the conveyancing and their lender’s legal fees too. Housing associations, and the mortgage brokers they work with, will also often have panels of solicitors that they recommend who specialise in shared ownership.
Buyers can be distrustful of using a firm of solicitors who has been recommended, fearing that they won’t be sufficiently independent. Although this is a natural concern and people may often wish to use a
more local firm, buyers should understand that their solicitor is duty bound to act in their best interests and is acting for them not the seller.
Buyers should also keep in mind that, as not all regular high street solicitors are familiar with shared ownership matters, they will probably charge more for the conveyancing and generally take longer when dealing with such cases. Also, because the paperwork tends to be similar for all plots on a development, it is more efficient for a solicitor to act for multiple buyers on a new build estate.
Therefore, using a firm which specialises in shared ownership, especially one which is on a “panel” as explained above, means that you will be looked after by an expert who will most likely charge less and generally proceed quicker than if you used a conventional high street solicitor; you are also more likely to achieve the housing association’s purchase timelines.

If you are buying a new build shared ownership property, Shared Direction Conveyancing is your ideal choice of law firm to share your journey into homeownership, as we have the experience and expertise to guide you through the process as quickly and simply as possible.
For further information visit sdc-legal.co.uk or for an instant quotation call 0808 273 0273
LEGAL
104 First Time Buyer June/July 2023

Making sense of conveyancing quotes

Duncan Horton, Shared Ownership Manager, and Bill Dhariwal, Solicitor and Director, at Lawcomm Solicitors,
to ask a conveyancer before they start on the conveyancing process
For first time buyers, purchasing a property can be a daunting and often confusing experience. Buying a new build or shared ownership property has its own set of challenges, including different Government schemes, an array of financing options and often very tight deadlines.
One of the aspects that a first time buyer will have to contend with is requesting a quote from a solicitor who, once instructed, will complete the legal side of purchasing a property. The legal process of purchasing a property is called conveyancing and is undertaken by a conveyancing solicitor, legal executive or licensed conveyancer. The conveyancing process should result in a first time buyer being registered as the legal owner of their new home.
The conveyancing quote will set out the legal fees being charged as well as the expenses that are payable during the conveyancing process.
So what should first time buyers look out for when they are considering a conveyancing quote?


WHAT IS THE DIFFERENCE BETWEEN A CONVEYANCING QUOTE AND AN ESTIMATE?
The key difference between a quote and an estimate is that a quote will be tailored to a specific client and the solicitor acting will adhere to the agreed costings provided. An estimate is an approximation of the costs involved and may be increased based upon the amount of work involved. Most solicitors provide conveyancing estimates and not conveyancing quotes so that they can increase fees should the transaction become more complex than originally thought. This could arise, for example, if there was a defect in the legal title resulting in additional work.
WHAT INFORMATION DO I NEED TO PROVIDE IN ORDER TO RECEIVE A CONVEYANCING QUOTE?
Typically, a first time buyer will need to provide contact details, the address of
the property being purchased, whether the property being purchased is freehold (usually a house) or leasehold (usually a flat), whether the property is new build or shared ownership and the purchase price.
Most firms will have a conveyancing quote section on their website which will produce an instant quote. By way of example, our firm’s website calculator can be located from our home page at lawcomm.co.uk. All firms, including ours, provide conveyancing quotes for free.


WHAT ARE DISBURSEMENTS?









As well as the solicitor’s fees being charged, the conveyancing quote will set out the expenses payable during the conveyancing process. Sometimes these are referred to as disbursements.
Typically, disbursements will include search fees so searches can be conducted of the local authority, water companies and environmental data to check for various dangers that could impact the property; bank fees for sending same-day money transfers via the CHAPS system; anti-money laundering fees for verifying identification and source of funds; bankruptcy searches which are required by most mortgage lenders; Land Registry fees to ensure the property will be registered at Land Registry and Stamp Duty which, if applicable, is the tax payable to the Government in respect of property purchases.

Items such as acting for lender fee, Stamp Duty fee and leasehold fee are not expenses but part of the solicitor’s fees.
HOW CAN I COMPARE CONVEYANCING QUOTES?
Comparing conveyancing quotes is not always straightforward as solicitors tend to set them out in different ways. However, first time buyers should request a number of quotes from recommended conveyancing solicitors in order to compare
the final costs. Costs as well as experience and recommendation should form the basis of selecting a conveyancing solicitor. First time buyers should always ask whether there are any hidden fees in order that they can budget successfully. Checking the small print is vital.
WHAT IS THE BENEFIT OF A “NO MOVE NO FEE” POLICY?
















At Lawcomm Solicitors we offer a “no move no fee policy”. This means that if a transaction does not complete, for whatever reason, a first time buyer will not be charged for any legal fees and only for any expenses incurred such as search fees. This policy is not always offered by other solicitors but is a significant benefit so worth asking about.

DO CONVEYANCING QUOTES EXPIRE?
A majority of conveyancing quotes will be valid for acceptance for 30 days. A first time buyer may ask for the quote to be extended to try to fix the price and avoid any price increases. A new quote will be required should the purchase property details change. We hope the above will assist first time buyers when requesting and considering conveyancing quotes.
Bill Dhariwal (Solicitor and Director) and Duncan Horton (Shared Ownership Manager) are at Lawcomm Solicitors. For a free conveyancing estimate please do not hesitate to visit our website or contact us on 01489 864 100 or email advice@lawcomm.co.uk
us
LEGAL
look at the questions first time buyers need
106 First Time Buyer June/July 2023
Bill Dhariwal
Duncan Horton

Where there is a Will there’s a way
Lesley Price FCILEx of CGM Hampshire Limited explains the importance of thinking beyond your purchase arrangements to what will happen with your property in the longer term

When you are buying a property it is easy to get caught up in the purchase itself, and we appreciate it is often a point where your funds are stretched. But buying a property is a huge investment and you need to give some thought to what will happen to the property in the future if you separate from a co-owner or if one of you dies.
While it’s a negative thing to think about at a really exciting time, putting the groundwork in place as part of your purchase process will give you and your family an extra layer of security if the worst should happen.
MAKING A WILL
While a Will is not legally required when you purchase, it can make a lot of sense to put one in place at this stage, as for most people their property will be their biggest financial asset.

A Will is a legal document that helps to sort out your affairs and settle your estate in the case of your death. This can be very helpful if there are several possible beneficiaries, as it ensures that your property and belongings are passed
on to the individual(s) of your choice. This can help to minimise tension between beneficiaries and it allows you to ensure that any minor children are cared for financially until they are of legal age.
In a situation where you and your partner die together, having a Will organised will make it much easier to make arrangements for your estate. Organising a Will helps to safeguard your children if the worst does happen, ensuring that they are looked after and that your estate is properly managed. Enlisting the services of a solicitor can be extremely useful when drafting up a Will, as they will ensure that all the wording is legally sound and there are no loopholes that could endanger your estate. Once the Will has been written up it will be permanent unless you decide to change it or draft up a new one entirely
LIFE INSURANCE
If you’re making a Will then most mortgage advisers will recommend that you take out a minimum of life insurance. This is basically a type of insurance that will pay out a lump sum to your dependants should you pass away. It also means that even if you don’t
have a large equity stake in your property, for example if you have a high loan-tovalue or have purchased under the shared ownership scheme, the house would be paid off should you die.
This can be a great means of reducing anxiety for you and your family as your mortgage debt will continue against the property once you pass away and the payments may be too much for the remaining owner or your family to take on.
DECLARATIONS OF TRUST
Problems can occur when there is more than one person who owns the property. It might be the case that a parent and child buy a property together and the child lives in it while the parent lives elsewhere.
In this instance, it is important to draw up an agreement about responsibilities for outgoings on the property and how it will be divided on sale if unequal contributions have been made to the purchase price.
To make enquiries of our Conveyancing or Private Client teams please send your query to us at enquiries@c-g-m.co.uk and a member of the relevant team will get in touch with you
LEGAL
108 First Time Buyer June/July 2023

Third of first time buyers hope to buy within a year but most have yet to seek broker advice, fearing additional costs
Concerningly, in the study of 1,000 aspiring homeowners, three-quarters are yet to consult a mortgage broker, choosing instead to seek advice from parents, friends, their bank, or a financial advisor.
Nearly half feel there is not enough advice available to support them on their homebuying journey.
When asked the reasons for not seeking advice from a broker/mortgage expert, a third said they didn’t feel they were far enough along their savings journey and 23% said they didn’t know what to ask.
31% admitted they would be more likely to seek professional advice if it was free and 24% believe they can’t afford to get advice from a mortgage broker/ adviser.
Cecilia Mourain, Managing Director, Moneybox Homebuying, commented, “With so much market volatility at present, if you hope to buy a house, it’s never been more important to get expert guidance from a mortgage broker, whether you’re a first time buyer or not. And the good news is, you should never have to pay for whole-of-market, unbiased, and commissionfree mortgage advice unless you choose to do so. No matter where you are in your savings journey, if you have questions
about how market conditions might affect your plans, my advice is, do not hesitate to ask your questions to the experts. Learn all you can, as early as you can.”
“Every day, Moneybox Mortgage brokers are supporting people with guidance and advice tailored to individual circumstances, helping them navigate current market conditions with greater confidence, no matter where they are in their journey.”
Among those who had already spoken to a mortgage broker, the majority did so only when they had saved their deposit or were ready to make an offer on a property (30%).
Interestingly, a quarter said they regret not having asked for more expert advice earlier in their savings journey.
With so many many factors affecting the mortgage market in the last six months, perhaps unsurprisingly, 49% of those surveyed by OnePoll think they will now end up buying later than originally hoped.
Yet, motivation and resilience remain high.
Nearly half (48%) of all those surveyed, believe they will succeed in getting their foot on
the property ladder in under two years.
49% are ready to make compromises on the type of property they hope to buy in order to make their dream a reality. 44% are willing to compromise on the location.
And, 32% have decided they are going to continue saving toward their deposit to offset rising interest rates.
“It’s been a tough 12 months for first time buyers and yet, as the leading provider of Lifetime ISAs in the UK, we have clearly seen the desire to own a home is not waning. In fact, people are becoming more intentional
than ever before, committing to their deposit-saving goals with a greater sense of urgency.
More Lifetime ISAs have been opened so far this year than last to avail of the free 25% government bonus on every pound saved and LISA savers have also saved more toward their first home deposit this year than last year.”
Moneybox was voted Best First Time Buyer app at the What Mortgage Awards 2022 for its end-to-end homebuying service which has brought the market-leading Lifetime ISA and free mortgage advice service together into one simple app


LIFETIME ISA
Despite recent economic challenges and volatility in the housing market, 35% of aspiring first time buyers hope to be able to buy within a year
110 First Time Buyer June/July 2023

Don’t let a poor credit score turn your mortgage dreams into a nightmare
James Jones, Head of Consumer Affairs at Experian, looks at why your credit score is so important

Buying your first home is incredibly exciting! From viewing your shortlisted properties, the butterflies that you feel submitting an offer, to the anticipation of waiting for a response from the estate agent. There’s nothing more thrilling than your offer being accepted – but that excitement could quickly turn to despair if, at the 11th hour, the mortgage lender refuses your application because your credit score isn’t up to scratch
A poor credit history is one of the most common reasons for mortgage application problems. That’s why it is important to review your credit report and score before you start your new home search, giving you time to get your credit score in great shape.
WHAT IS YOUR CREDIT SCORE?
Your score is a three digit number that summarises your creditworthiness. It helps lenders determine whether you’re likely to keep up your payments. While there’s no universal score, public-facing scores are available to help guide you on how your past track record shapes up in the eyes of lenders, which can help you discover where you could make improvements. One such guide, the Experian Credit Score, is calculated using your Experian credit report, which many lenders consult. Your credit report covers the past six years and plays an important role in lending decisions.
Experian’s James Jones explains, “If you’re
planning to apply for a mortgage soon, it’s important to check your credit report early in the process.
“If you do find a problem or something that needs work, you can address it before you invite the mortgage lender to put your report under the microscope. You might also identify other ways to improve the picture your credit history paints of your financial track record, to give your application the best possible chance of success.”
EXPERIAN CREDIT SCORE
Experian’s score runs on a scale of 0-999 and is split into five bands: Very poor, Poor, Fair, Good, Excellent. Around 30% of Experian customers have an Excellent score. If your score is Fair or worse, your borrowing options may be limited. You can regularly check your score for free on the Experian website.
MAKE SURE YOU’VE BUILT A CREDIT HISTORY
A credit history can be thought of as a “file” of your recent borrowing behaviour. Some people have “thick files”, some have “thin
files”, and some do not have a file at all. If you have never borrowed, you may have a thin or non-existent file. This means lenders may struggle to predict how reliable you’ll be in the future.
One way to tackle a thin file could be to take out a “credit builder” credit card, use it for occasional purchases and repay the balance in full each month. This could help you build a thick file in three to six months, depending on whether you have any other financial accounts on your report. Eligibility checking tools, such as on the Experian website, can help you find card deals you’re most likely to be accepted for, reducing your chances of applying for one you’re unlikely to be accepted for.
CREDIT SCORES
112 First Time Buyer June/July 2023
HOW TO REPAIR A POOR CREDIT HISTORY
While no two lenders have the same criteria, there are common factors that many agree on. If you have defaulted on previous credit or been taken to court for non-payment of a debt, it’s going to be much more difficult to qualify for a competitive mortgage deal. You’ll be seen as a higher risk customer, which is likely to reduce your options to more expensive deals.
It will help if you have repaid any past debts and made sure your credit report is updated to reflect this. And if you got into difficulties because of unfortunate circumstances, such as losing your job, suffering an illness or going through a messy break-up, you can explain this on your credit report using a “notice of correction”. Simply send your notice (maximum of 200 words) to each of the three main credit reference agencies (Experian, Equifax and TransUnion) asking for it to be added to the credit reports they hold about you.
TOP TIPS TO HELP YOU GET YOUR FINANCES AND YOUR CREDIT HISTORY READY FOR A MORTGAGE APPLICATION


James Jones added, “Mortgage lenders will put your financial behaviour under the microscope, especially transactions in the months leading up to the mortgage application. They will be looking to establish two main things: your financial reliability (your credit score) and your ability to meet future mortgage payments based on your income and spending.”
Check your monthly budget so you have a good idea not only of your income but also your expenditure, as that will also be considered when the lender decides how much you can borrow.
Have your paperwork together. Lenders may ask to see bank statements, payslips and P60 to support your application. Selfemployed borrowers will need to supply their tax self-assessment or accounts depending on the circumstances.
Experian’s mortgage comparison service allows you to compare options from over 90 lenders in the market in under two minutes and provides access to both broker and direct-to-lender exclusive mortgage deals.





















Lenders will carry out a credit check and will also typically credit score your application. If you’re concerned that there could be a blemish on your credit report or feel there may be steps you can take to strengthen it, review your report before your mortgage lender puts it under the microscope – especially given that some lenders have been tightening their lending
1 Previous occupants of your address do not affect your credit score



It is a common misconception that you are financially connected to someone you’ve simply lived with or who lived at your address in the past. In fact, you only become financially connected to someone else if you’ve had joint credit, such as a joint bank account or loan. Credit cards don’t count.




2

Credit reference agencies don’t decide who gets credit
5 TOPSCORECREDIT MYTHS BUSTED!


The three main credit reference agencies compile and store credit reports securely and make these available to lenders, with your permission, when you apply for credit. The agencies don’t make lending decisions; that’s up to lenders, who check the information in the report along with other information such as details from your credit application.
3
You do not have one single credit score


















Each lender uses a unique method to calculate your credit score based on their own experience with customers and on their lending policies. Some even use a different formula for different products, such as mortgages, personal loans and credit cards. Guide scores, such as the Experian Credit Score, are also available to the public.

4


There is not a credit blacklist
Credit reports are simply factual and the majority of the information credit reference agencies hold is actually positive. Even if your credit history includes past missed payments or other negative information, you’ll usually be able to find at least one lender willing to say yes. You’ll probably pay extra though!
5 Checking your own credit report or credit score cannot damage your credit score



You can do this as often as you like. Only when lenders check your report to assess a credit application is a “hard” footprint recorded that can affect your future score. That’s why it’s sensible to limit and space out your applications, and to use a credit eligibility service to help you shop around without collecting multiple hard footprints.
criteria. Obvious issues, such as an old debt not showing as paid or even small anomalies like the way your address is formatted, can delay or even completely derail a mortgage application, so ask for them to be corrected. Register to vote at your current address, which helps confirm your identity to lenders and is widely seen as a sign of stability. Ask for any outdated financial links to other people to be removed, such as an expartner. Otherwise, any financial problems they’re having could hurt your application.
Mortgage lenders look very closely at your existing borrowing. If you have debt on cards, loans and other credit, paying down these balances in the months leading up to your mortgage application could help your application.
Try to avoid opening any new accounts that involve a hard credit check in the

three to six months before you submit your mortgage application. You don’t want to appear overly reliant on credit, or even give the impression that you’ve borrowed some of your deposit from another lender.
Take advice. There are thousands of products on the market from a huge range of lenders. Don’t focus solely on the interest rate as some can carry big fees that could erode the overall value. For example, those with a smaller mortgage may be better to opt for a deal with fewer or no fees.
If you have had problems with credit in the recent past and your score is not great, considering getting guidance from an independent mortgage broker, such as L&C Mortgages, to help you find the best deal for your circumstances.
experian.co.uk
That’s why it’s sensible to limit and space out CREDIT SCORES First Time Buyer June/July 2023 113
Kay Hill looks at the possibilities
According to a recent report by Savills, 46% of first time buyers received help from family members, with the average amount received coming in at a generous £56,150. Another report last year for the Evening Standard found that in the country’s most expensive region, London, this figure rose to nearly two thirds (64.4%) who couldn’t have bought a home without their parents.
There are a surprising number of different ways in which parents, grandparents and sometimes other relatives are able to help – and the good news is that some of them won’t even cost the Bank of Mum and Dad any money upfront. Gifted deposit – this is the most straightforward option, and is widely accepted by mortgage companies. It means exactly what it says; the relative gives the first time buyer the money with no strings attached. The giver will have to sign a legal document confirming that they do not

Family fortunes
expect to be repaid and they have no stake in the property. It is up to the relative how they fund this – from savings or equity release for example – but if they die within seven years of the gift it could still form part of their estate and be liable for inheritance tax. This is not as scary as it sounds, however, as it won’t be the first time buyer who has to pay the tax – it is paid from the estate of the person who dies.
Savings as Security mortgage – sometimes called a springboard, offset or family mortgage, this is a great option as it allows a first time buyer with little or no deposit to still get on the housing ladder, without the parents losing a penny. The helper puts their savings, usually a minimum of 10% of the full purchase price, into a special account with the mortgage lender. It is held as security, usually for a period from three to 10 years, during which time interest will be added but the money can’t be withdrawn.
EXPERT COMMENT


If your parents are able to help out, don’t rule out asking them. It can give you a vital leg up when you’re climbing the savings mountain. If they’re not in a position to give you such a big sum of cash, don’t rule out asking grandparents. If they risk busting the inheritance tax limits it can even help reduce their estate, and protect them from an inheritance tax bill. Or you could ask your parents to help in a way that doesn’t require them to give you any money. This could include being a guarantor on the mortgage. A more attractive alternative might include a specialist mortgage where a parent provides a 10% deposit as a loan. If their offspring meets all the mortgage payments in full and on time for the rst three years, their parents get the loan back in full – with interest. Alternatively, you can use a family offset mortgage, which allows other family members to put savings into an account that’s linked to the mortgage. The savings are offset against the loan, which can be used either to reduce interest payments or shorten the length of the loan. This offers more exibility for parents, and doesn’t leave them open to a liability if their offspring can’t pay the mortgage.
 Sarah Coles, Senior Personal Finance Analyst, Hargreaves Lansdown
Sarah Coles, Senior Personal Finance Analyst, Hargreaves Lansdown







FINANCE 114 First Time Buyer June/July 2023
Nearly half of first time buyers receive financial help from family – but there are many different forms that this can take.
After that time, as long as the first time buyer has made their monthly repayments without issue, the money is released. If the first time buyer defaults in any way, the cash can be taken to recoup the mortgage company’s costs. A variation of this scheme allows parents to forgo interest to reduce the child’s mortgage payments instead.
Joint Borrower Sole Proprietor mortgage – in this scheme the relative’s income is taken into account by mortgage companies when deciding how much to loan a first time buyer. They are on the mortgage and liable for the payments, but are not named on the title deeds, have no legal claim over the property or any increase in its value and there is no additional Stamp Duty to pay. They may opt to contribute towards monthly repayments anyway, but if the first time buyer cannot keep up with repayments they are required to step in and pay the mortgage. Any defaults will also affect their credit rating. A variation on the JBSP mortgage, offered by TEMBO and called a Dynamic Income Boost, allows the parent to gain an equity share in the property by paying part of the monthly mortgage (although they do not live there and it doesn’t affect Stamp Duty reliefs). They can later be removed from the mortgage using a transfer of equity.
Mortgage guarantor – in this scenario, although the guarantor isn’t officially a borrower, they must have income or assets to cover the whole of the mortgage payments if required. The guarantor doesn’t own any of the home and as long as they are not put on the title deeds it will not affect SDLT reliefs. JBSP mortgages have largely replaced the mortgage guarantor. Deposit boost – in this situation, parents or grandparents who may have money tied up in property rather than savings take out a small interest-only mortgage against their own home and the amount is added to the first time buyer’s deposit.

Deposit loan – it is possible to take a loan from parents or family who cannot afford to gift it. Not many mortgage lenders will accept this, however, and they will take the repayments into account during affordability checks and require a proper legal agreement in place.
Equity loan – parents can provide an equity loan, similar to Help to Buy. They provide money for a deposit, but rather than it being a gift they will own a portion of the equity, which will appreciate if housing prices go up. This can be set up legally to avoid additional SDLT, but not all mortgage lenders will accept it as it means an additional charge on the property.
Joint mortgage – it is possible for a first time buyer and a parent or relative to buy a house together, regardless of whether the relative will live there. While this protects
the parent, as they have a share in the value of the home, it is the worst option from a Stamp Duty point of view, as not only will the first time buyer not benefit from first time buyer relief, if the parent already owns a home they will be liable for the added 3% additional property rate of SDLT.
It is good news that lenders are coming up with more flexible and creative ways for parents, grandparents and other relatives to help first time buyers on to the housing ladder, although some of these are quite niche products only offered by a few lenders, so you will probably need the help of a specialist financial or mortgage adviser to find the right deal.
Do also remember to approach any discussions with tact and remember that if family members are unable or unwilling to help, or you would simply rather do it under your own steam, there are other solutions such as shared ownership that might give you the help you need instead.
Mark Bogard, Chief Executive of Family Building Society which offers a range of family assisted mortgages, adds a caveat: “As unpalatable as it may be for some children to swallow, there is no God-given right to parental help. You can argue the moral and parental responsibility case all day long, but if parents want to enjoy most of their retirement being looked after by a kindly Cunard steward, or causing a five-mile tailback as they tow their latest caravan from one countryside beauty spot to another, then so be it.
“It is a simple fact of life that some parents may not feel inclined to simply hand over their hard-won savings or be willing to take out another mortgage (something they may have gratefully left behind some years ago) to help with a property purchase.”
EXAMPLES
Family Building Society – Family Mortgage; 5.14% 5-year fixed rate until 30/09/2028. Maximum LTV 95%, £599 fees. Family members can help by providing savings, income or a mortgage on their own property.
Vernon Building Society – Head Start Lifetime Discount Floored Mortgage. Maximum LTV 100%, JBSP mortgage, always 2.7% below standard variable rate but will not fall below 2.5%, no fees. Variable rate, currently 4.65%.
Barclays – Family Springboard 5-year fixed rate. Maximum LTV 95% at 5.84% or LTV 100% at 5.89%, no fees.
Halifax – Family Boost three-year fixed rate, 4.54%, £100 fees. Helper puts 10% deposit into linked account for three years paying 4.1% interest. Not available on new builds.
We are now at a point in the UK property market where as many as 75% of Britons believe homeownership is out of reach. However, some members of the older generation are in a position to change this by augmenting the buying power of rst time buyers through their own home equity. Our research shows that equity release gifting could help younger generations pay off their mortgages ve years sooner in London, a little over eight years sooner in the South, and even by 12.5 years – half the length of an average rst mortgage – in the East Midlands. Shaving as much as 20% from the time taken to pay off a mortgage in London, one of the most competitive property markets in the world, demonstrates just how useful this tool can be for supporting family and loved ones. Equity release has the potential to make the bank of Granny and Grandad even more of an economic powerhouse in the UK, and potentially the key to lifting so many rst time buyers on to a competitive housing ladder. However, while parents and grandparents are often keen to be generous, this should only be done if they are nancially secure themselves.
Dave Harris, Chief Executive Of cer, more2life





FINANCE First Time Buyer June/July 2023 115
EXPERT COMMENT
What’s in store?
WORLDWIDE RECESSION


According to a report by property portal Global Property Guide, house prices are falling right across the globe. Global Residential Real Estate Market Analysis 2022 found that after several years of strong house price increases, the world’s housing markets are now “slowing dramatically” which it believes isn’t surprising, given the combined adverse effects of increasing interest rates, soaring inflation, global economic slowdown, and supply chain disruptions caused by Covid-19, aggravated further by the crisis in Ukraine. Europe’s housing markets, the report explains, are now “running out of steam” with house prices rising in just eight out of the 29 European countries included the survey, with prices falling in the UK.

HOUSE PRICES IN THE UK
Zoopla’s recent report corroborates Global Property Guide’s findings. Its most recent House Price Index shows that average prices have fallen by 1% since last October and that the quarterly growth rate has been negative for the past three months, the weakest level of quarterly house price growth since 2011. But the report also points out that, despite “weaker market
conditions with house prices falling and homeowners having to forgo some of their post-pandemic price gains”, buyers are still active and agreeing deals with sellers at an increasing rate. Demand for homes is still down on this time last year, but at its highest since October, as the report explains “falling mortgage rates and a strong labour market support buyer interest”.
MORE HOMES ON THE MARKET AND DISCOUNTS AVAILABLE
Zoopla also found that there are now more properties on the market, which it estimates at 65% higher than this time last year, and the average estate agent now has 25 homes on their books compared to a low of 14 this time last year. While levels of buyer demand are 43% lower than a year ago, the number of sales being agreed “subject to contract” are just 16% lower than last year, which Zoopla attributes to “improved choice and greater realism by sellers” supporting sales. The report also found that sellers are cutting sales prices, which it describes as “modest downward adjustments” with asking price discounts averaging at 4% or £14,000, as buyers now have more options. Zoopla points out that sellers have seen “sizable price gains”over the past three years giving them more room to be flexible on agreed prices.
HOMES TAKE LONGER TO SELL
However, Zoopla found that properties are taking longer to sell. Scottish properties currently have the shortest sales periods at 28 days, but homes are marketed with a survey and valuation, compared with London, which has the longest time to sell at 44 days. Ultimately, Zoopla says that today’s buyers are seeking “better value” and it points out that, year
on year, there has been an increase of 5% in the share of sales in the bottom 40% of the market compared to a drop of 4% in the share of sales in the top 40% of the market which the portal believes “indicates continued demand from first time buyers”.
WHAT’S HAPPENING WITH NEW BUILD HOMES?




A new report by the Home Builders Federation (HBF) called Planning for Economic Failure, points to what it calls “the implications of the Government’s antidevelopment approach to housebuilding” and warns that the supply of new build homes could halve and fall to the lowest level since the second world war. The report blames the Government’s “appeasement of its backbenchers, and the free rein given to quangos” which it warns could have “disastrous impacts on housing supply”. The HBF blames planning reforms which will mean that local authorities will no longer be required to plan for the housing needs of its communities. The report also highlighted the growing list of interventions by the quango Natural England – a public body sponsored by the Department for Environment, Food & Rural Affairs, which it suggests could cause the supply of new homes to fall from 233,000 last year to below 120,000 new homes per year in the next few years. This, it points out, is “well under half the Government’s frequently espoused target of 300,000”. The HBF warns that such a fall will have “significant social and economic implications” for the country and will not only deepen the housing crisis but could result in almost 400,00 jobs being lost, over £20bn less economic activity being generated and over £3bn less investment in affordable housing. HBF’s Executive Chairman Stewart Baseley says, “The increasingly anti-development and antibusiness policy environment poses a real threat to housebuilding and is inevitably

MARKET
With reports of worldwide recession making an impact, are British property prices set to fall this year or will more local issues affect the market? Ginetta Vedrickas assesses the situation
116 First Time Buyer June/July 2023
at the forefront of minds when investment decisions are being made.”








RIVER POLLUTION CRISIS AFFECTS HOUSING CONSTRUCTION
The HBF found that one reason for the new build homes shortage is what it calls “the river pollution crisis” as pressure grows on water companies and farmers to address high nutrient levels in rivers, plus Natural England’s “disproportionate ban” on building new homes. HBF’s Lichfields Report blames “ineffective action taken to address the nutrients issue” which has resulted in a quarter of local authority areas in England now having a moratorium on the construction of new homes, leaving over 120,000 homes on hold. It blames water companies for failing to upgrade infrastructure to cope with the growing population, resulting in the dumping of raw sewage into rivers, which it says is “the root cause of the nutrients issue”. Natural England banned any more construction on the basis that a single new property could increase the amount of wastewater generated. But the HBF believes that this fails to address the heart of the issue, as new build homes have more efficient water use compared with older housing stock.
SPIRALLING RENTS MAKE BUYING MORE APPEALING

Most experts agree that buying your first home is daunting, especially when you factor in 2023’s particular constraints such as higher mortgage rates, inflation, energy rate hikes, low wage growth, increased commuting expenses, plus a cost-of-living crisis. Despite the many negatives, Ross Boyd, CEO of mortgage expert Dashly is seeing more first time buyers taking the plunge: “We must remember that many first time buyers would have been renting until now and – with rental

rates at the highest they have been for a long time – those moving to a mortgage will probably see outgoings go down.”


WHAT IS HAPPENING WITH SHARED OWNERSHIP HOMES?
An increasingly affordable way of getting on to the property ladder, the shared ownership sector appears to be relatively robust according to Share to Buy, a portal which lists live properties on the market in London. In March 2022, 3,461 shared ownership homes were available compared with 3,080 available for March 2023. Wendy Hegarty, partner at new homes agent and consultancy Red Loft, says that towards the end of last year, rising property prices plus the costof-living crisis resulted in many hopeful purchasers putting their buying plans on hold – and this was compounded by the end of Help to Buy. She thinks that shared ownership can plug the gap, and has spotted a surge in demand this year as buyers find that mortgage payments are more manageable and rents on the remaining portion are subsidised: “Against the backdrop of rising interest rates, which have increased to the highest level in 14 years to 4.25%, there is a growing need for affordable schemes which enable first time buyers to access properties with a lower deposit.”

EXPERT COMMENT
Shared ownership is going to grow even further as a rst time buyer product over the next 12 months and we expect to see more shared ownership homes being marketed by housing associations, councils and even private developers.
Wendy Hegarty, Partner, Red Loft

EXPERT COMMENT
We are seeing increased activity from rst time buyers. The incremental increase rate rises have pushed some buyers out of the market while others opt for a wait and see approach. But there are opportunities for deals to be done and with fewer buyers in the market there is plenty of room for negotiation.
Ross Boyd, CEO of mortgage expert Dashly

EXPERT COMMENT
The housing market is arguably more balanced than it has been for more than three years. Levels of supply have recovered and buyers and sellers are not miles apart on where they see pricing, and this means deals are being agreed at an increasing rate. Prices are drifting lower compared to a year ago, but fears of a major downturn in prices are overdone.
Richard Donnell, Executive Director, Zoopla





MARKET
First Time Buyer June/July 2023 117
Agony agent










Readers put their property questions to our guest panel of experts: solicitors, mortgage advisers, property gurus and Help to Buy providers
Should I get a mortgage with the economy as it is?

We need your questions...
If you have any queries, or difficulties in understanding the property buying process, our panel of experts is waiting to help. Send our team your questions on buying property, Help to Buy, legal issues, or your financial problems and we’ll find the best person from the panel to give the advice you need.
Email your questions to: lynda@ rsttimebuyermag.co.uk








QI am a first time buyer and I would really like get to get a foot on the housing ladder. But, I am concerned, with the current state of the economy, whether now is the right time to get a mortgage?
 Drew Broadhurst, Manchester
Drew Broadhurst, Manchester




AIf you’re looking to move home now, or in the future, there is never a bad time to review your mortgage options. The earlier you seek expert advice from a broker, the sooner you can understand and consider all the options available to you.
I work with expert mortgage advisers; we know the market and can let you know exactly where you stand. The end of 2022 saw a lot of unrest in the mortgage market and, while the Bank of England base rate has increased, mortgage rates have settled and the mortgage market remains competitive. We are seeing an upturn in the 95% mortgage market, making the deposit hurdle easier to clear.
One key positive we are seeing with the current economic and cost of living issue, is





the development of green mortgage options. Lenders are increasingly willing to lend more on the basis of a highly rating EPC certificate, on the principle that more energy-efficient homes will save buyers money by being cheaper to run. I was recently exploring the options for a couple who were looking to buy their first home. They liked the idea of a new build home but weren’t sure if their budget would stretch that far. Upon further consideration, it emerged that their £55,000 joint income was sufficient to borrow just over £145,000 on a secondhand property yet over £170,000 if buying new. This difference enabled them put an offer on a ready-to-moveinto new home not long after.
I’m not going to pretend that the mortgage market isn’t under pressure in the current economic climate, but there are still options out there. Lending is based on your individual circumstances and credit score, so speaking to an adviser early helps you get an idea of your individual affordability. My advice is to always get mortgage-ready.
 Andrew Mannion
Andrew Mannion


EXPERTS 118 First Time Buyer June/July 2023
THIS MONTH’S PANEL OF EXPERTS
TEST THE PANEL
Richard Taylor, L&NH Area Director South East
Philip WellardHughes, of Sales, Notting Hill Genesis
Head
Andrew Mannion, Group New Build Development Director, Mortgages First & RSC New Homes
Buying off-plan
QI want to buy a new build home, but a lot of the developments I’m looking at are only offering homes off-plan. What does that mean, and how would that affect my buying process?
Cameron Lockyer, Brixton
AIf you’re purchasing a home off-plan, it means that you’ll start the buying process and reserve your home before it’s finished being built.
While the thought of choosing a home without seeing it in person can seem daunting, you won’t be alone in the process –data by the National Association of Property Buyers shows nearly 40% of homes in England and Wales were sold off plan in 2021.
With more and more homes being sold in this way, housebuilders and housing associations (like Notting Hill Genesis) are using innovative technology to bring developments to life and give buyers the confidence to purchase homes without physically seeing them.

For example, at Notting Hill Genesis’ Aspect Croydon, an interactive viewing platform allows potential buyers to explore the development home-by-home, with 360° virtual tours and 3D floor plans. The tool also integrates with our marketing suite, where QR code hotspots can be scanned to reveal a digital replica of a fully furnished apartment.
Most marketing suites will feature fully furnished show homes, allowing buyers to view the specification – such as kitchens, bathrooms, and other fittings like flooring and storage – up close. This will usually be complemented by digital brochures and dedicated websites, providing inspiration to buyers considering how to decorate their homes.
At Notting Hill Genesis, we also offer “hard hat” days to buyers who have reserved a home. Before construction is finished and
What route should I take?
QI am a first time buyer and very keen to get a foot on the property ladder. I am not sure what route to go down but should I buy a new build home?
Chloe Morgan, Harpenden
ABuy a new build home! There are so many benefits for a first time buyers buying a new build home over a pre-owned home, I can only try to mention them all. For starters, new build homes are more energy efficient to run, thanks to more modern insulation, double glazing and heating, making them a cheaper option in the long term.
When it comes to buying new, there’s just more help available to buyers. Developers will often help with the costs of buying one of their new homes, for example by increasing the size of a buyer’s deposit, which could in turn lead to a better mortgage rate, or contributing towards the costs of buying, with help towards legal costs and the set-up costs of a mortgage.

the keys are handed over, you’ll be able to take a guided tour of the development with a chance to view your home in person for the first time.
And there are quite a few advantages to buying off-plan. You will get all the benefits of buying a brand new home, including the newest technology and appliances, greater energy efficiency and lower maintenance than older homes. You’ll also be able to choose from a wider range of properties than if you waited for completion, as many homes are now marketed off-plan and are snapped up before they are built.
For more information, visit nhgsales.com.
Philip Wellard-Hughes
There’s all the extras developers can install too, ready for the big day when buyers move in. Extras can often include flooring, white goods, turf, or even vouchers to enable buyers to go and shop for essential items such as furniture –some of these costs are not always obvious and can soon mount up!
Finally, you also have the benefit of having a home that no one has lived in before and has perfect decoration, so spending the
first few weeks decorating, saving for new carpets or having to use a packing box as a table should be a thing of the past.
When you’re looking at buying your first home it’s definitely worth taking note of all the benefits that developers offer when you buy a new build, they can really make a difference to your overall budget, and help you secure a perfect first home.
Richard Taylor
EXPERTS First Time Buyer June/July 2023 119

Buyers’ guide
FTB EXPLAINS ALL THE OPTIONS TO HELP FIRST TIME BUYERS
Your options
What are your funding options if you want to get on the housing ladder?
FIRST STEPS ARE YOU ELIGIBLE FOR A GOVERNMENTBACKED SCHEME?

The Government backs several schemes to help people get on the property ladder. The best known is shared ownership which is open to people with a household income of up to £80,000 (£90,000 in London). More details are below.
BUYING ON THE OPEN MARKET
Many people buy property on the open market. Homes are offered for sale by estate/sales agents or from private developers or housebuilders. On new build developments there is usually a show home you can look around and a sales adviser, based on site, to answer your questions. To buy on the open market, you will need a mortgage deposit of at least 5% to 10% of the full property value.
BUYING A NEW HOME OFF-PLAN
Demand for new homes often outstrips supply; this means that new homes are often reserved before their construction is complete, sometimes several months before they are built and finished. This is called “buying off-plan”. Most providers market and sell their homes in this way. Do some careful research to make sure the home you reserve is the right one for you, especially as you may not have an opportunity to physically view inside it before your commitment to buy it becomes a legal obligation.
PRIVATE INITIATIVES
Some builders offer incentives on new build homes such as cashback, legal fees or help with moving costs. You could also try to negotiate for upgrades to specification items like floorings or kitchen appliances.
FUNDING OPTIONS SAVING OPTION
GOVERNMENT AND PRIVATE SCHEMES
Help to Buy: Equity Loan/Deposit Unlock
Equity loans through Help to Buy are no longer available; they ended in October 2022. The Home Builders Federation (HBF) together with some housebuilders and mortgage lenders are offering a new scheme called Deposit Unlock as an alternative. This helps first time buyers to buy a new home with a 5% mortgage deposit. More information is available at hbf.co.uk/deposit-unlock
Shared ownership/part-buy, part-rent
The Government-supported shared ownership scheme is available for people with household incomes up to £80,000 (or £90,000 if buying in London.) Shared ownership homes are always leasehold. With this scheme, you buy a share in a property and pay rent on the rest. Rent is calculated at 2.75% (sometimes less), with annual increases of RPI + 0.5%. The amount of share that you buy is calculated based on your affordability. On many shared ownership homes the minimum is 25% (but could be higher). On some homes, you can buy a lower share starting from 10%, but these are not widely available at present. The mortgage deposit you’ll need to buy with shared ownership is calculated on the share value; this works out at a lot less than if you were buying outright. Shared ownership homes can be new build or resales, apartments or houses across many parts of England.
If you buy a home with shared ownership, you will be given the right to buy more shares in the future. This is called staircasing. In most cases, you can buy shares up to 100% of the property and own it outright. When you buy more shares, these are valued at the market value at the time. Because house prices tend to rise over periods of time, it is a good idea to think about staircasing at an early date.
First Homes
This scheme offers first time buyers discounts of 30-50% on certain new build homes. Local authorities may limit these to key workers or those who live or work in the area. When the home is sold it must be to another eligible first time buyer at the same percentage discount.
Rent to Buy
This scheme allows you to rent a new build property for up to five years and pay a redued rent while you save for a deposit. It is not widely available, however.
Right to Buy
The Right to Buy scheme helps eligible council and housing association tenants in England buy their home with a discount of up to £87,200 (£116,200 inside London). You probably have the Right to Buy if you’re a secure council tenant and have spent at least three years as a public sector tenant. Some properties are exempt.
Older People’s Shared Ownership (OPSO)
This is designed for people aged 55 and over. Scheme specific details vary, so check with the housing association provider.
Home Ownership for People with Long Term Disabilities (HOLD)
HOLD is a specialist option to help people with long term disabilities live independently in a shared ownership property where, in some cases, repairs and maintenance services are offered by the provider.
Other options
There are a few less well-known Government-backed schemes; more details can be found at ownyourhome.gov.uk
The Lifetime ISA (LISA) is a long-term savings product intended to support younger people aged between 18-39, resident in the UK, saving for their first home, or for later life. Up to £4,000 can be saved each year, attracting a government bonus of 25% on each new payment. Funds can be withdrawn without charge 12 months after opening the LISA, if used as a deposit for the account holder’s first home, subject to certain conditions. The property value must be under £450,000.
FUNDING OPTIONS
BUYING ON THE OPEN MARKET & PRIVATE INITIATIVES
To buy on the open market or from a house builder you’ll need to get a mortgage from a bank or other mortgage lender. To do so you’ll need to save a deposit and meet the provider’s lending criteria.
First Time Buyer June/July 2023 121
The ftb process
APPLICATION
You will need at least three months of bank statements, payslips or tax returns, photo ID such as a passport or driving licence and details of any loans. Lenders will look at your outgoings to assess how much you can afford to pay on your mortgage each month. The bigger deposit you have and the better your credit score, the better mortgage rate you’ll be offered.
BUDGET
Work out how much you can afford to repay each month, taking into account your normal living expenses and the bills, insurance and council tax on your new home. Don’t forget there is likely to be a service/ estate management charge on a new home, plus ground rent for a leasehold property, so find out how much they will be.
CREDIT SCORE
Get a credit report from Experian or Equifax, and make sure there are no default accounts, CCJs (county court judgements) or missed payments. If you are making lots of enquiries to find the best deal, make sure the lenders log your enquiry as a soft search rather than a hard search as too many applications leave “footprints” on your credit score and can affect your rating. To improve your score, make sure you’re on the electoral roll, and pay your bills and any loan repayments on time.

Buying your first property can be a daunting experience. It’s a big decision, so it’s important to get it right. We take you through all the steps involved
Unless you have enough money to buy a property outright you’ll need a mortgage. A mortgage is a loan used to buy a property and is repayable over a number of years (usually 25-35 years). The loan is “secured” on the property, which means the mortgage lender could repossess your home if you fail to make repayments on time. For this reason, it’s vital only to buy a property you can realistically afford.
Before you start, find out how much money you can borrow. A mortgage adviser will need details of your income, outgoings, savings and credit history – they will then be able to give you an “agreement in principle”, which will state, in theory, how much they will be able to lend you. An agreement in principle, however, doesn’t tie you, or the lender, to anything. Instead, it will just give you a rough idea of how much money you’ll be able to borrow.
You’ll also need a deposit, normally around 10% of the property price. The bigger the deposit, the better the mortgage rate you’ll be offered. Each mortgage product will have a maximum loan-to-value or LTV.
MORTGAGE BROKERS VS LENDERS
You can apply for a mortgage via a mortgage broker (or financial adviser) or direct from a lender. A broker can look at the deals available and advise you which one would be best for your circumstances. Some mortgage products are only sold through brokers, not directly to customers.
A broker will help you with the paperwork and deal with the lender on your behalf up until completion. You may have to pay them a fee or they may earn commission from the lender – find out how they are paid before committing to anything.
Mortgage advisers in banks or building societies can only sell you products offered by that company, so it’s unlikely they will be able to offer you the very best deal for your circumstances. It’s important to shop around. You can compare mortgages online at sites such as moneysupermarket.com or
moneysavingexpert.com, then apply directly to your chosen lender.
FIXED-RATE MORTGAGES
Some mortgages are fixed rate. This means you’ll pay the same rate of interest for a defined period of time, and your payments won’t change. If interest rates go up, you’ll be protected from the increase, but you won’t benefit from any fall in interest rates. Normally, at the end of the fixed period your mortgage rate will revert to the lender’s standard variable rate (SVR) for the rest of the term. You can either pay this rate (which is often quite expensive) or remortgage to another lender. Remortgaging to another lender can sometimes mean you have to pay a fee or early redemption charge (ERC).
VARIABLE-RATE MORTGAGES
Variable-rate mortgages are either linked to the lender’s SVR or the Bank of England base rate, and the rate you pay can change. Lenders can change their SVR whenever they want, but they normally only change it when the Bank of England base rate changes. Tracker mortgages are also variable, but they have repayment rates that are directly linked to the base rate so will go up and down with it. With variable-rate mortgages you need to be sure you could afford higher repayments if rates rise.
REPAYMENT OR INTEREST-ONLY
Most mortgages available to first time buyers are on a repayment basis. With this type of mortgage, every monthly payment will pay off some interest and some capital (mainly interest in the early years). At the end of the term, you’ll own your home outright.
If you have a larger (25% or more) deposit you may be offered an interest-only mortgage, where you only pay interest on the loan. The monthly repayments are lower but at the end of the term you’ll still owe the original mortgage sum. You’ll need to prove you have a plan in place (such as an investment) to pay off the capital.
Check out crime statistics, transport links, regeneration and, if relevant, schools.
BUYERS’ GUIDE 122 First Time Buyer June/July 2023 SET A BUDGET Work out how much money you have for fees, deposit and the monthly mortgage you can afford. CREDIT SCORE Make sure your credit rating is sound and there are no mistakes on your le, and pay off any debts you can. SHOP AROUND Speak to a mortgage broker, but also look at lenders’ direct products and search the internet. DECIDE ON A LOCATION
practical.
about
commuting time
can afford to buy in the area. RESEARCH THE AREA
Be
Think
the
and whether you
FINANCE RESEARCH
Finance
TIPS
LOCATION IS KEY
The first step is to shortlist the locations you feel you’d like to live in, then check if you can afford the house prices in those areas. It’s also worthwhile visiting places you like: it may be that there’s an up-and-coming hot spot just down the road you didn’t know about that’s much more affordable. Ideally, you will have rented in the area before buying, but if this isn’t the case, at least spend some time there, check out the commuting time to work, and look at local pubs, shops and leisure facilities. Visit the area at night, too.
PROPERTY SEARCH
Once you have found the right location, go online and check out what’s on offer. Most homes are listed on property portals such as rightmove.co.uk, onthemarket. co.uk, or zoopla.co.uk, plus estate agents’ websites. Properties featured have pictures, descriptions and a floor plan, and
SEARCH Register with local estate agents, and use the internet to search for properties. Set up alerts.
sometimes a video. Also, sign up with as many local estate agents as you can. They should send you new properties that match your description, but it’s worth phoning them regularly. If you’re looking for a shared ownership property, search online at sharetobuy.com and propertybooking.co.uk.
VIEWING
Once you see a property you like, arrange a viewing. Most people see at least 10 properties before putting in an offer. It’s worth bringing a friend or relative and also arranging a second viewing to check out any bits you may have missed. Don’t get taken in by the furnishings and decor too much. Remember that a property that is slightly run down can still be a great investment and may only need a touch of paint and a change of furniture.
ESTATE AGENTS
It’s a buyers’ market, so make use of agents’ legwork in finding properties that fit your requirements. Be aware that estate agents are paid commission by the seller on the sale, so try to inspect the property yourself rather than just the parts the agent shows you. Don’t get sucked in by the hard sell.
RESEARCH AN AREA
Check online for prices of sold properties in the area, and make sure properties you like fit your budget. You can search for recent sold prices of property in any area at nethouseprices.com, and also on property portals like rightmove.co.uk/zoopla.co.uk.
Aerial shots of an area can be viewed at google.co.uk/maps; switch to “satellite view”.
Before you put in an offer, visit the street at different times of the day and night. You could also ask neighbours and local shop owners about the area.
BEFORE YOU BUY
When looking at buying apartments, check exactly what is included in the service charge and how much it is. Also, ask about the terms of the lease and its length. If the lease has less than 80 years left, use this as a negotiating tool and make an offer below the asking price.
VIEWINGS
Look at several properties, and visit ones you like more than once and with someone else. Take a checklist.
OFFER
If the market is slow, when making an offer, don’t be afraid to offer less than the asking price. If the property needs work done, you can use this as a negotiating tool.
BUYING
SURVEY
Make sure you have a survey – it could save you money in the long run by spotting any problems.

SOLICITORS
Compare quotes from solicitors, and ask your friends who they recommend. A good solicitor can make a big difference to whether a purchase completes or falls through. Online companies can be cheaper but are less personal.
SEARCHES
Look at the results of searches your solicitor has done. They will tell you, for example, if a main road is about to be built at the end of your garden.
BUYERS’ GUIDE First Time Buyer June/July 2023 123
TIPS
Buying a property is a big investment. You need to make sure you buy a home that you can afford and one you will be happy living in.
Thorough research
TIPS
A QUICK SALE
Push the seller to take the property off the market. This will limit the chances of being gazumped (another buyer making a larger offer). The seller can insist on continuing to show the property, especially if you haven’t offered the asking price.
Use a recommended solicitor who you know to be reliable and who can move fast.
Never get pressured into an exchange and completion date without knowing all your finances and documents are in place. If you can’t complete, you may have to pay the seller’s costs.
English property law is different to Scottish law: in England, if you put in an offer and then have a change of heart, you can legally back out of the deal or negotiate up until the exchange date. But, in Scotland, an agreed price is binding.
INSURANCE
You must have buildings insurance in place for when you exchange contracts (not complete). This will be a condition of your mortgage offer.
SURVEYS AND VALUATIONS
Buying process
Once your offer is accepted, tell your mortgage lender. They will do a valuation to ensure the property is worth the money being advanced. At the same time, instruct a surveyor to carry out a survey. If this shows problems, find out how much they would cost to rectify and use this information to renegotiate the sale price. Or, tell the seller certain repairs need to be carried out before contracts are exchanged.
SOLICITORS
After the offer is accepted, you will also need to appoint a solicitor or conveyancer who will oversee the contract, deal with the finances and exchange the deeds. Your solicitor will carry out searches, check the terms of any lease and restrictive covenants and tell you how much Stamp Duty you have to pay. The seller will also appoint a solicitor, and the two legal teams will be in regular contact to make sure the purchase goes as smoothly as possible.
EXCHANGE AND COMPLETION
Once the mortgage offer is in place, the contract is satisfactory and buildings insurance has been organised, both parties will agree an exchange date. You will sign the contract with your solicitor, and at the point of exchange of contracts, you pay a deposit and a completion date is set. At this point, there’s no going back – the seller could sue you if you pull out, and you could lose your deposit. The completion date is usually around a week to 10 days after exchange, but can be done on the same day. On completion, the final paperwork is done, and the property is legally yours.
TIME SCALE
From offer to completion usually takes about six weeks to three months, but don’t feel pressured or rush into anything you’re not sure of just because the seller or estate agent wants you to exchange.
BUYERS’ COSTS
SOLICITOR’S/CONVEYANCING COSTS (ESTIMATED)
£1000-£1,800
LOCAL AUTHORITY SEARCH FEES (ESTIMATED)
£150-£300
LAND REGISTRY FEES:
Scale 1 fees relate to the registration of both new builds and resale properties for monetary consideration.
Apply using the portal or Business Gateway, for transfers or surrenders which a ect the whole of a registered title
For a purchase of £0 - £80k £20.00
For a purchase of £80,001-£100k £40.00
For a purchase of £100,001 - £200k £100.00
For a purchase of £200,001 - £500k £150.00
For a purchase of £500,001 - £1,000,000 £295.00
For a purchase of £1,000,001 and over £500.00
Apply using the portal or Business Gateway, for registration of all leases and transfers or surrenders which a ect part of a registered title
For a purchase of £0 - £80k £45.00
For a purchase of £80,001-£100k £95.00
For a purchase of £100,001 - £200k £230.00
For a purchase of £200,001 - £500k £330.00
For a purchase of £500,001 - £1,000,000 £655.00
For a purchase of £1,000,001 and over £1,105.00
STAMP DUTY LAND TAX (SDLT) (UNTIL 31/09/2022):
Up to £250,000 Zero
The next £675,000 (the portion from £250,001 to £925,000) 5%
The next £575,000 (the portion from £925,001 to £1.5 million) 10%
The remaining amount (the portion above £1.5 million) 12%



In October 2022 you buy a property for £295,000. The SDLT you owe will be calculated as follows:
0% on the first £250,000 = £0

5% on the final £45,000 = £2,250
Total SDLT = £2,250
OTHER FEES TO CONSIDER (ESTIMATED, DEPENDENT ON CIRCUMSTANCES):
MORTGAGE ARRANGEMENT FEE
Expect to pay a fee of at least £1,000 to secure an attractive rate. But some can be £2000+
The lender will usually o er you the option to pay the arrangement fee upfront, or you can add the fee to the mortgage. The disadvantage of adding the fee to the mortgage is you’ll pay interest on it, as well as the mortgage, for the life of the loan. But if you pay the fee upfront, there’s a chance you could lose it if anything went wrong with the purchase.
MORTGAGE VALUATION
Typically, around £300-£600, but can be significantly more
MORTGAGE BROKER’S FEE

£0-£500 usually paid at mortgage application
BUILDINGS INSURANCE
Estimate £200-£300 annually – The price depends on the cover you require and your excess. The building insurance is calculated based on the cost of rebuilding your home is known as the ‘buildings sum insured’. It’s important to know that there’s likely to b a di erence between your home’s market value and the cost of rebuilding your home.
GROUND RENT (LEASEHOLD ONLY) & SERVICE CHARGES

£700-£4,000 annually
If you own a long lease on a property in England and Wales you will normally have to pay rent to the freeholder or landlord of the property; this is known as Ground Rent. The lease will normally specify how much rent you have to pay and when it has to be paid. The ground rent can be a fixed sum for the length of the lease, or the lease can provide for the ground rent to increase over the course of the lease. Service charges vary based on the building and the services provided. A building with concierge service, numerous lifts can be very expensive. You should go through the service charge costs with your solicitor. These are audited and the price paid changes annually generally in April. New freehold homes may also have service/estate charges for maintenance of communal areas.

REMOVALS
Shop around for a removals rm, and nd one that can move your possessions on completion day. You could also look at van hire to do it yourself.
COMPLETION
Your solicitor or estate agent will call you to tell you the property is yours. The solicitor will have some nal paperwork to do, and you will then have to pay the solicitor’s bill and your Stamp Duty payment (if applicable). solicitor’s bill and your Stamp
REMOVALS (IF REQUIRED)
£500-£2,500
BUYERS’ GUIDE 124 First Time Buyer June/July 2023
Home buying glossary
Confused by financial acronyms and industry terminology? Buying your first house is daunting enough without having to decode property lingo. FTB’s homebuying glossary is here to make the process a whole lot easier to understand
AGREEMENT IN PRINCIPLE
The initial document that a lender will give you outlining the amount you are likely to be lent if you applied for a mortgage. An agreement in principle is not a guarantee of getting a mortgage.
APR
APR stands for annual percentage rate. It is the interest rate you’d pay over a year. It takes into account not just the interest on your loan but also any other additional charges.
ARREARS
This is a term used to describe payments that haven’t been made on time.
BASE RATE
The interest rate set by the Bank of England. Lenders usually use the Bank of England base rate to set their own interest rates.
BROKER
A broker is someone who gives you advice on your mortgage. Some are independent, while others work for particular lenders.
BUILDING SURVEY
A survey carried out by a qualified surveyor to spot any structural problems or faults in the home you are buying.
COLLATERAL
Something of value that is offered as a guarantee against a loan. With mortgages, your home is collateral.
COMPLETION
The finalisation of the sale. Completion day is when the paperwork is complete, all money is transferred and you become the legal owner of your new home.
CONVEYANCING
The legal process of transferring ownership of a property.
DISBURSEMENTS
These are additional charges incurred during the homebuying process such as Stamp Duty and Land Registry charges. You must give the money to your conveyancer or solicitor who will then pay the charges on your behalf.
EARLY REPAYMENT CHARGE
This is an amount of money you may have to pay a lender if you decide to move mortgage provider or if you pay off your mortgage quicker than expected.
EQUITY
The difference between the value of the property and the value of the mortgage you have secured.
EXCHANGE OF CONTRACTS
This is when you exchange contracts with the seller. When this has happened, both sides are legally bound to complete the transaction.
FREEHOLD
A freehold is when you fully own a property and the land it stands on.
GAZUMPING
When a seller accepts an offer and then later on rejects it in favour of a higher offer from another bidder.

GUARANTOR
A person, usually a parent, who guarantees that you can pay your mortgage repayments. You often need a guarantor if you are struggling to get a mortgage based on your own income. If for some reason you cannot pay your mortgage, your guarantor has to pay it for you.
HIGHER LENDING CHARGE
If you take out a large mortgage on a property, some lenders may charge a one-off extra fee. This funds an insurance policy that protects the lender (not you) from the additional risk.
LAND REGISTRY FEES
This is a fee you have to pay in order to register your ownership of the property with the Land Registry.
LEASEHOLD
A type of tenure where you buy the right to occupy a property for a fixed period of time. You usually have to pay annual ground rent each year.
LTV
This stands for loan to value – the ratio between the amount of money you have taken out as a loan and the valuation price of the property.
LUMP-SUM
REDUCTION
In order to reduce your mortgage, you can make a lump-sum reduction. This is where you pay more than you owe each month in mortgage repayments.
REDEMPTION
Paying off your mortgage in full is known as redemption.
REPAYMENTS
The amount you have to pay back each month to your mortgage provider
STAMP DUTY
Stamp Duty is a shortened name for Stamp Duty Land Tax, also called SDLT. This is a Government tax you may have to pay when you purchase a new property. Your solicitor or conveyancer will organise the payment for you.
TITLE DEEDS
The legal documents that outline your rights and liabilities in relation to your new property. The title deeds also act as proof of ownership.
BUYERS’ GUIDE First Time Buyer June/July 2023 125
Common questions from a first time buyer about conveyancing
As a first time buyer you will no doubt have many questions regarding the conveyancing process. Coralie Phelan, Partner at Prince Evans Solicitors LLP, looks at the common questions asked by first time buyers during the process


Q What is conveyancing and why do I need a conveyancer?
Conveyancing is the legal process of transferring land from one party to another. You will need a conveyancer to act on your behalf and your lender’s behalf to check that you will acquire a good and marketable title to the property to enable you to sell and mortgage the property without difficulty in the future.
Q How much should I budget for conveyancing fees?
Every firm will charge differently and
it is important to check any small print and to understand fully what the firm is charging. You should budget for between approximately £1,000 to £1,800 plus disbursements (payments to third parties such as the Land Registry) and Stamp Duty Land Tax.
Q
Who will be my point of contact throughout the process?
It is worth considering whether you value a more personal service, where you deal with one conveyancer throughout, or whether you prefer a firm that has a more modern
approach, with different conveyancers dedicated to dealing with each stage of the transaction.
Q
Is there anything I can do to make sure the process runs smoothly? Keep in regular contact with your mortgage adviser and conveyancer and the sales office or estate agent to ensure you are fully abreast of all developments.
Q How often will I receive updates?
Most firms will update you via email or phone depending on your preferences. At
LEGAL 126 First
June/July 2023
Time Buyer
Prince Evans we are one of a few firms who use an app to update our clients. It is worth enquiring regarding the frequency and method of updates at the quotation stage so you can ensure your appointed firm meets your expectations in this respect.

QWhen do I need to pay the conveyancing fees?



Most firms will ask you to pay between £200 and £300 upfront to cover the cost of searches. The deposit (usually 10% of the purchase price) will be requested on exchange and the balance due on completion. The balance of legal fees is usually due for payment no later than one working day prior to completion. You will usually receive an invoice between exchange and completion setting out the balance due from you, otherwise known as the completion statement.
QHow long does the conveyancing process take?
If you are purchasing a new build the developer or seller will usually expect exchange of contracts (the point of legal commitment) to occur within 28 to 42 days. If you are purchasing a resale property then this could take anywhere from three to six months or sometimes even more depending on the position of all parties in the chain. It is impossible to be precise with conveyancing timeframes as there are so many different third party elements that could affect the timeframe.
QIs the conveyancer familiar with a case like this – for example affordable housing conveyancing?
It’s crucial to ask this question and ensure your conveyancer is an expert in the area in which you are purchasing. For example you should consider instructing affordable homeownership experts if you are purchasing a shared ownership property.
Q Is the conveyancer suitably qualified and experienced?
A conveyancer could be a qualified solicitor, Licenced Conveyancer or a paralegal. You should check you are satisfied that your conveyancer has suitable experience before instructing them.
Q Do I need to instruct a conveyancer in the local area?
It isn’t necessary to instruct a solicitor in
the local area as all conveyancers in the UK can act on property purchases in England and Wales where the conveyancing process is the same. If you are instructing a solicitor who isn’t near to where you live or work do check with them it won’t be necessary to visit their offices to sign papers.
QI’m currently renting – when should I hand in my notice?
It is crucial to time this right to avoid firstly handing notice in too early and making yourself homeless and secondly too late and paying rent and service charge on both properties. Generally your conveyancer will advise you to wait until exchange of contracts when a fixed completion date can be agreed before handing notice in and then negotiating a suitable period between exchange and completion to avoid having to pay double rent and service charge.
QCan a conveyancer act for both buyer and seller?
This question is sometimes asked as it appears that this would be quicker and easier, but the answer is no. A conflict of interest could arise for example if the buyer’s solicitor has to act for both buyer and lender or if there was a title query. Each party needs to be independently advised to ensure a conflict of interest does not arise.
QWhat is the difference between exchange and completion?
The exchange of contracts is the point when there is a legally binding contract between the parties. Completion is the day that monies are transferred between solicitors and you can collect your keys and move in. Generally there is about one to two weeks between exchange and completion.
QWhat are standard searches?
Standard searches usually consist of a local search, which searches for matters in the local authority records such as planning and building regulation history, road adoption and adverse matters that might
affect the property such as compulsory purchase schemes. Your conveyancer may also recommend a drainage and water search and environmental search.
QWhy do I need to provide proof of deposit if I have already provided this to my mortgage adviser and lender? The Proceeds of Crime Act and Anti Money Laundering legislation and conveyancing regulations hold your conveyancer to an often higher standard and more onerous obligations in terms of anti-money laundering checks than that of your mortgage adviser or lender. So you should ensure you have your bank statements and records of how you obtained your deposit funds readily available to supply to your conveyancer.
QWhen do I get the deeds to my property?
The legal documents or deeds are held electronically at the Land Registry and physical deeds and documents are now largely obsolete. The title information document proving the ownership of land is a public document that is available to download. Your conveyancer will send your copy of the title following registration. The Land Registry has incredible backlogs at present and as a result it could take several months before the Land Registry confirms that your ownership has been registered. As this is largely an administrative process, this delay is nothing to be concerned about.
There is no single best or most important question to ask during the conveyancing process. It is worth ensuring you ask any questions you have to enable you to understand the process properly before legally committing and embarking on your journey into homeownership. Your conveyancer will want to help you complete your purchase without any issue and will therefore be happy to answer any questions no matter how small.
LEGAL First Time Buyer June/July 2023 127
Prince Evans specialise in all aspects of conveyancing.
or nbh@prince-evans.co.uk
Please contact Prince Evans for all your conveyancing needs and for a friendly no obligation quote on 020 8567 3477
CHECK WHICH SCHEME IS RIGHT FOR YOU!

With a range of Government schemes available to make buying a home more affordable, find out which scheme is right for you.
SHARED OWNERSHIP
If you can’t quite afford to buy 100% of a home, you could buy a share of a home instead and pay rent on the rest.
SHARED OWNERSHIP RESALES




If you can’t afford to buy a whole home, you could buy the same share of a home bought by its current owner when they used a shared ownership scheme.
HOME OWNERSHIP FOR PEOPLE WITH LONG-TERM DISABILITIES (HOLD)




If you have a long-term disability, the HOLD scheme in England could help you buy any home for sale on a shared ownership basis.
OLDER PEOPLE’S SHARED OWNERSHIP (OPSO)


If you’re aged 55 or over, the OPSO scheme could help you own up to 75% of any home that’s for sale on a shared ownership basis.
FIND OUT MORE
For a more detailed description of each scheme please visit ownyourhome.gov.uk


FIRST HOMES
A new scheme supporting local rst time buyers, including key workers, on to the property ladder by offering new build homes with at least a 30% discount compared to market prices.

RENT TO BUY/LONDON LIVING RENT
Rent to Buy gives tenants in England the chance to rent a home at Intermediate Rent, providing them with the opportunity to save for a deposit over time to purchase the home.
The scheme is available in England, apart from London. Properties in London are covered by a separate scheme called London Living Rent.
THE MORTGAGE GUARANTEE SCHEME


A UK-wide Government scheme to help to increase the supply of 5% deposit mortgages for credit-worthy households by supporting lenders to offer these products through a Government-backed guarantee
on new 95% mortgages.
RIGHT TO BUY


If you’re a council tenant in England, the Right to Buy scheme could help you buy the home you rent with a discount of up to £87,200 (£116,200 in London).
PRESERVED RIGHT TO BUY
If you’re a housing association tenant in England you could be eligible to buy the home you rent with a discount of up to £87,200 (£116,200 in London).





STAMP DUTY LAND TAX RELIEF




Stamp Duty Land Tax (SDLT) is a tax on property purchases. First time buyers pay a reduced rate of zero SDLT on the rst £425,000 and 5% on the amount between £425,001 and £625,000. No discount applies on homes over £625,000. The level of relief will be reduced from 1 April 2025.

128 First Time Buyer June/July 2023 Directory INFORMATION PROVIDED BY OWNYOURHOME.GOV.UK















USEFUL CONTACTS First Time Buyer June/July 2023 129 Find your place peabodysales.co.uk come home to A place to ADVERTISE HERE Speak to our advertising team to find out the best ways to give your organisation maximum exposure. Call 020 7258 0036 or email lynda@firsttimebuyermag.co.uk

HOMEBUYING PROVIDERS – OFFERING NEW BUILD SCHEMES, INCLUDING SHARED OWNERSHIP AND RENT TO BUY PROPERTIES
LONDON
Catalyst Housing catalyst.homes
0333 444 3500
Latimer myclarionhousing.com
Need to find number
Estuary Housing Association estuary.co.uk
0300 304 5000
Fabrica fabrica.co.uk
0800 783 2159
020 8825 1000
Gateway Housing Association gatewayhousing.org.uk
020 8709 4300
Guinness Partnership guinnesspartnership.com
0303 123 1890
Hexagon hexagon.org.uk
020 8778 6699
Home Group homegroup.org.uk
0345 141 4663
Hyde New Homes hydenewhomes.co.uk
0345 606 1221
Islington and Shoreditch Housing Association isha.co.uk
0300 131 7300
L&Q lqhomes.com
0300 456 9997
SO Resi soresi.co.uk
020 8607 0550
Newlon Living newlonliving.co.uk
0800 058 2544
Notting Hill Genesis nhgsales.com
020 3797 0295
Nu Living nuliving.co.uk
020 3151 3394
Octavia Housing octaviahousing.org.uk
020 8354 5500
Optivo optivo.org.uk
0800 012 1442
Origin Housing originhousing.org.uk
0300 323 0325
Paradigm Housing paradigmhousing.co.uk 0300 303 1010
Peabody peabodysales.co.uk
020 7021 4842
Places for People placesforpeople.co.uk
01772 667 049
Sanctuary London sanctuary-homes.co.uk
0800 916 1444
Site Sales site-sales.co.uk
020 8502 5758
Shepherd’s Bush Housing sbhg.co.uk
020 8996 4200
Southern Home Ownership shosales.co.uk
0300 555 2171
Swan Housing Association swan.org.uk
0300 303 2500
Wandle Housing Association wandle.com
0300 200 0120
SOUTH EAST
Accent Group accentgroup.org
0345 678 0555
Aster Group buyanasterhome.co.uk 01380 735 480
CHP chp.org.uk
0300 555 0500
CHS Group chsgroup.org.uk
0300 111 3555
Latimer myclarionhousing.com
020 7378 5638
Crown Simmons crownsimmons.org.uk
0300 303 1064
Estuary Housing Association estuary.co.uk
0300 304 5000
Fabrica fabrica.co.uk
020 8825 1000
Flagship Homes flagship-homes.co.uk
0808 169 9297
Guinness Partnership (South) guinnesspartnership.com
0303 123 1890
Hastoe Housing Association hastoe.com
0300 123 2250
Home Group homegroup.org.uk
0345 141 4663
Housing Solutions Group housingsolutions.co.uk 01628 543101
Hyde New Homes hydenewhomes.co.uk
0345 606 1221
L&Q
lqhomes.com
0300 456 9997
SO Resi soresi.co.uk
020 8607 0550
Moat
moat.co.uk
0300 323 0011
Notting Hill Genesis nhgsales.com
0333 000 4000
Nu Living nuliving.co.uk
020 3151 3394
One Housing Group onehousing.co.uk
0300 123 9966
Optivo optivo.org.uk
0800 012 1442
Origin Housing originhousing.org.uk
0300 323 0325
Orwell Housing Association orwell-housing.co.uk 0345 601 0030
PA Housing pahousing.co.uk
0300 123 2221
Paradigm Housing paradigmhousing.co.uk
0300 303 1010
Peabody peabodysales.co.uk
020 7021 4842
Places for People placesforpeople.co.uk
01772 667 049
Rosebery Housing Association rosebery.org.uk
01372 814 000
Sanctuary South East sanctuary-housing.co.uk
0800 131 3348
Soha Housing Soha.co.uk
01235 515 900
Southern Home Ownership shosales.co.uk
0300 555 2171
Sovereign Housing sovereignliving.org.uk
0300 500 0926
Stonewater stonewater.org
01202 319 119
Swan Housing Association
swan.org.uk
0300 303 2500
SO Resi soresi.co.uk
020 8607 0550
Town and Country Housing tchg.org.uk
01892 501 480
Worthing Homes worthing-homes.org.uk
01903 703100
SOUTH WEST
Aster Group buyanasterhome.co.uk
01380 735 480
Cornerstone Housing cornerstonehousing.net
01392 273 462
CURO curo-group.co.uk
01225 366 000
Elim Housing elimhousing.co.uk
01454 411 172
Green Square greensquaregroup.com
03001117000
Guinness Partnership (Hermitage) guinnesspartnership.com
0303 123 1890
Hastoe Housing Association hastoe.com
0300 123 2250
Places for People placesforpeople.co.uk
01772 667 049
Rooftop Housing Group rooftopgroup.org
01386420800
Sanctuary Southwest sanctuary-housing.co.uk
0800 131 3348
Sovereign Housing sovereign.org.uk
0300 500 0926
Stonewater stonewater.org
01202 319 119
Westward Housing westwardhousing.org.uk
0300 100 1010
MIDLANDS
Accent Group accentgroup.org
0345 678 0555
Green Square Accord greensquareaccord. org.uk
0300 111 7000
Acis Group acisgroup.co.uk
0800 027 2057
Bromford Group bromford.co.uk
0330 123 4034
Clarion Housing myclarionhousing.com/ sharedownership
03005008000
EMH emhhomes.org.uk
0300 123 6000
Long Hurst Group longhurst-group.org.uk
0300 123 1745
Home Group homegroup.org.uk
0345 141 4663
Guinness Partnership (Northern Counties) guinnesspartnership.com
0303 123 1890
Midland Heart midlandheart.org.uk
0345 602 0540
Muir Group muir.org.uk
0300 123 1222
Nottingham Community Housing Association ncha.org.uk
0800 013 8555
USEFUL CONTACTS First Time Buyer June/July 2023 131
SUBSCRIPTION OFFER!


Four issues for just £14



Please call our subscription team on 020 3488 7754






























1 issue £3.95 (Free P&P)




4 issues £14 (Free P&P)
6 issues £21 (Free P&P)


SUBSCRIPTIONS
Orbit orbitcustomerhub.org.uk
0800 678 1221
Places for People placesforpeople.co.uk
01772 667 002
Riverside Housing Association riverside.org.uk
0345 155 9029
Rooftop Group rooftopgroup.org
01386420800
Sanctuary Midlands sanctuary-housing.co.uk
0800 131 3348
Homes Plus homesplus.co.uk

08000488955
NORTH WEST
Accent Group accentgroup.org
0345 678 0555
North Jigsaw Homes northjigsawhomes.org.uk
0300 111 1133
Arcon Housing Association arcon.org.uk
0161 214 4120
CDS Co-operatives cds.coop 0204 551 0080










Eden Housing Association edenha.org.uk
01768 861 400

Equity Housing equityhousing.co.uk
0300 123 4460
Guinness Partnership (Northern Counties) guinnesspartnership.com
0303 123 1890
Home Group homegroup.org.uk
0345 141 4663
Riverside Housing Riverside.org.uk 0344 873 6290
Irwell Valley Housing Association irwellvalley.co.uk
0300 561 1111
Knowsley Housing Trust k-h-t.org
0151 290 7000
Livv Housing Group livvhousingroup.com
0151 290 7000
Onward onward.co.uk
0300 555 0600


Muir Group muir.org.uk
0300 123 1222
Places for People placesforpeople.co.uk
01772 667 002
Progress Housing Group progressgroup.org.uk
0333 320 4555
Regenda Homes regenda.org.uk
0344 736 0066
Riverside Housing Association riverside.org.uk
0345 155 9029
Sanctuary North sanctuary-housing.co.uk
0800 131 3348
Your Housing Group yhghomes.co.uk
0845 163 4689

YORKS/ HUMBER
Accent Group accentgroup.org
0345 678 0555
Acis Group acisgroup.co.uk

0800 027 2057
Broadacres broadacres.org.uk
01609 767 900
Crucible Homes cruciblehomes.co.uk
0114 241 3433
Guinness Partnership (Northern Counties) guinnesspartnership.com
0303 123 1890
Home Group homegroup.org.uk
0345 141 1663
Leeds Federated Housing Association lfha.co.uk
0113 386 1000
Longhurst Group longhurst-group.org.uk
0300 123 1745

Manningham Housing Association manninghamhousing.co.uk
01274 771 144
Muir Group muir.org.uk
0300 123 1222
Places for People placesforpeople.co.uk
01772 667 002
Together Housing togetherhousing.co.uk
0845 077 0027
Sanctuary North sanctuary-housing.co.uk
0800 131 3348
Stonewater stonewater.org
01202 319 119
Wakefield and District Housing wdh.co.uk
0345 850 7507
Your Housing Group yhghomes.co.uk
0845 163 5008
NORTH EAST
Accent Group accentgroup.org
0345 678 0555
Bernicia bernicia.com
0344 800 3800
Castles and Coasts

castlesandcoasts.co.uk


0800 085 1171
Guinness Partnership (Northern Counties) guinnesspartnership.com
0303 123 1890

Home Group homegroup.org.uk
0345 141 1663
Karbon Homes
karbonhomes.co.uk








0808 164 0111


Places for People placesforpeople.co.uk
01772 667 002
Sanctuary North sanctuary-housing.co.uk
0800 131 3348
Thirteen thirteengroup.co.uk 0300 111 1000



1 issue £3.95 (Free P&P)








USEFUL CONTACTS First Time Buyer June/July 2023 133
HOMEBUYING PROVIDERS – OFFERING NEW BUILD SCHEMES, INCLUDING SHARED OWNERSHIP AND RENT TO BUY PROPERTIES
P&P)
issues
P&P) SUBSCRIPTION OFFER! Four issues for just £14 Please call our subscription team on 020 3874 1649
4 issues £14 (Free
6
£21 (Free
20 QUESTIONS Esaiyas Mollallegn With
What room at home is your favourite?
I would probably say the kitchen/dining room is my favourite room. One of the benefits of occasionally working from home is that every now and then, we can all eat dinner as a family! Those conversations and memories that we share together are priceless.
What’s your favourite gadget or technology at home?
I was fortunate to be bought a PS5 for Christmas a few years ago. I never really get a chance to use it as a console but we do use it as a media hub, so it’s become very important to the whole family!
What colour do you think everyone should have in their home?
Definitely include a shade of blue, it has always been my favourite colour! Even though I am a Liverpool fan...
Which three people would you invite over for a housewarming party if you could have any guests?
This is tough. I won’t be serious as I wouldn’t be able to decide, but from a more light-hearted perspective, Jurgen Klopp, Michael Jordan and Denzel Washington. What more could you want! I think I could sell tickets for a lot of money if those three were guests.
What’s your favourite memory from your childhood home?
Watching Only Fools and Horses with my family most Christmases, or sitting together with some of my brothers listening to the football on Radio 5 Live on Saturday afternoons.
What is your favourite song and why?
I am one of the least musical people in the world, but one song that sticks with me is Lionel Richie’s My Destiny, as it reminds me of my wife whenever I listen to it.
Would you rather have a garden or a balcony?
Garden. I’ve got three kids, I need the space for peace of mind!
Do you prefer modern homes or period properties?
Another tough call. I think I would probably sway towards modern properties, though I’ve always wanted to have a log fire!
Would you rather have a library room or media room at home?
Media room, I don’t have the time to read at the moment. My answer will probably change as my girls grow up!
Would you prefer a luxurious bathtub or a sumptuous shower?
Shower! I only have a bath if I’ve hurt myself playing football.
Would you rather live in the bustling city or in the country?
City every time – you have everything at your fingertips. It’s great!
Recently at SO Resi we’ve been arranging team meals at different restaurants from different cultures/countries. There are so many
With over 14 years of experience in the property sector, Esaiyas Mollallegn is a property marketing specialist. As Head of Marketing at SO Resi (Metropolitan Thames Valley), Esaiyas and his team play a pivotal role in producing and implementing marketing strategies for the company’s sales programme, ensuring bespoke strategies are tailored to each development to drive effective lead generation and communicate clearly about each product offering

choices as London is very diverse! You couldn’t do that in the country. If you were buying a property overseas, in what country would you buy a home?
Canada. I love the outdoors and from childhood I’ve always loved the thought of living in Canada and exploring its national parks. Would you rather have a bigger property or a better location? Bigger property every time. I’m from a large family with seven siblings, so space is everything. What is one thing you couldn’t live without at home?
From a superficial perspective, a kettle!
What’s your favourite way to unwind at home after work?
Any form of exercise is the best way to unwind after a long day at work, but football is always the best!
What’s your favourite thing about your home?
We live in a relatively standard three bedroom home, so it has to be the garden! It’s so low maintenance, which is lucky because I don't have green fingers and so the less I need to do the better. At the moment I only need to mow the grass every now and then.
Where did you buy your first home?
My first home was a shared ownership maisonette in Feltham. It was a brilliant start for my wife and I. We wouldn’t have been able to get on the property ladder without shared ownership. What advice would you give a first time buyer?
Buying a property is challenging, and isn’t getting easier. My best advice would be to take some time and really do the research. Once you know how much you can afford to spend, then you can start to assess how feasible the options are before you. Nobody is a better judge of what you need than you, but seeking the right advice from experts will be critical in making the right decision. Mortgage advisers and affordable housing providers are here to help, so speak to them for advice. When I purchased my first home, I was always thinking and planning for the future – whether to staircase to 100%, and if so, how and when could I realistically do that. Researching, planning ahead and seeking advice doesn’t mean that the options available are necessarily straightforward, but it will crystallise what your genuine options are and will put you in the strongest position possible to achieve your next steps.
What are your views on shared ownership?
I’m incredibly passionate about shared ownership! If it wasn’t for the scheme, I wouldn’t have ever been able to buy a property. Given the recent Government changes to the product, I think that shared ownership is now more attractive than ever before. It is a real, legitimate, route into homeownership for first time buyers, particularly in the world of escalating mortgage rates that we now live in, and given that Help to Buy has come to an end. It will not be right for everyone, but it has changed countless lives including my own.
What are your views on the housing market at the moment?
Increases in mortgage rates will make affordability a key issue in 2023. In addition, the landlord exodus, with the rental market struggling to keep up with regulation and tax changes, will result in an imbalance in supply, and rents increasing at significant rates.
soresi.co.uk
20 QUESTIONS 134 First Time Buyer June/July 2023













































 Ella Stewart
Ella Stewart

Rowe Gardens Catcliffe, Rotherham
Rowe Gardens Catcliffe, Rotherham






















































































































































































































































































































































































































































































































































































































 Sarah Coles, Senior Personal Finance Analyst, Hargreaves Lansdown
Sarah Coles, Senior Personal Finance Analyst, Hargreaves Lansdown





















































 Drew Broadhurst, Manchester
Drew Broadhurst, Manchester








 Andrew Mannion
Andrew Mannion
































































































































